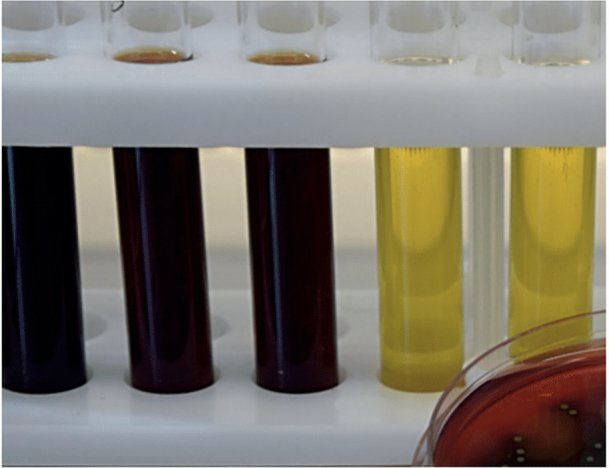
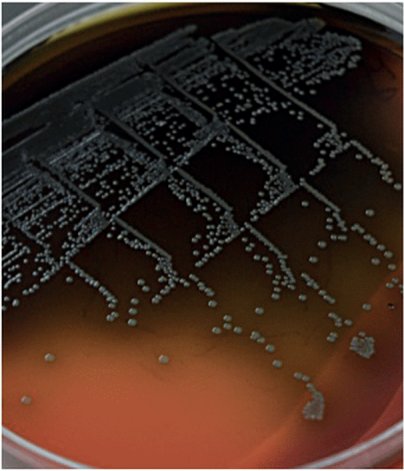
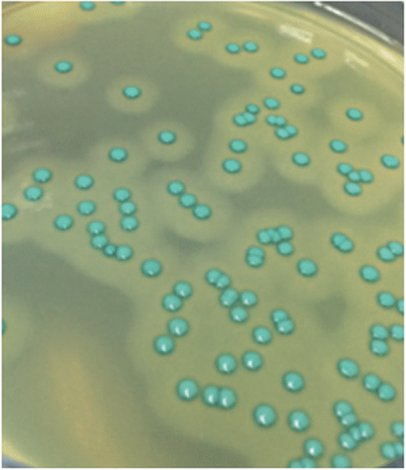
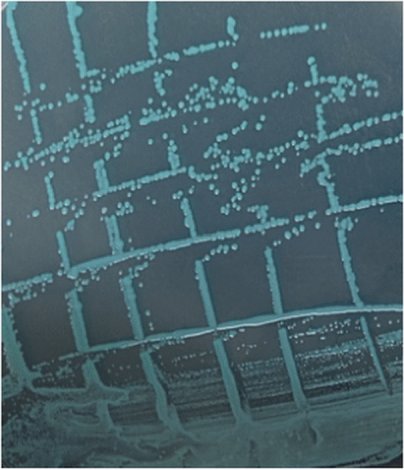

СПРАВКА
Источник публикации
М.: Федеральный центр гигиены и эпидемиологии Роспотребнадзора, 2023
Примечание к документу
Документ введен в действие с 01.12.2023.
Взамен МУК 4.2.1018-01; п. 1.3 - 1.5 гл. 1, п. 2.1 - 2.10 гл. 2, приложений 1 - 10 МУК 4.2.1884-04; в части положений, регламентирующих санитарно-бактериологический анализ прибрежных вод морей в местах водопользования населения, включая гл. 6 - 11, приложения 2 - 6 МУК 4.2.2959-11; п. 4.5 гл. 4, п. 5.11 гл. 5, приложений 6 - 8 МУ 2.1.5.800-99.
Название документа
"МУК 4.2.3963-23. 4.2. Методы контроля. Биологические и микробиологические факторы. Бактериологические методы исследования воды. Методические указания"
(утв. Роспотребнадзором 01.09.2023)
"МУК 4.2.3963-23. 4.2. Методы контроля. Биологические и микробиологические факторы. Бактериологические методы исследования воды. Методические указания"
(утв. Роспотребнадзором 01.09.2023)
Содержание
Руководитель Федеральной службы
по надзору в сфере защиты прав
потребителей и благополучия человека,
Главный государственный санитарный врач
Российской Федерации
А.Ю.ПОПОВА
1 сентября 2023 года
4.2. МЕТОДЫ КОНТРОЛЯ.
БИОЛОГИЧЕСКИЕ И МИКРОБИОЛОГИЧЕСКИЕ ФАКТОРЫ
БАКТЕРИОЛОГИЧЕСКИЕ МЕТОДЫ ИССЛЕДОВАНИЯ ВОДЫ
МЕТОДИЧЕСКИЕ УКАЗАНИЯ
МУК 4.2.3963-23
Дата введения
1 декабря 2023 года
1. Разработаны ФБУН "Федеральный научный центр гигиены им. Ф.Ф. Эрисмана" Роспотребнадзора (С.В. Кузьмин, Г.М. Трухина, О.О. Синицына, А.Л. Мишина, О.М. Микаилова, Н.А. Борисова); ФГБУ "Центр стратегического планирования и управления медико-биологическими рисками" ФМБА России (С.М. Юдин, Ю.А. Рахманин, В.Г. Слободян, Т.З. Артемова, А.В. Загайнова, Р.Б. Такташова, М.А. Сухина); ФБУН "Ростовский научно-исследовательский институт микробиологии и паразитологии" Роспотребнадзора (П.В. Журавлев, М.А. Морозова, С.А. Колпаков, Е.П. Колпакова); ФГБУ "Национальный исследовательский центр эпидемиологии и микробиологии имени Н.Ф. Гамалеи" Минздрава России (Г.С. Прохоров, И.С. Тартаковский, Н.В. Шеенков); АО "Главный контрольный испытательный центр питьевой воды" (Ю.Н. Гончар, Л.Н. Крылова); ФБУН "Государственный научный центр прикладной микробиологии и биотехнологии" (И.А. Дятлов, М.В. Храмов, Л.В. Домотенко, О.В. Полосенко); ФБУЗ "Центр гигиены и эпидемиологии в городе Москве" (Н.В. Кузь, Н.Я. Салова, Л.А. Лунина); ФБУЗ "Центр гигиены и эпидемиологии в Московской области" (М.В. Калькаев, О.А. Кузнецова); ФБУЗ "Центр гигиены и эпидемиологии в Краснодарском крае" (Л.И. Щербина, Е.П. Лаврик); ФБУЗ "Центр гигиены и эпидемиологии в Липецкой области" (С.И. Савельев, Н.В. Зубчонок, Е.С. Ясная, В.В. Коротков); ФБУЗ "Центр гигиены и эпидемиологии в Вологодской области" (Л.В. Славнухина, Е.А. Алексеева).
2. Утверждены руководителем Федеральной службы по надзору в сфере защиты прав потребителей и благополучия человека, Главным государственным санитарным врачом Российской Федерации А.Ю. Поповой 1 сентября 2023 г.
3. МУК 4.2.3963-23 введены взамен МУК 4.2.1018-01 "Методы санитарно-микробиологического исследования питьевой воды", с изменениями, внесенными МУК 4.2.2794-10 "Санитарно-микробиологический анализ питьевой воды. Изменения 1 к МУК 4.2.1018-01", МУК 4.2.3690-21 "Изменения N 2 в МУК 4.2.1018-01 "Санитарно-микробиологический анализ питьевой воды"; пунктов 1.3 - 1.5 главы 1, пунктов 2.1 - 2.10 главы 2, приложений 1 - 10 МУК 4.2.1884-04 "Санитарно-микробиологический и санитарно-паразитологический анализ воды поверхностных водных объектов, с изменениями, внесенными МУК 4.2.2793-10 "Санитарно-микробиологический и санитарно-паразитологический анализ воды поверхностных водных объектов. Изменения 1 к МУК 4.2.1884-04", МУК 4.2.3691-21 "Изменения N 2 в МУК 4.2.1884-04 "Санитарно-микробиологический и санитарно-паразитологический анализ воды поверхностных водных объектов", пунктами 2 - 6 МУК 4.2.3721-21 "Изменения N 3 в МУК 4.2.1884-04 "Санитарно-микробиологический и санитарно-паразитологический анализ воды поверхностных водных объектов"; в части положений, регламентирующих санитарно-бактериологический анализ прибрежных вод морей в местах водопользования населения, включая главы 6 - 11, приложения 2 - 6 МУК 4.2.2959-11 "Методы санитарно-микробиологического и санитарно-паразитологического анализа прибрежных вод морей в местах водопользования населения", с изменениями, внесенными МУК 4.2.3689-21 "Изменения N 1 в МУК 4.2.2959-11 "Методы санитарно-микробиологического и санитарно-паразитологического анализа прибрежных вод морей в местах водопользования населения"; пункта 4.5 главы 4, пункта 5.11 главы 5, приложений 6 - 8 МУ 2.1.5.800-99 "Организация Госсанэпиднадзора за обеззараживанием сточных вод", с изменениями, внесенными МУ 2.1.5.3692-21 "Изменения N 1 в МУ 2.1.5.800-99 "Организация Госсанэпиднадзора за обеззараживанием сточных вод".
Настоящие методические указания (далее - МУК) устанавливают методы и порядок проведения бактериологических исследований всех типов воды - воды систем централизованного питьевого, в т.ч. горячего, водоснабжения, систем нецентрализованного питьевого водоснабжения, питьевой воды из емкостей для ее хранения, упакованной питьевой воды, включая природную минеральную, воды поверхностных водных объектов и их ледяного покрова, морской воды, обеззараженных сточных вод, допустимых к сбросу в поверхностные водные объекты, воды плавательных бассейнов, аквапарков, природных и сточных вод систем технического водоснабжения в соответствии с законодательством Российской Федерации <1>.
--------------------------------
<1> Глава III СанПиН 1.2.3685-21 "Гигиенические нормативы и требования к обеспечению безопасности и (или) безвредности для человека факторов среды обитания", утвержденные постановлением Главного государственного санитарного врача Российской Федерации от 28.01.2021 N 2 (зарегистрировано Минюстом России 29.01.2021, регистрационный N 62296), с изменениями, внесенными постановлением Главного государственного санитарного врача Российской Федерации от 30.12.2022 N 24 (зарегистрировано Минюстом России 09.03.2023, регистрационный N 72558) (далее - СанПиН 1.2.3685-21); технический регламент Евразийского экономического союза "О безопасности упакованной питьевой воды, включая природную минеральную воду" (ТР ЕАЭС 044/2017), утвержденный Решением Совета Евразийской экономической комиссии от 23.06.2017 N 45, с изменениями, внесенными Решением Совета Евразийской экономической комиссии от 05.10.2021 N 97.
1.2. МУК носят рекомендательный характер.
2.1. Отбор, хранение и транспортировка проб производится в соответствии с методическими документами <2>.
--------------------------------
<2> ГОСТ Р 56237 (ИСО 5667-5) "Вода питьевая. Отбор проб на станциях водоподготовки и в трубопроводных распределительных системах", введенный приказом Росстандарта от 17.11.2014 N 1628-ст; ГОСТ Р 59024 "Вода. Общие требования к отбору проб", введенный приказом Росстандарта от 10.09.2020 N 640-ст; ГОСТ 31942 (ИСО 19458) "Отбор проб для микробиологического анализа", введенный приказом Росстандарта от 12.12.2012 N 1903-ст.
2.2. Вместимость бутыли для отбора проб должна соответствовать объему воды, необходимому для определения всех требуемых микробиологических показателей. Допускается возможность отбора и доставки одной пробы для микробиологического исследования в нескольких стерильных емкостях:
- для определения индикаторных бактерий - не менее 500 см3;
- индикаторных и патогенных микроорганизмов (сальмонелл) - не менее 1500 см3;
- для определения Legionella spp. - не менее 1000 см3;
- для определения индикаторных и Pseudomonas aeruginosa в бассейнах - не менее 1000 см3.
2.3. Отбор проб ледяного покрова поверхностных водных объектов.
Заготовка проб ледяного покрова на водоемах начинается при достижении толщины льда не менее 20 - 25 см. Отбор проб льда для микробиологических исследований выполняют на ровном участке, очищенном от поверхностного снежного покрова (стерильными металлическими скребками или совком). Поверхность льда размечают на ровные блоки или прямоугольники специальными приспособлениями (пешни или иные инструменты). Образцы льда нарезают ручным кольцевым буром или бензопилой (допускаются иные устройства). После отбора измеряют длину полученной пробы льда. Пробу помещают в тройной стерильный полиэтиленовый мешок или цилиндрический стерильный контейнер с винтовой крышкой, изготовленный из полимерного материала (допускается применять металлический контейнер). Емкости с отобранными пробами маркируются. Результаты отбора проб заносят в акт отбора проб или другую сопроводительную документацию.
2.4. Хранение и транспортирование проб ледяного покрова поверхностных водных объектов.
2.4.1. Хранение и транспортирование проб льда осуществляют при минусовой температуре, исключающей таяние проб (ниже 0 °C). Для хранения и транспортирования отобранных и упакованных образцов проб используют специальные контейнеры и транспортировочные ящики с откидной крышкой и внутренним покрытием из полимерного материала, обеспечивающие сохранность проб и предотвращающие их загрязнение.
2.4.2. После доставки проб льда в лабораторию удаляют поверхностный слой льда стерильными приспособлениями и помещают в стерильную лабораторную емкость. Перед анализом производят протаивание пробы льда при комнатной температуре с целью получения талой воды. Объем микробиологических исследований талой воды или талой воды, полученной после ледовых станций, зависит от технологии водоподготовки и доставки к потребителю и проводится по микробиологическим показателям безопасности питьевой воды в соответствии с санитарно-эпидемиологическими требованиями <3>.
--------------------------------
ИС МЕГАНОРМ: примечание. В официальном тексте документа, видимо, допущена опечатка: имеются в виду СанПиН 1.2.3685-21, а не СанПиН 2.1.3685-21. |
<3> Таблица 3.5 главы III СанПиН 2.1.3685-21.
питательные среды для бактериологических исследований
3.1. Для надлежащего осуществления лабораторной деятельности в области санитарно-бактериологических исследований микробиологическая лаборатория обеспечивается средствами измерений, испытательным и вспомогательным оборудованием, контрольными (референтными) штаммами микроорганизмов, стандартными образцами, питательными средами, наборами и тест-системами, реактивами, расходными материалами, разрешенными к применению на территории Российской Федерации.
3.2. Рекомендуемый перечень оборудования, расходных материалов, реактивов для проведения бактериологических исследований изложен в приложении 1 к настоящим МУК, питательные среды и тест-культуры - в приложении 2 к настоящим МУК.
4.1. В качестве контрольных (референтных) штаммов используют тест-штаммы из официально признанных коллекций микроорганизмов с изученными фенотипическими характеристиками. Лаборатория должна иметь разрешительные документы (санитарно-эпидемиологическое заключение и лицензию) на выполнение работ с патогенными биологическими агентами III - IV групп патогенности.
4.2. Ведение и хранение штаммов микроорганизмов осуществляется в соответствии с санитарно-эпидемиологическими требованиями <4>, а также методическими документами <5>.
--------------------------------
<4> СанПиН 3.3686-21 "Санитарно-эпидемиологические требования по профилактике инфекционных болезней", утвержденные постановлением Главного государственного санитарного врача Российской Федерации от 28.01.2021 N 4 (зарегистрировано Минюстом России 15.02.2021, регистрационный N 62500), с изменениями, внесенными постановлениями Главного государственного санитарного врача Российской Федерации от 11.02.2022 N 5 (зарегистрировано Минюстом России 01.03.2022, регистрационный N 67587), от 25.05.2022 N 16 (зарегистрировано Минюстом России 21.06.2022, регистрационный N 68934).
<5> МУ 2.1.4.1057-01 "Организация внутреннего контроля качества санитарно-микробиологических исследований воды", утвержденные Главным государственным санитарным врачом Российской Федерации, Первым заместителем Министра здравоохранения Российской Федерации 06.07.2001, с изменениями, внесенными МУ 2.1.4.2899-11 "Организация внутреннего контроля качества санитарно-микробиологических исследований воды. Изменение 1 к МУ 2.1.4.1057-01", утвержденными руководителем Федеральной службы по надзору в сфере защиты прав потребителей и благополучия человека, Главным государственным санитарным врачом Российской Федерации 12.07.2011; МУК 4.2.2316-08 "Методы контроля бактериологических питательных сред", утвержденные руководителем Федеральной службы по надзору в сфере защиты прав потребителей и благополучия человека, Главным государственным санитарным врачом Российской Федерации 18.01.2008; ГОСТ ISO 11133 "Микробиология пищевых продуктов, кормов для животных и воды. Приготовление, производство, хранение и определение рабочих характеристик питательных сред", введенный приказом Росстандарта от 07.11.2016 N 1605-ст; ГОСТ Р 70152 "Методы внутреннего лабораторного контроля качества проведения микробиологических и паразитологических исследований", введенный приказом Росстандарта от 17.06.2022 N 483-ст.
4.3. Контрольные (референтные) штаммы используются для проведения исследований, контроля питательных сред и постановки положительных и отрицательных контролей. Контрольный колифаг MS-2, штаммы E. coli K 12F + StrR, Escherichia coli M17, Staphylococcus aureus и один из штаммов: Pseudomonas aeruginosa или Pseudomonas fluorescens используются для проведения исследований и постановки положительных и отрицательных контролей.
5.1. Общее микробное число (далее - ОМЧ) отражает общее количество мезофильных аэробных и факультативно-анаэробных микроорганизмов, способных образовывать колонии на питательном агаре при температуре (37 +/- 1) °C в течение (24 +/- 2) ч, видимые при увеличении в 2 раза.
5.2. Посевы для определения ОМЧ проводят в 2 повторностях.
С флаконов с пробой воды снимают пробку, горлышки фламбируют, после чего воду тщательно перемешивают с помощью стерильной пипетки перед посевом или для приготовления разведения.
Стерильные чашки Петри раскладывают на столе и подписывают на дне номер пробы, дату посева и объем посеянной воды.
С соблюдением правил асептики отбирают из пробы и вносят в 2 стерильные чашки по 1 см3 воды, слегка приоткрывая крышку.
При исследовании воды неизвестного качества возможно проведение дополнительного посева по 1 см3 из десятикратного разведения.
Для приготовления разведений анализируемой воды используют стерильные растворы для разведения: 0,9% солевой (физиологический) раствор, пептонный раствор, пептонно-солевой раствор, разлитые в пробирки по 9 см3.
После внесения исследуемой воды в чашки Петри ее заливают тонким слоем 8 - 12 см3 расплавленного питательного агара (температура 45 - 50 °C), предварительно фламбируя края емкости, в которой он содержался.
Воду быстро смешивают с агаром, осторожно наклоняя или вращая чашку по поверхности стола, исключая образования пузырьков воздуха и не покрытых агаром частей дна чашки, а также попадания агара на края и крышку чашки. После этого чашки оставляют на горизонтальной поверхности до застывания питательного агара на 20 мин.
После застывания агара чашки переворачивают вверх дном, помещают в термостат не более чем по 4 чашки в стопке и инкубируют при температуре (37 +/- 1) °C в течение (24 +/- 2) ч.
5.3. Учет результатов.
После инкубации подсчитывают все выросшие на чашках колонии, видимые при увеличении в 2 раза.
Учету подлежат чашки, на которых наблюдается рост отдельных колоний.
Чашки с ползучим ростом бактерий, распространившихся на всю поверхность чашки или на значительные зоны, маскирующие рост других колоний, исключают.
Подсчитывают число колоний, выросших на двух чашках, вычисляют среднеарифметическое значение, делят его на засеянный объем воды.
Результат выражают числом колониеобразующих единиц (далее - КОЕ) в 1 см3 исследуемой воды, округляя его до целых чисел в сторону увеличения.
Допускается представлять результат на основании подсчета колоний на одной чашке в случаях, если на второй чашке рост расплывчатых колоний распространился на всю поверхность.
Если рост колоний на чашках отсутствует, в документе о результатах проведенного исследования (например, протокол, отчет) записывают: "ОМЧ 0 в 1 см3".
Если на чашке выросло более 300 колоний в протоколе указывают "ОМЧ более 300 КОЕ/см3".
5.4. Определение общего микробного числа с использованием мембранных фильтров.
5.4.1. Сущность метода заключается в концентрировании микроорганизмов из определенного объема анализируемой воды на мембранном фильтре, выращивании их при (37 +/- 1) °C в течение (24 +/- 2) ч на питательном агаре и подсчете количества микроорганизмов в 1 см3 воды.
5.4.2. Фильтрацию выполняют с использованием прибора для фильтрования воды (приложение 1 к настоящим МУК).
5.4.3. Затем мембранный фильтр стерильным пинцетом перекладывают на чашку Петри с питательным агаром. Переворачивают чашку вверх дном и инкубируют посевы при (37 +/- 1) °C в течение (24 +/- 2) ч.
5.4.4. Учитывают общее число выросших колоний с последующим пересчетом на 1 см3 анализируемой воды. В документе о результатах проведенного исследования (например, протокол, отчет) записывают: "ОМЧ X КОЕ/см3".
5.5. Определение ОМЧ с использованием готовых питательных сред на подложке.
5.5.1. Определение ОМЧ с использованием питательной среды на подложке проводят в соответствии с инструкцией производителя.
При инкубировании допускается размещать питательные среды на подложке стопкой по 20 штук.
5.5.2. Количество колоний подсчитывают визуально или автоматически с помощью ридера.
Полученный результат делят на засеянный объем воды и получают количество КОЕ в 1,0 см3.
5.6. Спиральный метод автоматизированного посева проб проводится в соответствии с инструкцией к прибору.
5.7. Возможен автоматизированный подсчет колоний на плотной питательной среде с использованием автоматических и ручных счетчиков колоний.
6.1. Обобщенные колиформные бактерии (далее - ОКБ): представители семейства Enterobacteriaceae - грамотрицательные, оксидазоотрицательные палочки, не образующие спор, способные расти на дифференциальных лактозных средах при температуре (37 +/- 1) °C в течение (21 +/- 3) ч, лактозоположительные и лактозоотрицательные бактерии.
6.2. ОКБ - чувствительный индикаторный показатель фекального загрязнения воды возбудителями бактериальных кишечных инфекций.
6.3. Определение обобщенных колиформных бактерий методом мембранной фильтрации.
6.3.1. Посев воды для исследования.
При анализе питьевой воды системы централизованного водоснабжения из поверхностных источников, а также воды подземных источников водоснабжения анализируют 300 см3 воды: 2 объема по 150 см3 или 3 объема по 100 см3 или 4 объема по 10, 40, 100, 150 см3, если вода неизвестного качества. При получении стабильных отрицательных результатов допустима фильтрация 300 см3 воды через один фильтр.
При исследовании питьевой воды нецентрализованного водоснабжения, пропускают через мембранные фильтры объемы воды 1 см3, 10 см3 и 100 см3, размещая фильтры на чашках Петри с дифференциальной средой. При фильтровании воды неизвестного качества увеличивают количество фильтруемых объемов для получения изолированных колоний (например, выполняя посев по 1 см3 из 10-1 и 10-2 десятикратных разведений).
При исследовании воды плавательных бассейнов и аквапарков анализируют 2 объема по 150 см3 или 3 объема по 100 см3 или 4 объема по 10, 40, 100, 150 см3.
При исследовании воды морей в местах водозаборов для хозяйственно-питьевого водопользования с последующим опреснением и плавательных бассейнов с морской водой фильтруют 100, 10 и 1 см3; в местах рекреации - 50, 10, 1 см3 и последующие разведения с учетом сезонности; в местах изучения влияния выпусков сточных вод - фильтруют 10 и 1 см3, а последующие десятикратные разведения (количество разведений проводят с учетом сезонности и мутности воды) исследуют методом прямого посева по 0,1 см3.
Фильтрацию выполняют с использованием прибора для фильтрования воды (приложение 1 к настоящим МУК).
После фильтрования анализируемой воды мембранные фильтры размещают посевом вверх на одну из дифференциально-диагностических или селективных сред, разлитых в чашки Петри, добиваясь полного прилегания фильтров к среде без пузырьков воздуха и без соприкосновения фильтров. Для посева используют среду Эндо (допускается использовать фуксин-сульфитную среду Эндо, среду Эндо с розоловой кислотой), лактозный Трифенилтетразолиум хлорид (далее - ТТХ) агар с тергитолом 7, хромогенные среды (приложение 2 к настоящим МУК).
Чашки с посевами помещают в термостат дном вверх и инкубируют при температуре (37 +/- 1) °C в течение (21 +/- 3) ч.
6.3.2. Идентификация обобщенных колиформных бактерий.
Для учета выбирают фильтры, на которых выросли изолированные оксидазоотрицательные, грамотрицательные типичные колонии бактерий (на среде Эндо как лактозопозитивные, так и лактозонегативные). Для повышения точности исследования учет ведут не менее чем на двух фильтрах с числом типичных для колиформных бактерий колоний не более 50.
Допустимо вести учет по 1 фильтру или на фильтрах с более густым ростом, если колонии можно сосчитать.
На среде Эндо или фуксин-сульфитной среде Эндо, Эндо с розоловой кислотой подсчитывают оксидазоотрицательные темно-красные, красные, с металлическим блеском или без него, слизистые с темно-малиновым центром или другие подобного типа колонии с отпечатком на обратной стороне фильтра (ферментирующие лактозу), а также розовые колонии различного оттенка с темным центром и без него (не ферментирующие лактозу).
На среде Лактозный ТТХ агар с тергитолом 7 подсчитывают типичные колонии с желто-оранжевой, кирпично-красной окраской, иногда с ржаво-окрашенным центром, образующим желтую окраску в среде под мембраной.
На хромогенном агаре для определения колиформных бактерий и E. coli учитывают колонии сине-фиолетового, красного и красно-коричневого цвета с окрашенным ореолом вокруг колонии.
Выполняют оксидазный тест (приложения 11, 12 к настоящим МУК).
Допустимо использование коммерческих оксидазных тестов промышленного производства, разрешенных к применению в установленном порядке.
В случае отсутствия оксидазы у лактозоположительных колоний, их учитывают как ОКБ.
Проводят подтверждение лактозоотрицательных, грамотрицательных, оксидазоотрицательных колоний. Для этого по 3 - 4 колонии каждого типа пересевают в пробирки с полужидкой средой Гисса с глюкозой для подтверждения их принадлежности к обобщенным колиформным бактериям. Посевы инкубируют при температуре (37 +/- 1) °C. Первичный учет на подтверждающих полужидких средах возможен через 4 - 6 ч. При обнаружении кислоты и газа дают положительный ответ. При отсутствии кислоты и газа или при наличии только кислоты пробирки с посевами оставляют для окончательного учета через (21 +/- 3) ч. При обнаружении кислоты и газа дают положительный ответ. После чего анализ воды заканчивают.
Число типичных лактозоположительных колоний с отрицательным оксидазным тестом суммируют с числом лактозоотрицательных, грамотрицательных, оксидазоотрицательных колоний, ферментирующих глюкозу до кислоты и газа, сумму делят на профильтрованный объем воды. Подсчет ведут только на тех фильтрах, где обнаружены изолированные колонии. Результат подсчета на каждом фильтре суммируют и определяют число КОЕ в нормируемом объеме воды по формуле (1):
где: X - число КОЕ в нормируемом объеме воды;
A - сумма подтвержденных колоний в исследованном объеме;
H - нормируемый объем;
V - объем воды, профильтрованный через фильтры, на которых проводили учет.
Если при выборочной проверке колоний одного типа получены неодинаковые результаты, то вычисляют число колоний среди этого типа по формуле (2):
где: Y - число подтвержденных бактерий одного типа;
d - общее число колоний этого типа;
c - число колоний с положительным результатом;
b - число проверенных из них.
При получении дробного числа результат в протоколе исследования записывают либо дробным числом, либо полученное число округляется в большую величину. Например:
- 1,7 КОЕ ОКБ в 100 см3 округлить до 2 КОЕ;
- 0,3 КОЕ ОКБ в 100 см3 округлить до 1 КОЕ.
В документе о результатах проведенного исследования (например, протокол, отчет) записывают: "Обобщенные колиформные бактерии X КОЕ/100 см3".
Пример 1. При посеве 3 фильтров по 100 см3 на одном выросло две колонии в 100 см3, на остальных фильтрах нет роста. Число обобщенных колиформных бактерий при этом: (2 x 100) : 300 = 0,7 КОЕ ОКБ в 100 см3.
Пример 2. При посеве 10, 40, 100, 150 см3 на фильтрах с профильтрованным объемом 40 см3 выросло 4 изолированных колонии, с профильтрованным объемом 100 см3 - 3 ОКБ. Фильтры с объемом 10 см3 и 150 см3 заросли и учету не подлежат. Суммируют общее число колоний ОКБ на тех фильтрах, где получены изолированные колонии и пересчитывают на объем 100 см3, (4 + 3) x 100 : (40 + 100) = 5 КОЕ в 100 см3.
В документе о результатах проведенного исследования (например, протокол, отчет) записывают: "Обобщенные колиформные бактерии в 100 см3 не обнаружены" если:
- при отсутствии роста каких-либо колоний на фильтрах;
- при наличии только пленчатых, губчатых, с неровной поверхностью и краями, плесневых и других нехарактерных для кишечных палочек колоний;
- при наличии оксидазы у всех бактерий;
- при отсутствии кислоты и газа на подтверждающей среде с глюкозой у лактозоотрицательных грамотрицательных оксидазоотрицательных бактерий.
В случаях сплошного роста на всех фильтрах и невозможности учета результатов анализа в документе о результатах проведенного исследования (например, протокол, отчет) записывают: "Обобщенные колиформные бактерии в 100 см3 обнаружены", анализ повторяют.
6.4. Определение обобщенных колиформных бактерий ускоренным методом с использованием хромогенных сред (например, ChromocultColiformAgar, аналог тест-систем IDEXX).
Метод позволяет определить содержание ОКБ в пробе воды в течение (21 +/- 3) ч без дальнейшей идентификации выросших колоний. Определение ОКБ в пробе анализируемой воды проводят с использованием метода мембранной фильтрации, применяя одну из хромогенных сред, например, хромокультколиформ агар (приложение 2 к настоящим МУК). Инкубацию посевов проводят при температуре (37 +/- 1) °C.
Наличие в хромогенной среде для определения колиформных бактерий и E. coli пептонов и MOPS (3-[N-морфолино]пропансульфоновая кислота)-буфера обеспечивает быстрый рост обобщенных колиформных бактерий и эффективную трансформацию хромогенных субстратов, соли желчных кислот и пропионовой кислоты в значительной степени ингибируют рост грамположительных бактерий и сопутствующей грамотрицательной микрофлоры. Хромогенный субстрат 6-хлор-3-индолил- -D-галактопиранозид (Salmon-GAL) расщепляется ферментом
-D-галактопиранозид (Salmon-GAL) расщепляется ферментом  -галактозидазой (характерный фермент колиформных бактерий), приводя к окрашиванию обобщенных колиформных колоний в розовый (до красного) цвет.
-галактозидазой (характерный фермент колиформных бактерий), приводя к окрашиванию обобщенных колиформных колоний в розовый (до красного) цвет.
6.5. Метод определения обобщенных колиформных бактерий с готовыми питательными средами на подложке.
Готовые питательные среды на подложке для определения обобщенных колиформных бактерий готовят к анализу в соответствии с инструкцией производителя.
Сначала проводят фильтрацию проб воды с помощью мембранных фильтров (приложение 3 к настоящим МУК).
После фильтрации фильтры стерильным пинцетом помещают на подложку.
Посевы инкубируют в термостате при температуре (37 +/- 1) °C в течение (21 +/- 3) ч.
Обобщенные колиформные бактерии определяют по следующим признакам: характерному цвету колоний, изменению цвета среды вокруг колоний. Наличие газообразования под пленкой петрифильма также подтверждает присутствие в пробе воды колиформных бактерий.
Расчет и оформление результатов проводят по формуле (2) в соответствии с п. 6.3.3.
6.6. Метод определения обобщенных колиформных бактерий с использованием хромогенной среды на колиформы и E. coli, наличие/отсутствие в 100 см3 воды (качественный метод).
Анализ с использованием данной среды (хромогенная питательная среда для определения наличия/отсутствия колиформных бактерий и E. coli в 100 см3 воды) проводят в соответствии с инструкцией производителя (приложение 15 к настоящим МУК).
Пробы воды хранят не более 24 ч в холодильнике при температуре от 2 °C до 8 °C, при этом посев начинают после нагревания пробы до комнатной температуры, но не позднее чем через 6 ч.
В стерильный прозрачный флакон, вместимостью 250 см3 с завинчивающейся крышкой, помещают 100 см3 пробы воды.
Вынимают один пакет из упаковки, слегка постучав, чтобы гранулы среды оказались на дне пакета, надламывают его верхнюю часть, не дотрагиваясь до открытой части пакета, чтобы избежать внешнего загрязнения питательной среды.
Содержимое пакета добавляют во флакон к пробе воды. Закрывают флакон и перемешивают до полного растворения гранулированной среды.
Посевы инкубируют в течение (21 +/- 3) ч при температуре (37 +/- 1) °C.
После инкубации посевов проводят учет результатов:
- обобщенные колиформные бактерии отсутствуют, если цвет среды не изменился или отмечено помутнение без изменения цвета среды;
- бактерии обнаружены, если среда приобрела зелено-голубой цвет во всем объеме или верхнем слое. При перемешивании цвет среды не должен изменяться.
Изменение цвета среды Readycult Coliforms 100 при определении наличия/отсутствия обобщенных колиформных бактерий и E. coli в 100 см3 воды представлено в приложении 15 к настоящим МУК.
6.7. Определение обобщенных колиформных бактерий титрационным методом.
6.7.1. Выполнение исследования.
Каждый объем воды или ее разведения засевают в накопительную лактозо-пептонную среду в трех или двух повторностях. Анализируемую воду в объеме 100 см3 вносят в 10 см3 концентрированной лактозо-пептонной среды, 10 см3 анализируемой воды вносят в пробирки с 1 см3 концентрированной лактозо-пептонной среды, 1 см3 пробы воды и 1 см3 из разведений вносят в пробирки с 10 см3 среды нормальной концентрации. Посевы инкубируют при температуре (37 +/- 1) °C в течение (21 +/- 3) ч.
Из посевов в среду накопления, где отмечено помутнение, образование кислоты и газа или только помутнение, производят высев петлей на сектора среды Эндоили на фуксин-сульфитную среду Эндо с таким расчетом, чтобы получить изолированные колонии. Посевы на среде Эндо инкубируют при температуре (37 +/- 1) °C в течение (21 +/- 3) ч.
Результат считается положительным при наличии в среде накопления помутнения и газообразования, а при высеве на подтверждающую среду типичных лактозоположительных (темно-красных с металлическим блеском или без него) и лактозоотрицательных (розовых) колоний.
Наличие ОКБ подтверждают:
- если в среде накопления имеет место сомнительная реакция (небольшое газообразование или только помутнение);
- если на среде Эндо или фуксин-сульфитной среде Эндо выросли колонии с недостаточно четкими дифференциальными признаками лактозоположительных и лактозоотрицательных колиформных бактерий. В этом случае проверить наличие отпечатка на среде Эндо после снятия петлей подозрительных колоний, подтвердить принадлежность этих колоний к грамотрицательным бактериям (микроскопированием или тестом Грегерсена), выполнить оксидазный тест и подтвердить способность к газообразованию при посеве изолированных 1 - 2 колоний каждого типа с каждого сектора на полужидкую среду с глюкозой и последующей инкубацией посевов при температуре (37 +/- 1) °C в течение (21 +/- 3) ч.
При отсутствии изолированных колоний проводят рассев на среду Эндо общепринятыми бактериологическими методами.
Отрицательный ответ выдают, если:
- в среде накопления нет признаков роста;
- на секторах среды Эндо нет роста;
- на секторах среды Эндо выросли нехарактерные для колиформных бактерий колонии (прозрачные, с неровными краями, расплывчатые);
- все колонии оказались оксидазоположительными;
- если в подтверждающем тесте на среде с глюкозой не отмечено газообразования.
В документе о результатах проведенного исследования (например, протокол, отчет) записывают: "Обобщенные колиформные бактерии не обнаружены в 100 см3".
6.7.2. Учет результатов.
После определения положительных и отрицательных результатов на наличие ОКБ в исследуемых объемах воды, засеянной в среду накопления и роста на секторах типичных оксидазоотрицательных колоний - темно-красных, красных, с металлическим блеском или без него, а также розовых колоний, при этом в среде накопления установлено газообразование, вычисляют наиболее вероятное число (далее - НВЧ) ОКБ КОЕ в 100 см3 по одной из таблиц приложений 4, 5 и 6 к настоящим МУК. В документе о результатах проведенного исследования (например, протокол, отчет) записывают: "НВЧ обобщенных колиформных бактерий в 100 см3".
В соответствии с гигиеническими нормативами ОКБ определяются в объеме 100 см3. Эта единица измерения 100 см3 условно принята для выражения количественного результата в целях сопоставления данных на международном уровне, а также при исследовании воды различных объектов и при работе разными методами (мембранным или титрационным).
7.1. E. coli - таксономический представитель семейства Enterobacteriaceae - это грамотрицательные, оксидазоотрицательные, не образующие спор палочки, ферментируют лактозу с образованием кислоты и газа в течение (18 - 24) ч при температуре (37 +/- 1) °C и (44 +/- 0,5) °C, способны образовывать индол из триптофана, имеют фермент  -глюкуронидазу.
-глюкуронидазу.
7.2. Значение показателя.
E. coli - индикатор недавнего фекального загрязнения, свидетельствующий о потенциальной эпидемиологической опасности воды и риске возникновения кишечных инфекций.
7.3. Определение бактерий E. coli методом мембранной фильтрации.
Для обнаружения E. coli допускается проведение дополнительного посева объема исследуемой воды на фильтре на дифференциальные лактозные среды с дальнейшей инкубацией посева микроорганизмов при температуре (44 +/- 0,5) °C.
При наличии выросших на мембранных фильтрах характерных темно-красных колоний с металлическим блеском и отпечатком проводят их дальнейшее подтверждение на принадлежность к бактериям E. coli.
Если на мембранном фильтре в течение (21 +/- 3) ч и продолжении инкубации до (44 +/- 4) ч не обнаружен рост колоний или выросли нетипичные колонии, то в журнале испытаний регистрируют сведения об отсутствии E. coli в пробе воды - "E. coli не обнаружена в 100 см3".
Исследуемые объемы пробы питьевой воды фильтруют через мембранные фильтры, удерживающие микроорганизмы. При учете результата на фильтре можно учитывать ОКБ и E. coli.
При испытаниях по стандартному тесту мембранный фильтр помещают на одну селективную лактозную агаризованную среду (например, среда с тергитолом 7, Эндо) и инкубируют посевы при температуре (37 +/- 1) °C в течение (21 +/- 3) ч; при испытаниях по ускоренному тесту мембранный фильтр помещают на агаризованную среду, содержащую казеин трипсиновой ферментации (приложение 1 к настоящим МУК) и проводят инкубацию при температуре (37 +/- 1) °C в течение 4 - 5 ч с последующей инкубацией при температуре (44 +/- 0,5) °C в течение (21 +/- 3) ч на агаризованной среде, содержащей казеин трипсиновой ферментации и соли желчи.
На фильтрах, где выросли изолированные колонии, подсчитывают типичные колонии лактозоположительных бактерий на среде Эндо или фуксин-сульфитной среде Эндо (темно-красные, красные, с металлическим блеском или без него, с отпечатком на обратной стороне фильтра); на среде тергитолом 7 - колонии с желто-оранжевой, кирпично-красной окраской, иногда с ржаво-окрашенным центром, образующие желтую окраску в среде под мембраной (отпечаток). Каждую колонию или часть из случайно выбранных характерных колоний, при росте до 10 - 15 КОЕ или по 3 - 4 колонии каждого подсчитанного типа, подтверждают на принадлежность к E. coli. При исследовании питьевой воды и воды бассейнов для учета выбирают все фильтры, на которых есть рост типичных колоний.
Колонию пересевают в пробирку со средой, содержащей триптофан для определения образования индола и с полужидкой лактозой (среда Гисса с лактозой). Обе пробирки перед посевом должны быть прогреты до температуры 44 - 45 °C. Посевы немедленно переносят в термостат для инкубации при температуре (44 +/- 0,5) °C в течение (21 +/- 3) ч. Продукцию индола определяют одним из общепринятых методов - с помощью индикаторных бумажек, реактива Ковача или Эрлиха.
При ферментации лактозы до кислоты и газа и образовании индола дают положительный ответ на наличие E. coli. В документе о результатах проведенного исследования (например, протокол, отчет) записывают: "E. coli X КОЕ/100 см3".
7.4. Определение E. coli с использованием лактозного бульона с борной кислотой или лактозо-пептонной среды.
Для упрощения исследования подтверждающие тесты на ферментацию лактозы при температуре (44 +/- 0,5) °C и образование индола можно заменить посевом в лактозный бульон с борной кислотой и поплавками для улавливания газа, или лактозо-пептонной средой с поплавками, прогретым до температуры 44 - 45 °C, с последующей инкубацией при температуре (44 +/- 0,5) °C в течение (24 +/- 2) ч. При использовании лактозного бульона с борной кислотой индол не определяют. Положительный ответ на E. coli дают при помутнении среды и наличии газа в пробирке. В документе о результатах проведенного исследования (например, протокол, отчет) записывают: "E. coli X КОЕ/100 см3".
7.5. Ускоренное определение E. coli с использованием Хромокультколиформ агара.
Хромокультколиформ агар можно использовать для определения E. coli в первичном посеве (приложение 2 к настоящим МУК). В качестве E. coli учитывают крупные синие или сине-фиолетовые колонии. Поскольку в среду добавлен триптофан, то при нечеткой дифференциации можно подтвердить наличие E. coli по образованию индола при нанесении реактива Ковача или Эрлиха капельным методом на подозрительные колонии. Окрашивание колоний стабильно сохраняется в течение нескольких дней и не зависит от pH среды, температуры и освещения.
7.6. Ускоренное определение E. coli на триптоновом агаре с желчью и X-глюкуронидом.
Среда позволяет определять E. coli в первичном посеве. На данной среде через 24 ч инкубации посевов образуются колонии зеленого цвета, которые учитывают как E. coli. Рост посторонней флоры угнетается за счет содержания в среде желчи и температуры инкубации (44 +/- 0,5) °C.
7.7. Определение E. coli методом мембранной фильтрации с использованием среды с желчью.
Для определения E. coli используют две среды: триптон-желчный агар (далее - ТЖА) и триптон-соевый агар (далее - ТСА).
После фильтрования отмеренных объемов воды мембранные фильтры с посевами помещают на ТСА и инкубируют в термостате при температуре (37 +/- 1) °C в течение 4 - 5 ч.
Затем фильтры переносят на ТЖА и продолжают инкубацию посевов при температуре плюс (44 +/- 0,5) °C в течение 19 - 20 ч.
После инкубации посевов учитывают наличие или отсутствие на фильтрах роста колоний.
При росте на фильтрах изолированных колоний белого, палевого, кремового цвета мембранный фильтр помещают на фильтровальную бумагу, смоченную реактивом для индольного теста (реактив Ковача, Эрлиха), и облучают ультрафиолетовой лампой в течение 10 - 30 мин в зависимости от скорости окрашивания.
Все колонии микроорганизмов красного цвета на мембранном фильтре учитывают как колонии E. coli и подсчитывают их число.
Использование реактива Ковача на водной основе (для ускоренного индольного теста) дает более четкие и быстрые результаты без применения ультрафиолетового облучения.
Неравномерное распределение колоний микроорганизмов на фильтре или обильный рост сопутствующих микроорганизмов могут мешать идентификации колоний микроорганизмов с положительной реакцией на образование индола из-за диффузии окраски в прилегающие колонии микроорганизмов.
Обработку результатов проводят в соответствии с пунктом 6.3.3 аналогично обработке результатов по определению общих колиформных бактерий.
В документе о результатах проведенного исследования (например, протокол, отчет) записывают: "E. coli X КОЕ/100 см3".
При отсутствии роста колоний E. coli на фильтрах или наличии отрицательной реакции на образование индола (отсутствие изменения цвета колоний) в документе о результатах проведенного исследования (например, протокол, отчет) записывают: "E. coli не обнаружена в 100 см3".
7.8. Определение бактерий E. coli титрационным методом.
Если в посевах накопительной среды (лактозо-пептонной среды с поплавком или селективный EC бульон - приложение 2 к настоящим МУК) обнаружено помутнение, кислота и газ, а при последующем высеве на среду Эндо (фуксин-сульфитную среду Эндо, среду Эндо с розоловой кислотой) выросли темно-красные колонии с металлическим блеском и отпечатком на обратной стороне среды или желтые на среде с тергитолом 7, то подтверждают наличие E. coli, для чего по 2 - 3 типичные колонии с каждого сектора плотной среды засевают в пробирки со средой, содержащей триптофан для установления способности продуцировать индол при температуре (44 +/- 0,5) °C. После инкубации посевов продукцию индола определяют одним из общепринятых методов (реактивом Ковача или Эрлиха, индикаторной полоской).
Вместо среды, содержащей триптофан, можно сделать посев в лактозный бульон с борной кислотой, соблюдая описанные выше условия посева и инкубации. Положительный ответ на наличие в среде E. coli дают при помутнении, образовании газа.
Высев из накопительных питательных сред можно производить на одну из хромогенных сред, триптонный агар с желчью и X глюкоронидом (приложение 2 к настоящим МУК) с последующей выдачей ответа.
Допускается проведение идентификации выделенных возбудителей методом время пролетной масс-спектрометрии (Matrix-assisted laser desorption ionization-time of flight mass spectrometry, далее - MALDI-TOF MS) или с использованием автоматического бактериологического анализатора.
Учет результатов проводят по таблицам приложений 4 - 6 к настоящим МУК.
В документе о результатах проведенного исследования (например, протокол, отчет) записывают: "НВЧ E. coli в 100 см3".
7.9. Метод определения E. coli с использованием готовых питательных сред на подложке.
7.9.1. Готовые питательные среды на подложке для определения обобщенных колиформных бактерий и E. coli готовят к анализу в соответствии с инструкцией производителя с соблюдением правил стерильности.
Сначала проводят фильтрацию проб воды с помощью мембранных фильтров (приложение 3 к настоящим МУК).
После фильтрации фильтры стерильным пинцетом помещают на подложку. Посевы инкубируют в термостате при температуре (37 +/- 1) °C в течение (21 +/- 3) ч.
Обобщенные колиформные бактерии, в зависимости от использованной тест-системы, определяют по следующим признакам: характерному цвету колоний, изменению цвета среды вокруг колоний. Наличие газообразования под пленкой петрифильма также подтверждает присутствие в пробе воды колиформных бактерий.
Для определения E. coli при использовании подложек с питательной средой одновременно с ростом бактерий учитывают газообразование и характерную окраску колоний, что исключает дополнительный этап их идентификации.
Расчет и оформление результатов проводят по формуле (2) в соответствии с п. 10.3.3.
7.10. Метод определения бактерий E. coli с использованием хромогенных сред (например, хромогенная питательная среда для определения наличия/отсутствия колиформных бактерий и E. coli в 100 см3 воды) (качественный метод).
7.10.1. Анализ с использованием хромогенной питательной среды для определения наличия/отсутствия колиформных бактерий и E. coli в 100 см3 воды проводят в соответствии с инструкцией производителя (приложение 15 к настоящим МУК).
Пробы воды хранят не более 24 ч в холодильнике при температуре от 2 °C до 8 °C, при этом посев начинают после нагревания пробы до комнатной температуры, но не позднее чем через 6 ч.
В стерильный прозрачный флакон, вместимостью 250 см3 с завинчивающейся крышкой, помещают 100 см3 пробы воды.
Вынимают один пакет из упаковки, слегка постучав, чтобы гранулы среды оказались на дне пакета, надламывают его верхнюю часть, не дотрагиваясь до открытой части пакета, чтобы избежать внешнего загрязнения питательной среды.
Содержимое пакета добавляют во флакон к пробе воды. Закрывают флакон и перемешивают до полного растворения гранулированной среды.
Посевы инкубируют в течение (21 +/- 3) ч при температуре (37 +/- 1) °C.
После инкубации посевов проводят учет результатов:
- E. coli отсутствуют, если цвет среды не изменился или отмечено помутнение без изменения цвета среды;
- бактерии обнаружены, если среда приобрела зелено-голубой цвет во всем объеме или верхнем слое. При перемешивании цвет среды не должен изменяться.
Для подтверждения наличия E. coli в емкостях, в которых отмечено изменение цвета среды, вносят 2,5 см3 реактива Ковача. Красное кольцо на поверхности среды подтверждает образование индола, что свидетельствует о наличии E. coli в исследуемой пробе воды. Наличие E. coli можно подтвердить также по свечению содержимого емкости в УФ-свете при использовании УФ-лампы (при наличии флуорогенного субстрата в составе среды).
Изменение цвета хромогенной среды при определении наличия/отсутствия обобщенных колиформных бактерий и E. coli в 100 см3 воды представлено в приложении 15 к настоящим МУК.
7.10.2. При изменении цвета среды и флюоресценции в документе о результатах проведенного исследования (например, протокол, отчет) записывают: "E. coli обнаружена в 100 см3", если цвет среды не изменился: "E. coli не обнаружена в 100 см3".
8.1. Энтерококки - грамположительные, каталазоотрицательные, полиморфные, круглые или чаще слегка вытянутые с заостренными концами кокки, располагающиеся попарно или в коротких цепочках, способные расти на питательных средах с 0,04% азида натрия. Основное индикаторное значение имеет Enterococcus faecalis и Enterococcus faecium.
8.2. Энтерококки - индикаторный показатель фекального загрязнения, определяемый при проведении лабораторного контроля воды всех видов водопользования.
8.3.1. Выполнение исследования.
Исследуют два объема с дальнейшим пересчетом на 100 см3. Объем испытуемой воды для посева выбирают с таким расчетом, чтобы на двух фильтрах выросли изолированные колонии не более 50 КОЕ при диаметре фильтра 35 мм и не более 100 колоний при диаметре фильтра 47 мм. При исследовании питьевой воды и воды бассейнов для учета выбирают все фильтры, на которых есть рост типичных колоний.
Отмеренный объем воды фильтруют через мембранные фильтры. После фильтрации фильтр переносят, не переворачивая, на одну из плотных сред: плотную азидную среду Сланец-Бартли, энтерококкагар, желчь-эскулин-азидный агар или азидный агар с канамицином и эскулином (готовая питательная среда) или используют другие среды аналогичного качества (приложение 2 к настоящим МУК) и добиваются полного прилегания фильтра к среде без пузырьков воздуха. Чашки с посевами помещают в термостат дном вверх и инкубируют при температуре (37 +/- 1) °C в течение 24 - 48 ч.
На среде Сланец-Бартли, энтерококкагаре подсчитывают колонии, характерные для энтерококков: выпуклые, с ровными краями, темно-малиновые (Enterococcus faecalis) и розовые, светло-розовые, равномерно окрашенные или с темно-красным не четко оформленным центром (Enterococcus faecium) в зависимости от используемой среды.
На желчь-эскулин-азидном агаре типичные колонии энтерококков образуют коричнево-черную зону вокруг колоний.
На азидном агаре с канамицином и эскулином колонии коричнево-черные, окруженные черным ореолом.
Очень мелкие (на пределе видимости невооруженным глазом), плоские разных оттенков, ярко-малиновые с четко выраженным центром и бесцветным ободком колонии не учитывают. Дифференциацию энтерококков от посторонней микрофлоры допускается проводить по морфологии колоний под бинокулярной лупой.
При необходимости подтверждения наличия в пробе воды энтерококков отбирают по 2 - 3 колонии каждого типа и используют один или несколько вариантов тестов:
а) окрашивают по Граму и микроскопируют (приложение 13 к настоящим МУК). При обнаружении в мазках грамположительных полиморфных, как правило, слегка вытянутых с заостренными концами диплококков, дают положительный ответ;
б) выполняют каталазный тест. Для этого петлей наносят каплю дистиллированной воды на предметное стекло, в которой растирают исследуемую культуру. После подсушивания на воздухе добавляют каплю свежеприготовленной 3%-й перекиси водорода. При отсутствии пузырьков газа считают тест каталазоотрицательным. В качестве контрольной каталазоположительной культуры используют любой вид стафилококков.
8.3.2. Для определения количества энтерококков в исследуемом объеме воды подсчитывают число колоний энтерококков на фильтрах, суммируют и вычисляют по формуле (3):
где: X - число КОЕ энтерококков в 100 см3 воды;
a - число подсчитанных энтерококков в сумме;
V - объем воды, профильтрованной через фильтры, на которых проводили учет.
В документе о результатах проведенного исследования (например, протокол, отчет) записывают: "Энтерококки X КОЕ/100 см3".
При отсутствии роста колоний в документе о результатах проведенного исследования (например, протокол, отчет) записывают: "Энтерококки в 100 см3 не обнаружены".
8.4. Определение энтерококков титрационным методом.
8.4.1. Выполнение исследования.
Анализируемый объем воды и ее разбавления засевают параллельно в 2 или 3 ряда накопительной щелочно-полимиксиновой среды. Объемы 100 и 10 см3 засевают в равные объемы среды двойной концентрации; 1 см3 исследуемой воды или ее разбавления засевают в 5 см3 среды нормальной концентрации. Посевы инкубируют при температуре (37 +/- 1) °C. Через (44 +/- 4) ч из посевов, где отмечены признаки роста (помутнение или помутнение и изменение цвета среды), производят пересев на 4 - 6 секторов одной из плотных питательных сред (молочно-ингибиторной, далее - МИС), энтерококкагар, азидную среду Сланеца-Бертли, желчь-эскулин-азидный агар или азидный агар с канамицином и эскулином. Плотные питательные среды инкубируют при температуре (37 +/- 1) °C в течение (21 +/- 3) ч, при отсутствии роста посевы оставляют до (44 +/- 4) ч.
В качестве положительных результатов на МИС отмечают наличие аспидно-черных, выпуклых колоний с металлическим блеском, ровными краями (Enterococcus faecalis), а также мелких сероватых колоний (Enterococcus faecium). При высеве на энтерококкагар, азидную среду Сланеца-Бертли, желчь-эскулин-азидный агар или азидный агар с канамицином и эскулином учет проводят по п. 8.3. Для подтверждения наличия энтерококков по 2 - 3 колонии каждого типа микроскопируют и проводят каталазный тест.
Допускается проведение идентификации выделенных возбудителей методом MALDI-TOF MS.
Вычисляют НВЧ в 100 см3 энтерококков по одной из таблиц приложений 5 и 6 к настоящим МУК. В документе о результатах проведенного исследования (например, протокол, отчет) записывают: "НВЧ энтерококков в 100 см3".
8.5. Определение энтерококков упрощенным методом.
При анализе воды титрационным методом лактозо-пептонная среда используется для накопления ОКБ и одновременно энтерококков. Сначала делают высев из лактозо-пептонной среды для определения колиформных бактерий, затем - на энтерококки. Из всех емкостей лактозо-пептонной среды, где имелось помутнение, независимо от наличия или отсутствия газа, делают высев со дна пробирки на сектора одной дифференцирующей среды (МИС, энтерококкагар, азидная среда Сланеца-Бертли, желчь-эскулин-азидный агар или азидный агар с канамицином и эскулином) путем троекратного нанесения материала бактериологической петлей диаметром 2 - 3 мм для посева штрихом. Среды инкубируют 24 - 48 ч при температуре (37 +/- 1) °C. Посев штрихом делают с таким расчетом, чтобы к концу штриха получить изолированные колонии. Учет результатов по п. 8.4.2.
8.6. Метод определения энтерококков с использованием хромогенных сред (например, хромогенная питательная среда для определения наличия/отсутствия энтерококков и D-стрептококков в 100 см3 воды (качественный метод).
Анализ с использованием хромогенной питательной среды для определения наличия/отсутствия энтерококков и D-стрептококков в 100 см3 воды проводят в соответствии с инструкцией производителя (приложение 15 к настоящим МУК).
В стерильный прозрачный флакон вместимостью 250 см3 с завинчивающейся крышкой помещают 100 см3 пробы воды. При хранении пробы воды ниже 25 °C, в том числе в холодильнике, пробы перед посевом выдерживают при комнатной температуре.
Вынимают один пакет из упаковки, слегка постукивают, чтобы гранулы среды оказались на дне пакета, после чего надламывают его верхнюю часть, не дотрагиваясь до открытой части пакета, чтобы избежать внешнего загрязнения питательной среды.
Содержимое пакета добавляют во флакон к образцу воды. Закрывают флакон и перемешивают до полного растворения гранулированной среды. Посевы инкубируют в течение (21 +/- 3) ч при температуре (37 +/- 1) °C.
После инкубации посевов проводят учет результатов:
- бактерии энтерококков отсутствуют, если цвет среды не изменился или отмечено помутнение среды без изменения цвета;
- энтерококки обнаружены, если цвет среды изменился.
При перемешивании цвет среды не должен изменяться. Изменение цвета среды даже в верхней части флакона также подтверждает наличие энтерококков в пробе воды (реакция с хромогенным субстратом X-GLU). В документе о результатах проведенного исследования (например, протокол, отчет) записывают: "Энтерококки обнаружены в 100 см3", если цвет среды изменился; "Энтерококки не обнаружены в 100 см3", если цвет среды не изменился.
9.1. Парагемолитические вибрионы - условно-патогенные галофильные микроорганизмы семейства Vibrionaceae, обитающие в соленых водоемах. Vibrioparahaemolyticus - грамотрицательные, подвижные, оксидазоположительные, прямые или изогнутые палочки. Для выделения парагемолитического вибриона используют питательные среды с содержанием хлорида натрия. Обогатительные и элективные среды должны содержать натрия хлорида до 3%, а дифференциально-диагностические - от 1,5 до 3,0%.
9.2. Воду соленых поверхностных водоемов исследуют качественным и количественным методами при проведении санитарно-эпидемиологического расследования.
9.3. Качественный анализ воды.
Морскую воду для качественного исследования отбирают в объеме 1,0 дм3. К исследуемой пробе воды в объеме 1 дм3 добавляют 100 мл основного 10%-го раствор пептона, приготовленного из пептона основного сухого до 1%-й концентрации.
Посевы инкубируют 18 - 20 ч при температуре (37 +/- 1) °C, после чего делают высев петлей с поверхностного слоя обогатительной среды для получения роста в виде изолированных колоний на 2 среды, например: селективная среда для выделения патогенных вибрионов - тиосульфат-цитрат-желчные соли-сахароза (англ. Thiosulfate Citrate Bile Sucrose, далее - TCBS) и дифференциально-диагностический агар с пенициллином (далее - ДДА). Посевы инкубируются при температуре (37 +/- 1) °C в течение 24 ч.
Парагемолитические вибрионы формируют колонии правильной округлой формы, плоско-выпуклые, полупрозрачные в проходящем свете с влажной блестящей поверхностью размером 2 - 3 мм в диаметре, не отличающиеся по цвету от голубовато-зеленого цвета элективных сред (TCBS, ДДА), т.к. вибрионы этого вида не ферментируют сахарозу, входящую в них. Подозрительные колонии отсевают на щелочной агар - питательную среду для выделения и культивирования холерного вибриона, сухую и на одну из полиуглеводных сред (например, Ресселя, Клиглера), разрешенные к применению для этих целей в Российской Федерации в установленном порядке.
На полиуглеводных средах отбирают культуры с типичным для парагемолитических вибрионов ростом. На среде Ресселя и Клиглера отмечают характерное для кислой реакции пожелтение цвета столбика (ферментация глюкозы) при сохранении цвета скошенной части агара (отсутствие ферментации лактозы).
Культуры, выросшие на щелочном агаре, изучают на наличие цитохромоксидазы. Из оксидазопозитивных готовят мазки по Граму.
Для дальнейшей идентификации отбирают оксидазопозитивные грамотрицательные культуры с характерным ростом на полиуглеводных средах. Отобранные культуры изучают по набору признаков (подвижность, лизиндекарбоксилаза, аргининдигидролаза, индол, рост в средах с различными концентрациями натрия хлорида, ферментация/окисление глюкозы на среде Хью-Лейфсона, арабинозы, сахарозы, целлобиозы, салицина, реакция Фогес-Проскауэра) в соответствии с документами, в т.ч. инструкциями по применению, утвержденными в установленном порядке.
В документе о результатах проведенного исследования (например, протокол, отчет) записывают: "Парагемолитические вибрионы обнаружены/не обнаружены в 1 дм3" (результат качественный).
9.4. Количественное исследование воды.
Для количественного исследования отбирают воду в объеме 200 см3 в стерильную посуду с непромокаемой пробкой. Воду исследуют в объемах 1 x 50 см3, 5 x 10 см3 и 5 x 1 см3. Объемы воды 10 см3 и 1 см3 засевают в 50 см3 1%-й пептонной воды с 3% NaCl, а в объем 50 см3 добавляют 5 см3 основного раствора пептона. Дальнейшее исследование всех объемов проб проводят по схеме качественного анализа воды.
По окончании идентификации выделенных культур подсчитывают число объемов проб, из которых выделены парагемолитические вибрионы (положительный результат). В зависимости от различных комбинаций положительных и отрицательных результатов определяют НВЧ парагемолитических вибрионов в 100 см3 воды (приложение 4 к настоящим МУК). В документе о результатах проведенного исследования (например, протокол, отчет) записывают: "НВЧ парагемолитических вибрионов в 100 см3".
Индекс парагемолитических вибрионов в воде морских прибрежных зон должен быть не выше 1 000 КОЕ в 1 дм3 в местах рекреации и 500 КОЕ в 1 дм3 - в местах водозабора.
10.1. Колифаги - бактериальные вирусы, способные лизировать кишечную палочку и формировать зоны лизиса (бляшки) на ее газоне на питательном агаре через (18 +/- 2) ч при температуре (37 +/- 1) °C.
10.2. Колифаги - нормируемый показатель, обязательный для проведения лабораторного, в том числе производственного, контроля качества различных вод.
Превышение норматива по колифагам при исследовании воды свидетельствует о ее потенциальной эпидемиологической опасности в отношении вирусного загрязнения.
10.3. Определение колифагов титрационным методом.
Определение колифагов титрационным методом заключается в предварительном накоплении колифагов в среде обогащения на культуре E. coli и последующем выявлении зон лизиса (просветления) газона E. coli на питательном агаре.
10.3.1. Выполнение качественного исследования.
Выполнение данного исследования начинается с подготовки тест-культуры - E. coli K-12F + StrR. На всех этапах исследования используют бактериальную взвесь, приготовленную следующим образом: E. coli K-12F + StrR засевают в пробирку со скошенным питательным агаром со стрептомицином (из расчета содержания 100 мкг стрептомицина на 1 см3 питательного агара). Возможен посев E. coli K-12F + StrR в пробирку со скошенным питательным агаром без стрептомицина при предварительном подтверждении чистоты пересеваемой культуры по морфологическим и биохимическим свойствам согласно паспорту штамма, выдаваемого из коллекции.
Через (18 +/- 2) ч инкубации при температуре (37 +/- 1) °C производят смыв бактерий с косяка 5 см3 стерильным физиологическим раствором и по стандарту мутности готовят взвесь E. coli K-12F + StrR в концентрации 109 бактериальных клеток в 1 см3 (10 ЕД или 3,0 McF).
Допускается в день исследования внести петлю E. coli K-12F + StrR в пробирку с 5 см3 питательного бульона, инкубировать в течение 4 ч при температуре (37 +/- 1) °C.
В исследуемую пробу воды объемом 100 см3 вносят 10 см3 10-кратного питательного бульона и 1 см3 подготовленного смыва тест-культуры или 2 см3 4-часовой бульонной культуры.
Для контроля культуры 0,1 см3 смыва бактерий E. coli K-12F + StrR или 0,2 см3 4-часовой бульонной культуры помещают в чашку Петри и заливают питательным агаром.
Исследуемую пробу воды (100 см3) и чашку Петри с контрольным посевом E. coli K-12F + StrR помещают в термостат и инкубируют при температуре (37 +/- 1) °C в течение (18 +/- 2) ч.
После инкубации из исследуемой пробы воды отливают в пробирку 10 см3 и добавляют 1,0 см3 хлороформа (процедура проводится в вытяжном шкафу или в боксе биологической безопасности 2 класса с фильтрами тонкой очистки). Пробирку закрывают стерильной резиновой или силиконовой пробкой, энергично встряхивают для равномерного распределения хлороформа по объему пробы и оставляют при комнатной температуре на 15 - 20 мин до полного осаждения хлороформа. Допускается исследуемую пробу воды вместо обработки хлороформом пропускать через бактериальный фильтр с диаметром пор 0,45 мкм.
В расплавленный и остуженный до 45 - 50 °C питательный агар вносят E. coli K-12F + StrR из расчета 1,0 см3 смыва или 2 см3 4-часовой бульонной культуры на 100 см3 агара.
В стерильную чашку Петри пипеткой переносят 1 см3 обработанной пробы воды, не касаясь хлороформа или 1 см3 пробы воды после фильтрации и заливают подготовленным питательным агаром в объеме 12 - 15 см3. Для контроля роста E. coli K-12F + StrR заливают этим же агаром дополнительную чашку Петри. Для равномерного перемешивания пробы воды с агаром чашку осторожно покачивают и оставляют на столе до полного застывания при комнатной температуре. После застывания агара чашки переворачивают и помещают в термостат на (18 +/- 2) ч при температуре (37 +/- 1) °C. При выполнении серии проб ставится общий контроль для всей серии.
Учет результатов.
Для учета результатов чашки просматривают в проходящем свете. Проба считается положительной при наличии полного лизиса, наличии нескольких или одной бляшки (зоны просветления) на чашке с анализируемой пробой воды при отсутствии зон лизиса на контрольной чашке.
В документе о результатах проведенного исследования (например, протокол, отчет) записывают: "Колифаги обнаружены/не обнаружены в 100 см3" (результат качественный).
При наличии зон лизиса в контрольной чашке результат считается недействительным.
10.3.2. Выполнение количественного исследования.
Исследуемую пробу воды в объеме 100 см3 разлить в 6 емкостей: в 1 флакон 50 см3 и в 5 пробирок по 10 см3. В 50 см3 воды добавить 5 см3 10-кратного питательного бульона и 0,5 см3 смыва (или 1 см3 4-часовой бульонной культуры) E. coli K-12F + StrR. В каждые 10 см3 пробы внести по 1 см3 10-кратного питательного бульона и 0,1 см3 смыва или 0,2 см3 4-часовой бульонной культуры E. coli K-12F + StrR. Для контроля культуры E. coli K-12F + StrR 0,1 см3 смыва бактерий или 0,2 см3 4-часовой бульонной культуры поместить в чашку Петри и залить питательным агаром. Посевы инкубировать при температуре (37 +/- 1) °C в течение (18 +/- 2) ч.
После инкубации из объема 50 см3 отливают в пробирку 10 см3. Во все 6 объемов добавляют по 1 см3 хлороформа (процедура проводится в вытяжном шкафу или в боксе биологической безопасности 2 класса с фильтрами тонкой очистки). Пробирки закрывают стерильными резиновыми или силиконовыми пробками, энергично встряхивают для равномерного распределения хлороформа по объему пробы и оставляют при комнатной температуре на 15 - 20 мин до полного осаждения хлороформа. Допускается исследуемую пробу воды вместо использования хлороформа пропускать через мембранный фильтр с диаметром пор 0,45 мкм.
В предварительно расплавленный и остуженный до (45 - 47) °C питательный агар добавить приготовленный смыв бактерий E. coli K-12F + StrR из расчета 1,0 см3 смыва или 2 см3 4-часовой бульонной культуры на 100 см3 агара. Смесь разлить в чашки Петри: 1 чашку для контроля E. coli K-12F + StrR и по одной чашке на каждую исследуемую пробу. При одновременном анализе нескольких проб ставится один контроль культуры E. coli K-12F + StrR.
После застывания агара чашки, предназначенные для посева проб, разделить на 6 секторов, промаркировать их, в соответствии с исследуемыми объемами. На каждый сектор из соответствующей пробирки нанести пастеровской пипеткой или микропипеткой (бактериологической петлей продольным штрихом) по капле надосадочной жидкости без хлороформа или воду после фильтрации. После подсыхания чашки с исследуемыми пробами и контрольную чашку поместить в термостат (37 +/- 1) °C на (18 +/- 2) ч.
Учет результатов.
При учете результатов просмотр чашек осуществляется в проходящем свете. Учет проводится по наличию зон лизиса на секторах газона E. coli K-12F + StrR. При применении капельного способа посева пипеткой образуется зона лизиса в виде округлого пятна или отдельных бляшек. При посеве продольным штрихом бактериологической петлей отмечают лизис по ходу штриха. Проба считается положительной при наличии зоны лизиса хотя бы на одном из секторов при отсутствии зон лизиса на контрольной чашке.
Оценка проводится по НВЧ колифагов (приложение 7 к настоящим МУК). В документе о результатах проведенного исследования (например, протокол, отчет) записывают: "НВЧ БОЕ/100 см3".
При наличии зон лизиса в контрольной чашке результат считают недействительным.
10.4. Определение колифагов прямым методом.
10.4.1. Определение колифагов прямым методом заключается в посеве нормируемого объема (100 см3) воды в чашки Петри и последующего подсчета всех выросших бляшек на газоне E. coli K-12F + StrR с питательным агаром.
10.4.1.1. Прямой метод определения колифагов в воде является альтернативой титрационному методу, при необходимости получения быстрого, точного ответа по количественному содержанию колифагов в воде поверхностных водоемов, сточной воде по эпидпоказаниям.
10.4.1.2. Выполнение исследования.
В питательный агар удвоенной концентрации расплавленный и остуженный до 45 - 49 °C внести E. coli K-12F + StrR (1 см3 смыва бактерий или 2 см3 4-часовой культуры на каждые 100 см3 агара), перемешать. В 5 стерильных чашек Петри диаметром 142 мм добавить 20 см3 пробы или в 10 чашек Петри диаметром 90 мм - 10 см3 пробы. Каждую чашку залить смесью агара с культурой E. coli K-12F + StrR из расчета 2 части агара к 1 части пробы. Содержимое чашек осторожно перемешать и оставить при комнатной температуре до застывания. Контролем служит чашка Петри, залитая смесью агара и E. coli K-12F + StrR. Чашки с застывшим агаром поместить вверх дном в термостат и инкубировать при температуре (37 +/- 1) °C в течение (18 +/- 2) ч.
10.4.1.3. Учет результатов.
При учете результатов просмотр чашек осуществляется в проходящем свете. Изолированные бляшки, выросшие на чашках Петри, подсчитывают и суммируют. В документе о результатах проведенного исследования (например, протокол, отчет) записывают: "Колифаги X БОЕ/100 см3". В контрольной чашке бляшки должны отсутствовать.
Наиболее часто на питательном агаре зоны лизиса (бляшки) выглядят прозрачными пятнами (на фоне газона тест-культуры) округлой формы от 1 до 5 - 7 мм диаметром с четкими выраженными или стертыми границами.
При высоких концентрациях колифага наблюдается разная картина лизиса. Слияние негативных колоний дает "ажурный" газон E. coli K-12F + StrR рост единичных бляшек при наличии "ажурного" газона практически отсутствие газона E. coli K-12F + StrR при полном его лизисе.
Возможен лизис, маскируемый негомогенно застывшим агаром, а также скрытым ростом сопутствующей микрофлоры. Капли конденсата, пузырьки воздуха, негомогенно застывший агар могут приводить к образованию артефактов на газоне E. coli K-12F + StrR, визуально напоминающих лизис.
Предварительный учет результатов можно проводить через 5 - 6 ч инкубации. На этом этапе, при наличии четких зон лизиса, может быть выдан предварительный ответ о присутствии колифагов в воде.
Окончательный количественный учет прямого посева проводят через (18 +/- 2) ч. В документе о результатах проведенного исследования (например, протокол, отчет) записывают: "Колифаги X БОЕ/100 см3".
Если отмечен сливной рост бляшек и их подсчет затруднителен, может быть выдан качественный результат "Колифаги обнаружены в 100 см3".
При наличии зон лизиса в контрольной чашке результат исследования считается недействительным.
Подсчет бляшек после 24 ч инкубации может дать ложноположительный результат за счет роста других микроорганизмов в случае загрязнения культуры.
10.5. Постановка контроля исследований посевов на колифаги.
Отрицательный результат исследования контрольных проб воды подтверждает отсутствие контаминации колифагом питательных сред, лабораторной посуды, оборудования на этапах подготовки и проведения исследования, а также позволяет оценить способность тест-культуры E. coli K-12F + StrR давать равномерный газон.
Контролем служит исследование стерильной водопроводной воды, проводимое аналогично анализируемой пробе воды. Так, при анализе воды титрационным методом 10 см3 стерильной водопроводной воды вносят в дополнительную пробирку, а при анализе воды прямым посевом 20 см3 стерильной водопроводной воды вносят в дополнительную, шестую чашку Петри. Далее эти посевы исследуют аналогично основным пробам. При анализе серии проб контроль может быть один на каждый вид исследования: титрационный и прямой. Кратность проведения исследования контрольных проб - 1 раз в день.
В случае обнаружения бляшек колифагов в чашках с контрольными пробами стерильной воды результаты исследования тестируемых проб воды признаются недействительными.
Контрольные исследования являются обязательными для проверки стерильности лабораторного оборудования, посуды, питательных сред, оценки чистоты тест-штамма E. coli K-12F + StrR.
10.6. Подтверждение фаговой природы лизиса.
При работе как титрационным, так и прямым методом, в случае обнаружения на чашках сомнительных бляшек или артефактов, следует провести исследование на подтверждение фаговой природы лизиса.
С этой целью бактериологической петлей извлекают участок агара, подозрительный на колифаг, помещают его в 3 - 5 см3 питательного бульона, добавляют каплю тест-культуры E. coli K-12F + StrR и инкубируют при температуре (37 +/- 1) °C в течение (18 +/- 2) ч. В полученную взвесь вносят 0,5 см3 хлороформа (процедура проводится в вытяжном шкафу), перекрывают резиновой пробкой, интенсивно встряхивают и через 15 мин после осаждения хлороформа исследуют надосадочную жидкость на наличие колифага. Высев осуществляется пипеткой или бактериологической петлей на питательный агар. Наличие четких, характерных для фага, зон лизиса на поверхности агара подтверждает "фаговую" природу лизиса.
11.1. Staphylococcus aureus (род Staphylococcus) - факультативно анаэробные, грамположительные, каталазоположительные неподвижные кокки диаметром от 0,5 до 1,5 мкм, располагающиеся одиночно, парами или гроздьями, хорошо развиваются на питательных средах с содержанием 5 - 7% NaCl и pH 7,2 - 7,4 +/- 0,2. Не образующие спор формируют кремовый, желтый и золотистый пигмент, обладают лецитиназной, плазмокоагулазной и гемолитической активностью, в аэробных условиях ферментируют мальтозу и маннит.
11.2. Staphylococcus aureus являются индикаторным показателем загрязнения воды микрофлорой верхних отделов дыхательных путей, кожных покровов и желудочно-кишечного тракта человека, определяются в воде, используемой при оценке качества воды плавательных бассейнов и аквапарков. Staphylococcus aureus способны вызывать воспалительные заболевания кожи, поражения верхних отделов дыхательных путей, глаз и наружного уха.
11.3. Определение бактерий Staphylococcus aureus методом мембранной фильтрации.
Пробу в объеме 100 см3, а при загрязнении воды - 100 см3; 10 см3; 1,0 см3 фильтруют через мембранные фильтры. При исследовании воды неизвестного качества засевается ряд десятикратных разведений для получения изолированных колоний. После фильтрации фильтры помещают на одну дифференциальную среду (желточно-солевой агар, среду Байрд-Паркер, стафилококкагар или другую среду (приложение 2 к настоящим МУК), и инкубируют при температуре (37 +/- 1) °C в течение (21 +/- 3) - (44 +/- 4) ч.
На желточно-солевом агаре Staphylococcus aureus вырастает в виде круглых выпуклых или слегка возвышающихся над поверхностью агара колоний диаметром 2 - 4 мм кремового, желтого, золотистого цвета с ровными краями.
96 - 98% колоний Staphylococcus aureus окружены радужным кольцом с перламутровым блеском, являющимся зоной лецитиназной активности.
На среде Байрд-Паркер колонии Staphylococcus aureus черные, блестящие выпуклые, диаметром 1 - 5 мм с узким белым краем, окруженные прозрачной зоной шириной 2 - 5 мм. Непрозрачные кольца появляются в прозрачных зонах только после (44 +/- 4) ч инкубации.
На стафилококкагаре колонии Staphylococcus aureus круглые, выпуклые, непрозрачные, блестящие, с ровными краями светло-желтого оттенка, колонии диаметром 2,0 - 4,0 мм.
Для подтверждения принадлежности выросших бактерий к Staphylococcus aureus определяют отношение к окраске по Граму, способность коагулировать плазму крови кролика, способность образовывать каталазу, ферментировать мальтозу или маннит в аэробных условиях.
Учет результатов.
Число колоний Staphylococcus aureus подсчитывают, делят на объем воды, профильтрованной через фильтры, на которых велся учет, и умножают на 100. В документе о результатах проведенного исследования (например, протокол, отчет) записывают: "Staphylococcus aureus X КОЕ/100 см3". Если не подтверждено наличие Staphylococcus aureus ответ выдают: "Staphylococcus aureus не обнаружен в 100 см3".
11.4. Определение бактерий Staphylococcus aureus титрационным методом.
11.4.1. Выполнение исследования.
Посев 100 см3 воды производят в 10 см3 концентрированной пептонной среды с хлористым натрием лактозо-пептонной среды.
Посев инкубируют при (37 +/- 1) °C в течение 24 - 48 ч. Из пробирок с посевами, в которых наблюдается помутнение (а также образование кислоты и газа), делают высев петлей штрихами на поверхность селективных или дифференциально-диагностических сред (желточно-солевой агар, яично-желточно-солевой агар, стафилококкагар, среда Байрд-Паркер агар, молочно-солевой агар) для определения стафилококков. Чашки с посевами помещают в термостат вверх дном и инкубируют при температуре (37 +/- 1) °C в течение 24 - 48 ч.
11.4.2. Учет результатов.
Если в посеве обнаружены характерные для Staphylococcus aureus колонии, грамположительные кокки, обладающие лецитиназой и плазмокоагулирующей активностью, образующие каталазу, ферментирующие мальтозу (или маннит) в аэробных условиях в документе о результатах проведенного исследования (например, протокол, отчет) записывают: "Staphylococcus aureus X КОЕ /100 см3". Если не подтверждено наличие Staphylococcus aureus ответ выдают: "Staphylococcus aureus не обнаружен в 100 см3".
При необходимости провести исследования количественным методом определяют наиболее вероятное число (НВЧ) Staphylococcus aureus (приложение 6 к настоящим МУК). В документе о результатах проведенного исследования (например, протокол, отчет) записывают: "НВЧ Staphylococcus aureus в 100 см3".
11.5. Определение каталазы.
Тест основан на способности каталазы микроорганизма разлагать перекись водорода с выделением пузырьков газа. На колонию микроорганизмов, взятую с поверхности питательной среды, или извлеченную из нее и помещенную на предметное стекло, после подсушивания наносят каплю 3%-го раствора перекиси водорода. Через 30 - 60 сек появление пузырьков газа на стекле указывает на наличие каталазной активности у культуры микроорганизма. Допускается внесение капли перекиси водорода на край культуры, выросшей на питательной среде.
11.6. Определение способности коагулировать плазму.
Способность коагулировать плазму крови кролика определяют у каталазоположительных колоний, образовавших пигмент на питательной среде.
Коммерческую кроличью плазму разводят непосредственно перед постановкой теста. Разведенную плазму по 0,3 - 0,5 см3 разливают в стерильные пробирки и добавляют 1 петлю суточной культуры, выросшей на поверхности питательного агара. Допускается добавлять к плазме по 1 петле испытуемой культуры с агаризированных сред с соблюдением инструкции производителя. Одна пробирка остается без добавления культуры и является отрицательным контролем. В еще одну пробирку добавляется 1 петля эталонной культуры Staphylococcus aureus (положительный контроль). Внесенную культуру тщательно размешивают и помещают в термостат при температуре (37 +/- 1) °C. Учет результата проводится через 4 - 18 ч. Если через 6 ч свертывания плазмы не произошло, то пробирки оставляют при комнатной температуре на (21 +/- 3) ч. Если через (21 +/- 3) ч плазма не скоагулировала, то испытуемую культуру стафилококка относят к коагулазоотрицательной.
Для ускорения выявления коагулазоположительных стафилококков к 0,5 см3 разведенной плазмы допускается прибавление 2 капель культуры, выращенной на мясо-пептонном бульоне, после появления видимых признаков роста микроорганизмов спустя 2 - 4 ч.
Оценка коагулазной реакции проводится на кресты: тест на коагулазу считается положительным, если отмечается 3+ (большой сформировавшийся комочек) и 4+ (все содержимое пробирки скоагулировало и не меняет своего положения при наклонах пробирки). Обязательная постановка положительного контроля с контрольным (референтным) штаммом Staphylococcus aureus.
11.7. Определение ферментации мальтозы и (или) маннита в аэробных условиях.
Культуры, подлежащие исследованию, высевают уколом петли или штрихом в одну из сред: среду Гисса с мальтозой или маннитом, питательную среду N 10 ГРМ, среду для ферментации мальтозы. Посевы инкубируют при температуре (37 +/- 1) °C в течение (44 +/- 4) ч. При ферментации мальтозы (маннита) с образованием кислоты цвет среды меняется. Staphylococcus aureus ферментирует мальтозу (маннит) в аэробных условиях.
Биохимическую активность допускается проводить с использованием коммерческих тест-систем или на автоматическом биологическом анализаторе.
Допускается проведение идентификации выделенных возбудителей методом MALDI-TOF MS.
12.1. Сульфитредуцирующие клостридии - спорообразующие анаэробные палочковидные микроорганизмы, редуцирующие сульфит натрия до сульфидов на железосульфитном агаре при температуре (44 +/- 0,5) °C в течение 16 - 18 ч.
12.2. В воде источников централизованного питьевого водоснабжения споры сульфитредуцирующих клостридий определяют в связи с использованием этого показателя для оценки эффективности обработки питьевой воды на этапах технологических процессов, поскольку споры сульфитредуцирующих клостридий являются более устойчивыми, чем вегетативные клетки бактерий к воздействию обеззараживающих агентов, а также к неблагоприятным факторам воды водоемов.
Общепринятым является представление о том, что споры сульфитредуцирующих клостридий указывают на давнее фекальное загрязнение. Длительность выживаемости этих споровых микроорганизмов в воде водоемов превышает таковую сальмонелл, что свидетельствует о наличии у данного показателя одного из наиболее важных свойств индикаторного микроорганизма.
12.3. Подготовка проб к анализу.
Пробу воды 20 см3 перед посевом прогревают на водяной бане при температуре (75 +/- 5) °C в течение 15 мин для устранения вегетативных форм (время отсчитывают после достижения указанной температуры).
При исследовании хлорированной воды прогревание пробы можно не производить.
Железосульфитный агар, среда Вильсон-Блера или другие среды аналогичного качества (приложение 2 к настоящим МУК) расплавляются непосредственно перед посевом (повторному расплавлению агар не подлежит). В течение посева поддерживают температуру среды до (75 +/- 5) °C в водяной бане.
12.4. Определение спор сульфитредуцирующих клостридий методом фильтрования в пробирках.
Каждую пробу питьевой воды фильтруют на фильтры в объеме 10 (в двух повторностях) или 20 см3 (в одной повторности). Стерильным пинцетом берут фильтр за два противоположных края и, согнув в виде трубочки, помещают в пробирку с горячим агаром. Сторона фильтра с осевшими бактериями обращена внутрь. При этом фильтр распрямляется и располагается по стенке пробирки. Сразу же после посева пробирку с агаром и фильтром для создания анаэробных условий быстро охлаждают, помещая в емкость с холодной водой. Культивируют посевы при температуре (44 +/- 0,5) °C в течение 16 - 18 ч.
12.5. Определение спор сульфитредуцирующих клостридий на чашках.
В чашки Петри наливают расплавленную среду для выделения клостридий. После фильтрации воды фильтр помещают фильтрующей поверхностью вниз и заливают до краев чашки остатком используемой среды так, чтобы толщина второго слоя питательной среды была не менее 4 мм. Культивируют посевы в CO2-инкубаторе или в термостате при (44 +/- 0,5) °C в течение 16 - 18 ч.
Подготовленную пробу или ее разведения высевают также глубинным методом в две чашки Петри. Посевы заливают триптозо-сульфит-циклосериновым или сульфит-полимиксин-неомициновым агаром, или сахарным кровяным агаром по Цейсслеру, или агаром Вильсон-Блера или рекомендуемой для применения дифференциальной средой. Содержимое чашек Петри быстро, осторожными круговыми движениями перемешивают. После застывания среды посевы на чашках Петри термостатируют в CO2-инкубаторе или в термостате при температуре (44 +/- 0,5) °C в течение 16 - 18 ч.
12.6. Определение сульфитредуцирующих клостридий прямым посевом.
12.6.1. Выполнение исследования.
В стерильные пробирки вносят:
- по 10 см3 исследуемой пробы воды в 2 пробирки (объемом не менее 30 см3);
- по 5 см3 исследуемой пробы воды в 4 пробирки (объемом по 15 см3).
Посевы заливают горячим железосульфитным агаром или другой средой, разрешенной к применению в установленном порядке в количестве, превышающем объем воды в 2 раза. Среду заливать по стенке пробирки, избегая образования пузырьков воздуха. После этого пробирку быстро охлаждают, помещая ее в емкость с холодной водой для создания анаэробных условий. Посевы инкубируют при температуре (44 +/- 0,5) °C в течение 16 - 18 ч.
12.6.2. Учет результатов.
Количественному учету подлежат только те посевы, где получены изолированные колонии. Подсчитывают черные колонии, выросшие как на фильтрах, так и в толще питательной среды. При учете посевов прямым методом число колоний пересчитывают на объем 20 см3. В документе о результатах проведенного исследования (например, протокол, отчет) записывают: "Сульфитредуцирующие клостридии X КОЕ спор/20 см3".
При отсутствии роста черных колоний на всех фильтрах в документе о результатах проведенного исследования (например, протокол, отчет) записывают: "Сульфитредуцирующие клостридии не обнаружены в 20 см3". При невозможности учета колоний из-за сливного роста результат оценивается как качественный, в документе о результатах проведенного исследования (например, протокол, отчет) записывают: "Сульфитредуцирующие клостридии обнаружены в 20 см3".
13.1. Род Salmonella входит в семейство Enterobacteriaceae и состоит из родственных по фенотипическим и генотипическим свойствам микроорганизмов. Согласно последним данным, род Salmonella представлен двумя видами: S. enterica и S. bongori.
Сальмонеллы вида S. enterica подразделяют на подвиды и обозначают следующими символами:
- подвид I - S. enterica подвид enterica (subsp. enterica);
- подвид II - S. enterica подвид salamae (subsp. salamae);
- подвид IIIa - S. enterica подвид arizonae (subsp. arizonae);
- подвид IIIb - S. enterica подвид diarizonae (subsp. diarizonae);
- подвид IV - S. enterica подвид houtenae (subsp. houtenae);
- подвид VI - S. enterica подвид indica (subsp. indica);
- сальмонеллы вида S. bongori - представлены одним подвидом:
- S. bongori подвид bongori (subsp. bongori), серовары S. bongori имеют символ V.
Серологические варианты (серовары) каждого подвида определяются по O- и H-антигенной характеристике.
Естественным резервуаром сальмонелл вида S. enterica подвидов I и II (enterica и salamae) служат теплокровные животные, а для представителей остальных подвидов (IIIa, IIIb, IV, VI) и вида S. bongori (V) - хладнокровные животные и окружающая среда.
Большинство инфекций, связанные с водным фактором передачи вызваны нетифоидными бактериями рода Salmonella (S. enterica подвид Enterica серотип Enteritidis, S. Typhimurium, S. Newport, S. Heidelberg и S. Javiana) характеризуются значительным полиморфизмом клинического течения с преимущественным поражением желудочно-кишечного тракта, возможной генерализацией и различной выраженности симптомов общей интоксикации и обезвоживанием.
Сальмонеллы - факультативно-анаэробные, лактозонегативные грамотрицательные палочки, оксидазонегативные, каталазоположительные, подвижные (кроме, S. Gallinarun, S. Pullorum) имеют перитрихиальные жгутики, хорошо растут на обычных питательных средах за исключением нескольких сероваров (например, S. Paratyphi A, S. Choleraesuis, S. Typhisuis, S. Sendai, S. Gallinarun) при температуре (37 +/- 1) °C. D-глюкозу ферментируют с образованием кислоты и газа (S. Typhi газа не образуют), ферментируют рамнозу, ксилозу, арабинозу, мальтозу, дульцит, сорбит, трегалозу, маннит, метиловый красный и цитрат позитивные, продуцируют сероводород, индол, не образуют ацетоин, не расщепляют мочевину.
13.2. Определение сальмонелл проводят в воде при превышении нормативов по основным индикаторным показателям контроля и по эпидемическим показаниям с целью подтверждения их отсутствия/присутствия в 1 дм3 воды для принятия экстренных профилактических мер по устранению фекального загрязнения.
13.3. Качественный метод определения.
Качественное исследование является сигнальным и применяется при исследовании водных объектов, в которых обнаружение сальмонелл имеет существенное эпидемическое или гигиеническое значение.
Для определения сальмонелл в пробах воды, в т.ч. в обеззараженной сточной воде, качественным методом исследуют 1000 см3 воды вне зависимости от степени ее бактериального загрязнения. Для этого засевают по 500 см3 в две из следующих сред накопления: среду с хлоридом магния (магниевую или Раппапорта-Василиадиса), селенитовый бульон, среду Мюллера-Кауфмана, среду РНС.
Качественный анализ сточной воды до очистки, ввиду ее высокого бактериального антагонизма, проводить не рекомендуется.
Посев воды в магниевую среду накопления: к 500 см3 исследуемой воды прибавляют 500 см3 магниевой среды обычной концентрации. При экспедиционной методике посева навески ингредиентов магниевой среды по одной вносят в исследуемый объем воды и тщательно взбалтывают до полного растворения солей (приложение 2 к настоящим МУК).
Посев воды в среду Раппапорта-Василиадиса: в зависимости от степени бактериального загрязнения к 500 см3 исследуемой воды прибавляют 500 см3 среды обычной или двойной концентрации (приложение 2 к настоящим МУК).
Посев воды в среду Мюллера-Кауфмана: 500 см3 исследуемой воды вносят в среду 500 см3 (приложение 2 к настоящим МУК).
Посев воды в селенитовый бульон: к 500 см3 воды добавляют 500 см3 селенитового бульона двойной концентрации (приложение 2 к настоящим МУК).
Посев воды в среду РНС: 500 см3 засевают в 1 емкость, содержащую 500 см3 питательной среды для накопления сальмонелл, или 2 объема по 250 см3 - во флаконы с 250 см3 питательной среды (приложение 2 к настоящим МУК).
Инкубация посевов в магниевой среде, селенитовом бульоне, средах РНС и Мюллера-Кауфмана производят при температуре (37 +/- 1) °C, на среде Раппапорта-Василиадиса при температуре (41,5 +/- 1) °C.
Качественный анализ можно выполнять с использованием метода мембранной фильтрации (приложение 3 к настоящим МУК). Для этого фильтруют 2 объема по 500 см3 или 4 x 250 см3. Каждый исследуемый объем воды фильтруют через один или несколько мембранных фильтров, которые затем помещают во флаконы, содержащие по 100 см3 среды накопления. При затрудненной фильтрации большого объема пробы на фильтр с диаметром пор 0,45 мкм следует наложить фильтр с большим диаметром пор для задержания взвешенных частиц. После окончания фильтрации оба фильтра помещаются в среду накопления.
13.4. Количественный метод определения.
Выполнение количественного анализа рекомендуется для изучения этиологии острых сальмонеллезных гастроэнтеритов и подтверждения водного пути их распространения, так как эпидемический потенциал воды определяется количественным содержанием в ней сальмонелл. Количественный анализ необходим также при изучении процессов самоочищения, выживаемости сальмонелл в водной среде, взаимосвязи их с другими микроорганизмами, при оценке обеззараживания воды.
Количественный анализ сальмонелл проводят титрационным методом, который основан на накоплении бактерий при посеве определенного объема воды в питательную среду, в соответствии с объемами, необходимыми для расчета по таблицам в приложениях 8 и 9 к настоящим МУК.
Объем исследуемой пробы для посева и количество повторов выбирают в зависимости от предполагаемой степени ее бактериального загрязнения.
Для обнаружения сальмонелл используют не менее двух сред накопления по следующим схемам (целесообразно использовать питательную среду РНС и магниевую среду):
- при исследовании питьевой воды, воды плавательных бассейнов и аквапарков производят посев 3 объемов по 100 см3, 3 объемов по 10 см3 и 3 объемов по 1 см3 (приложение 8 к настоящим МУК);
- при исследовании воды открытых водоемов производят посев 2 объемов по 100 см3, 2 объемов по 10 см3, 2 объемов по 1 см3 и по 2 объема из разведений от 10-1 до 10-3. Если предполагается значительное загрязнение водоема, ряд разведений может быть продолжен до 10-4 (приложение 8 к настоящим МУК).
При исследовании питьевой воды, поверхностных водоемов, воды плавательных бассейнов и аквапарков можно производить посев следующим образом: 1 объем по 500 см3, 1 объем по 50 см3, 1 объем по 5 см3, 1 объем по 0,5 см3 в одну среду накопления и аналогичные объемы во вторую. Если предполагается значительное загрязнение водоема, ряд разведений может быть продолжен до 10-4. НВЧ рассчитывают в соответствии с таблицей приложения 9 к настоящим МУК.
При этом 100 см3 воды засевают во флаконы со 100 см3 среды нормальной концентрации, 10 см3 в пробирки с 10 см3 среды, 1 см3 и разведения в пробирки с 9 см3 среды накопления.
Для обнаружения сальмонелл в сточных водах используют не менее двух сред накопления по следующим схемам:
- при исследовании сточных вод до очистки засевают: 2 объема по 1 см3 и 2 объема из разведений от 10-1 до 10-7;
- при исследовании сточных вод после очистки - 2 объема по 100 см3, 2 объема по 10 см3, 2 объема по 1 см3 и 2 объема из разведений от 10-1 до 10-3 и после биологической очистки дообеззараживания засевают в равное количество среды накопления удвоенной концентрации, 10 см3 сточной жидкости засевают в 100 см3 среды нормальной концентрации, 1 см3 стока и последующие разведения вносят в 10 см3 среды нормальной концентрации.
После обеззараживания сточную воду исследуют по схеме посева поверхностных водоемов, увеличивая количество разведений до 10-4.
Посевы воды в среде накопления инкубируют при температуре (37 +/- 1) °C в течение (21 +/- 3) ч.
13.5. Выделение сальмонелл из среды накопления на плотной селективно-дифференциальной среде.
Через (21 +/- 3) ч инкубации посевов определяют наличие признаков роста бактерий в среде накопления. Из каждой емкости, где отмечено равномерное помутнение среды, производят высев на 2 среды для выделения сальмонелл одним из способов для получения изолированного роста колоний. С этой целью можно использовать висмут-сульфитный агар, хромогенный агар (англ. Salmonella Chromogenic Agar), ксилозо-лизин-дезоксихолатный (англ. XLD - Xylose Lysine Deoxycholate) агар, дезоксихолатный цитратный агар (Гинса), Гектоенагар и другие среды, разрешенные для применения.
Засеянные емкости со средой накопления без наличия признаков роста оставляют еще при температуре (37 +/- 1) °C до (44 +/- 4) ч после чего делают высев на 2 чашки с плотной селективно-дифференциальной средой. Посевы на плотной селективно-дифференциальной среде через (44 +/- 4) ч без признаков роста считают отрицательными.
Через (21 +/- 3) ч инкубации при температуре (37 +/- 1) °C на плотной селективно-дифференциальной среде проводят просмотр посевов и отбирают колонии подозрительные на сальмонеллы. При отсутствии подозрительных колоний чашки с селективными средами (приложение 2 к настоящим МУК) оставляют в термостате еще на (21 +/- 3) ч. При отсутствии подозрительных на сальмонеллы колоний через (44 +/- 4) ч дают окончательный отрицательный ответ в документе о результатах проведенного исследования (протокол, отчет) - "Сальмонеллы в 1000 см3/1 дм3 не обнаружены".
На висмут-сульфит агаре сальмонеллы растут в виде аспидно-черных колоний с металлическим блеском участка среды вокруг колонии, так называемое "зеркало", и черным отпечатком под колонией. Исключение в этом отношении составляют S. paratyphi A, некоторые сальмонеллы из группы C и других групп, которые при росте на висмут-сульфит-агаре образуют нежные, зеленоватые колонии с темным центром и без него, слегка выпуклые с ровными краями.
На агаре Плоскирева сальмонеллы образуют прозрачные или нежно-розовые колонии.
На Гектоенагаре сальмонеллы имеют черный центр и слегка прозрачную зону голубовато-зеленого цвета (рост E. coli подавляется, колонии энтеробактерий родов Enterobacter и Citrobacter - желто-оранжевого цвета, среда вокруг колоний окрашена в розоватый цвет).
На среде Эндо - колонии сальмонелл бледно-розовые.
На хромогенном агаре колонии сальмонелл окрашены в пурпурный цвет; микроорганизмы, не являющиеся сальмонеллами, имеют синий цвет или не окрашиваются ни одним из хромогенов среды. Колиформные бактерии растут в виде сине-зеленых или сине-фиолетовых колоний. Остальные энтеробактерии (Shigella, Proteus) и Pseudomonas, вырастают в виде бесцветных, желтоватых колоний.
На ксилозо-лизин-дезоксихолатном агаре (среде XLD) сальмонеллы образуют колонии красного цвета с черным центром за счет образования сероводорода.
На дезоксихолатном цитратном агаре колонии сальмонелл, образующие сероводород, темные.
13.6. Идентификация сальмонелл по биохимическим и серологическим тестам.
Дальнейшие исследования по биохимической и серологической идентификации сальмонелл проводят по общепринятой схеме (приложение 10 к настоящим МУК).
13.7. Биохимические тесты.
Через (21 +/- 3) ч инкубации при температуре (37 +/- 1) °C на плотных селективно-дифференциальных средах проводят просмотр посевов и отбирают подозрительные на сальмонеллы колонии. При обнаружении на чашках колоний, подозрительных на сальмонеллы, по 3 - 4 изолированных колонии с каждой чашки снимают для посева в пробирки с комбинированными средами для определения биохимических свойств бактерий, подтверждающих их принадлежность к роду Salmonella (например, типа Ресселя, Клиглера, Олькеницкого).
На этих средах бактерии рода Salmonella ферментируют глюкозу с образованием газа, не ферментируют лактозу и сахарозу, образуют сероводород, не гидролизуют мочевину. В случае ферментации глюкозы реакция среды становится кислой и цвет индикатора в столбике изменяется. Если при расщеплении глюкозы, помимо кислоты, образуется газ, в среде появляются пузырьки. Появление желтой окраски в скошенной части агара свидетельствует о ферментации лактозы (и сахарозы) в среде Олькеницкого и ферментации лактозы в среде Клиглера и Ресселя. Образование сероводорода устанавливают по почернению среды. При росте культуры, гидролизирующей мочевину, среда приобретет диффузный яркий красно-малиновый цвет, что характерно для бактерий рода протеев. Культуры, не расщепляющие лактозу и мочевину, но ферментирующие глюкозу, образующие сероводород подвергают дальнейшему изучению для определения серовара. Окончательное определение морфологических, тинкториальных, биохимических и серологических свойств сероваров производят по общепринятым методам идентификации бактерий семейства Enterobacteriaceae.
Сальмонеллы не разлагают сахарозу, лактозу, мочевину и салицин, не образуют индол, ферментируют маннит и дульцит, образуют сероводород (H2S), декарбоксилируют лизин (за исключением некоторых штаммов S. typhimurium, S. enteritidis), подвижны (за исключением S. gallinarum).
Для определения родовой принадлежности культур можно использовать тест-системы и приборы, прошедшие испытания и рекомендованные к применению в лабораторной практике санитарно-эпидемиологического надзора.
Допускается проведение идентификации выделенных возбудителей методом MALDI-TOF MS.
Ферментативные свойства сальмонелл, выделенных из водной среды, не всегда стабильны и могут изменяться под влиянием стрессовых факторов. Важным этапом идентификации сальмонелл является изучение более устойчивой антигенной структуры в реакции агглютинации на стекле с O-, H- и Vi-агглютинирующими диагностическими сыворотками.
13.8. Серологические тесты.
Антигенная структура сложна и вариабельна. Ее составляют термостабильные, расположенные в клеточной стенке липополисахаридные O-антигены (соматические), жгутиковые H-антигены белковой природы и капсульные Vi-антигены (антигены вирулентности). У большинства сальмонелл жгутиковые антигены имеют фазовые вариации, т.е. могут существовать в двух фазах: фаза 1 и фаза 2. S. typhi синтезирует Vi-антиген, который также может быть обнаружен у S. paratyphi C и S. dublin. Определение сероваров основано на комбинации отдельных O- и H-антигенов.
Перед постановкой серологических тестов чистую культуру (1 колонию) отсевают на свежеприготовленный (с конденсатом на дне пробирки) скошенный простой питательный агар.
При серологической идентификации культур вначале проводят агглютинацию на стекле с поливалентной сальмонеллезной сывороткой (ABCDE), в случае получения отрицательного результата проводят агглютинацию с сыворотками редких групп. Если культуры реагируют с поливалентными сыворотками, то определят характерные для каждой серологической группы O-антигены. Затем определяют H-антигены.
Для проведения агглютинации используют сыворотки диагностические сальмонеллезные адсорбированные для реакции агглютинации согласно инструкции по применению.
На обезжиренное предметное стекло пипеткой наносят 1 каплю сыворотки. Петлю исследуемой (21 +/- 3) часовой культуры, снятой с питательного агара, вносят в одну из сывороток и тщательно размешивают ее путем растирания круговыми движениями петли. После каждой сыворотки петлю прожигают на огне.
Для агглютинации с O-сыворотками культуру следует брать с верхней части скошенного питательного агара, для агглютинации с H-сыворотками - из конденсационной воды, где расположены наиболее подвижные особи. Предварительно культуру контролируют на отсутствие спонтанной агглютинации с физраствором.
Положительная реакция агглютинации наступает в течение 1 - 3 мин. Для учета агглютинации используют лупу с увеличением (2x) по четырехкрестной системе:
++++ - отчетливый агглютинат при полном просветлении жидкости;
+++ - отчетливый агглютинат на фоне мутноватой жидкости;
++ - незначительный агглютинат на фоне мутной жидкости;
+ - незначительное количество агглютината на фоне мутной жидкости;
- - гомогенная мутная жидкость.
Положительной считается реакция агглютинации интенсивностью не менее, чем на +++.
Иногда оказывается, что исследуемая культура обладает свойствами неспецифически выпадать в осадок в физиологическом растворе или агглютинировать во всех или почти всех групповых O-сыворотках. Это происходит при переходе культуры из S (гладкой) в R (шероховатую) форму. Штаммы, находящиеся в R-форме, обладают самопроизвольной агглютинацией. Их дальнейшее серотипирование не представляется возможным без дополнительных манипуляций. Такие штаммы пересевают на щелочной агар для того, чтобы выбрать колонию с ровными краями и вернуть штамм в S (гладкую) форму и повторить агглютинацию.
При определении H-антигенов нередко возникают трудности, связанные с отсутствием, выявляемым при агглютинации, одной из фаз. Для восстановления отсутствующей фазы H-антигена применяют метод Свен-Гарда. Для этого исследуемую культуру в виде бляшки засевают в центр чашки с 0,8 - 1% полужидким питательным агаром. К остуженному до температуры 50 °C агару перед тем, как залить его в чашку, добавляют 2 - 3 капли (5 капель на 30 см3 агара) H-сыворотки к той фазе жгутикового антигена, которая была выявлена у данной культуры и которую рекомендуется подавить. Гомологичная сыворотка задерживает рост клеток с выявленной фазой и способствует развитию элемента противоположной фазы. Можно нанести 1 каплю в центр чашки на поверхность застывшего агара.
Через 24 ч инкубации при температуре (37 +/- 1) °C бактерии с искомой фазой H-антигена оказываются на периферии макроколонии.
Серологическая классификация сальмонелл представлена в схеме Кауфмана-Уайта, которая является каталогом диагностически значимых антигенов сальмонелл.
13.9. Учет результатов.
При выполнении качественного анализа в документе о результатах проведенного исследования (например, протокол, отчет) записывают: "Сальмонеллы в 1000 см3/1 дм3 обнаружены или не обнаружены".
При выполнении количественного анализа наиболее вероятную величину индекса сальмонелл (НВЧ) в 1000 см3 воды определяют согласно приложению 8 к настоящим МУК.
В документе о результатах проведенного исследования (например, протокол, отчет) записывают: "НВЧ сальмонелл в 1000 см3/1 дм3".
14.1. Бактерии рода Shigella - грамотрицательные факультативно-анаэробные бактерии, неподвижные, ферментируют глюкозу, не ферментируют лактозу, не расщепляют мочевину, не обладают лизиндекарбоксилазой, не утилизируют цитрат, не образуют сероводород и ацетоин.
14.2. Обнаружение бактерий рода Shigella в водных объектах свидетельствует о реальной опасности возникновения кишечной инфекции среди населения и необходимости принятия оперативных мер по устранению загрязнения.
Для выявления шигелл используют 2 накопительные среды: селенитовый бульон и селективный бульон для бактерий рода Shigella (приложение 2 к настоящим МУК).
Для этого профильтровывают 1 дм3 воды по 500 см3 воды на один мембранный фильтр, один фильтр вносят в 100 см3 селенитового бульона, второй фильтр в 100 см3 селективного бульона для бактерий рода Shigella. Посевы инкубируют при температуре (37 +/- 1) °C в течение (21 +/- 3) ч. После инкубации посевов при наличии признаков роста (помутнение среды) из каждого флакона делают высевы на 2 чашки со средой: ксилозо-лизиновый агар с дезоксихолатом (англ. Xylose lysine deoxycholate agar, далее - XLD), ЭМС (агар с эозиновым метиленовым синим), среду Плоскирева (далее бактоагар Плоскирева), сальмонелла/шигелла агар (SS агар), среду Эндо или Гектоенагар.
Посевы помещают в термостат дном вверх при температуре (37 +/- 1) °C и инкубируют в течение (21 +/- 3) ч.
Учет результатов.
Типичные колонии бактерий рода Shigella вырастают на:
- XLD агаре - в виде красных колоний (в виде цвета среды), прозрачные;
- ЭМС-агаре - в виде круглых, прозрачных, нежных, бесцветных колоний. Колонии шигелл Зонне более плотные, иногда белесоватые, с изрезанными краями;
- бактоагаре Плоскирева - в виде бесцветных прозрачных, нежных колоний, слегка возвышающихся над поверхностью агара (шигеллы Флекснера). Колонии шигелл Зонне бывают иногда белесоватые, приобретающие через 48 ч слегка розовый оттенок;
- сальмолелла/шигелла агаре, на средах Эндо, Левина - в виде круглых бесцветных или слегка розоватых колоний;
- на Гектоенагаре шигеллы зеленого цвета или голубоватого цвета (рост E. coli подавляется, энтеробактерии родов Enterobacter и Citrobacter - желто-оранжевого цвета, среда вокруг колоний окрашена в розоватый цвет).
При отсутствии в посевах на селективно-диагностических средах колоний типичных для бактерий рода Shigella выдают отрицательный ответ. В документе о результатах проведенного исследования (например, протокол, отчет) записывают: "Бактерии рода Shigella в 1000 см3/1 дм3 не обнаружены". При наличии типичных колоний проводят окраску по Граму, биохимическую идентификацию не менее 5 колоний (приложения 13 и 14 к настоящим МУК) и постановку серологических тестов с диагностическими шигеллезными сыворотками в реакции агглютинации на стекле.
При выявлении шигелл дают положительный ответ. В документе о результатах проведенного исследования (например, протокол, отчет) записывают "Бактерии рода Shigella в 1000 см3/1 дм3 обнаружены".
14.4. Определение бактерий рода Shigella методом прямого посева в питательные среды.
Для выявления бактерий рода Shigella используют 2 накопительные среды: селенитовый бульон и селективный бульон для шигелл. Производят посев 2 x 500 см3 в 500 см3 селенитового бульона и селективного бульона двойной концентрации. Посевы инкубируют при температуре (37 +/- 1) °C в течение (21 +/- 3) ч. Дальнейшие исследования проводят по п. 14.3.
15.1. Понятие показателя.
Pseudomonas aeruginosa (синегнойная палочка) - потенциально-патогенная, грамотрицательная облигатно-аэробная, не образующая спор палочка, подвижная с единичными, полярно расположенными жгутиками, обладает оксидазной активностью, расщепляет глюкозу до кислоты в аэробных условиях, может расти при температуре (42 +/- 1) °C, образует преимущественно сине-зеленый пигмент, относится к семейству Pseudomonadaceae.
15.2. Значение показателя.
Обнаружение P. aeruginosa в воде источников водоснабжения, питьевой воды и плавательных бассейнов сигнализирует одновременно о санитарном (как индикатор биологического загрязнения) и эпидемическом (как патоген) неблагополучии. Пробы воды отбирают общим объемом 1 дм3.
В качестве среды накопления используют среду Бонде с кристаллическим фиолетовым или иные альтернативные среды накопления и обогащения (среда N 8-ГРМ).
При этом 1 дм3 исследуемой питьевой воды засевают по 2 объема по 500 см3 в 50 см3 концентрата среды Бонде; или 1 объем по 500 см3 в 50 см3 концентрата среды Бонде и 5 объемов по 100 см3 - в 10 см3 концентрата среды Бонде.
Для сокращения объемов посевов используют метод мембранной фильтрации. После фильтрации 1000 см3 воды фильтр помещают в 100 см3 среды накопления нормальной концентрации, после фильтрации 10 см3 пробы мембранные фильтры помещают в 10 см3 среды накопления.
Инкубацию посевов осуществляют при температуре (37 +/- 1) °C в течение 24 - 48 ч. Допустимо инкубировать посев сточных вод при температуре (42 +/- 1) °C. Через (21 +/- 3) ч посевы просматривают. При отсутствии помутнения посевы инкубируют до (44 +/- 4) ч. Отсутствие роста в среде накопления через 48 ч позволяет выдать отрицательный ответ - "P. aeruginosa в 1000 см3/1 дм3 не обнаружена".
При помутнении среды накопления и образовании на поверхности тонкой прозрачной пленки, поднимающейся по стенке емкости, проводят пересев на одну из плотных сред: на сектора плотной среды "Блеск" или цетримидный агар. Емкость перед посевом не встряхивают. Петлей забирают пленку с поверхности и производят посев уколом ближе к борту чашки для снятия излишков посевного материала, потом остаток материала распределяют в виде макроколонии 1 x 4 см, далее посев проводят частыми многочисленными штрихами по поверхности среды для получения максимального количества изолированных колоний. Посевы помещают в термостат при температуре (37 +/- 1) °C на (44 +/- 4) ч с предварительным просмотром через (21 +/- 3) ч инкубации.
На цетримидном агаре колонии P. aeruginosa плоские желтовато-зеленоватого цвета, диаметром от 2 до 5 мм, образуется желтовато-зеленый пигмент (пиоцианин), флуоресцирующий в УФ-свете. При нечетком результате проводят идентификацию по дополнительным тестам.
На среде "Блеск" колонии P. aeruginosa красного цвета либо сплошь покрыты золотистым налетом, либо содержат многочисленные золотистые вкрапления. Иногда вокруг колонии отмечают просветление или светло-красное окрашивание среды. Часто колонии P. aeruginosa принимают веретенообразную форму, как бы распространяясь по вдавлению в агаре от штриха петлей. Появление блеска можно наблюдать уже через 20 - 22 ч инкубации при температуре (37 +/- 1) °C, но максимального развития феномен достигает через (42 +/- 2) ч. Среда "Блеск" бактерицидна для всех грамположительных и большинства грамотрицательных бактерий и лишь некоторые ТТХ-резистентные штаммы клебсиелл, серраций и энтеробактерий могут развиваться на среде "Блеск" в виде темно-красных разного размера колоний, лишенных блеска, или выпуклых блестящих ярко-красных колоний.
При наличии множественного роста колоний с золотистым блеском отбирают для последующего исследования 1 - 2 изолированные наиболее типичные колонии. При росте единичных колоний с блеском или с золотистыми вкраплениями отбирают все типичные колонии, но не более 5 - 6.
При массивном обсеменении объекта бактериями P. aeruginosa (сточные жидкости) исследование начинают непосредственно со второго этапа, т.е. с посева исследуемого объекта на среду "Блеск" или цетримидный агар или ГРМ N 9. При этом материал в объеме 0,1 см3 распределяют шпателем по поверхности среды.
Колонии P. aeruginosa образуют зеленый пигмент на селективной питательной среде с цетримидом (цетримидный агар, среда ГРМ N 9).
При наличии колоний характерной формы, продуцирующих пиоцианин, исследование считают законченным с положительным результатом. В документе о результатах проведенного исследования (например, протокол, отчет) записывают: "P. aeruginosa в 1000 см3/1 дм3 обнаружена".
При наличии пиоцианин-положительной колоний не типичной формы, но давшей на среде "Блеск" золотистый налет, подтверждают наличие бактерий P. aeruginosa, определяют реакцию цитохромоксидазы и тест "Грегерсена". При положительном результате обоих тестов исследования проводят одновременный посев на среду с мальтозой и среду О/Ф и среду Кинг-A (или аналогичные среды) для выявления пиоцианина.
Посев на среду с мальтозой выполняют макроколониями (бляшками) в количестве 12 - 18 на одной чашке. После инкубации посевов при температуре (37 +/- 1) °C в течение (21 +/- 3) ч определяют результат: цвет не изменен - реакция отрицательная, пожелтение макроколонии и подлежащей среды - реакция положительная.
Мальтозоотрицательные колонии засевают в среду Хью-Лейфсона (О/Ф) уколом до дна пробирки иглой не короче 6 см. Среду О/Ф инкубируют при температуре (37 +/- 1) °C в течение (21 +/- 3) ч. На среде О/Ф бактерии P. aeruginosa дают пожелтение верхней части среды - положительная оксидация и зеленое окрашивание нижних 2/3 столбика (оксидация +, ферментация -).
На среде Кинг-A или альтернативные среды, на одной чашке располагают 12 - 18 макроколоний. Посевы помещают в термостат на (21 +/- 3) ч при температуре (37 +/- 1) °C с последующим дополнительным хранением чашек с посевами при комнатной температуре в течение (21 +/- 3) ч. Макроколонии P. aeruginosa на среде Кинг-A, как правило, имеют характерную уплощенную, шероховатую форму с неровными краями и кружевным венчиком в результате ограниченного роения, реже гладкую с ровными краями. Колонии, образующие пиоцианин, дают сине-зеленое окрашивание, что позволяет отнести такие штаммы к P. aeruginosa, наличие пиоцианина один из основных и достаточно надежных признаков. Для подтверждения наличия флюоресцеина возможен посев на среду Кинг B, на которой ингибируется образование пиоцианина. В УФ-свете (длина волны 360 нм) будет наблюдаться зеленоватое свечение.
Допускается проведение идентификации выделенных возбудителей методом MALDI-TOF MS.
При подтверждении принадлежности обнаруженных бактерий к P. aeruginosa в документе о результатах проведенного исследования (например, протокол, отчет) записывают: "P. aeruginosa в 1000 см3/1 дм3 обнаружена". При отсутствии роста колоний в документе о результатах проведенного исследования (например, протокол, отчет) записывают: "P. aeruginosa в 1000 см3/1 дм3 не обнаружена".
15.4. Количественное определение P. aeruginosa в воде.
Количественное обнаружение P. aeruginosa в питьевой воде и воде бассейнов и аквапарков характеризует санитарное состояние объекта и уровень его эпидемической опасности. Для этого проводят посев проб воды в двух рядах (2 объема по 100 см3; 2 по 10 см3; 2 по 1 см3; 2 по 0,1 см3; 2 по 0,01 см3 и т.д. в зависимости от предполагаемого уровня загрязнения) среду Бонде. Идентификацию P. aeruginosa проводят вышеописанным способом. Учет НВЧ производят в соответствии с приложением 6 к настоящим МУК. В документе о результатах проведенного исследования (например, протокол, отчет) записывают: "НВЧ P. aeruginosa в 100 см3".
15.5. Определение P. aeruginosa методом мембранной фильтрации.
Пробы питьевой воды и поверхностных водоемов в количестве 2 объемов по 250 см3 и 5 объемов по 100 см3; воду бассейнов - 2 объема по 250 см3 фильтруют. Мембранные фильтры помещают на чашки Петри с цетримидным агаром, проверяют отсутствие воздушных пузырей под фильтром. Инкубацию чашек проводят при температуре (37 +/- 1) °C в течение (21 +/- 3) ч, если рост отсутствует, чашки оставляют до (44 +/- 4) ч. Все обнаруженные колонии, имеющие желто-сине-зеленую (пиоцианин), редко красно-коричневую окраску идентифицируют по п. 15.3. При подтверждении P. aeruginosa в документе о результатах проведенного исследования (например, протокол, отчет) записывают: "P. aeruginosa X КОЕ/1000 см3/1 дм3" или "P. aeruginosa X КОЕ/в 500 см3 воды бассейнов и аквапарков".
16.1. Бактерии Legionella pneumophila - грамотрицательные бактерии, прямые или слегка искривленные палочковидные, размером (3 x 0,5) мкм, спор и капсул не образуют, факультативно анаэробные, растут на обогащенных питательных средах. Размножение легионелл происходит активно в теплой воде в диапазоне температур (25 - 45) °C.
Выживают в системах кондиционирования воздуха, горячего водоснабжения за счет способности к образованию биопленок. Являются факультативными внутриклеточными паразитами человека.
16.2. Legionella pneumophila - возбудитель острых тяжелых пневмоний с высоким процентом летальных исходов 5 - 10% и респираторных заболеваний. Определяют при оценке качества горячей воды централизованного водоснабжения и в качестве дополнительного показателя по эпидпоказаниям, при оценке качества воды бассейнов и аквапарков при барбатировании воды и температуре выше 28 °C. В природных условиях легионеллы обитают повсеместно в пресноводных водоемах, преимущественно в некультивируемой форме, и паразитируют в амебах и других простейших. Высокие адаптивные способности легионелл позволяют им успешно колонизировать искусственные водные системы. Условия для их размножения в искусственных водных системах более благоприятны, чем в естественных, что приводит к накоплению данного возбудителя в высокой концентрации.
16.3. Подготовка проб.
Исследуемую пробу воды - 2 объема по 500 см3 пропускают через мембранные фильтры, которые помещают в стерильную емкость объемом 200 см3, содержащую 10,0 - 50,0 см3 солевого физиологического раствора. Флаконы с фильтрами помещают на встряхиватель на 10 мин. Смыв с поверхностей фильтров распределяют по 10 см3 в центрифужные пробирки и центрифугируют при температуре 6000 об/мин в течение 30 мин. Надосадочную жидкость полностью удаляют, а осадок тщательно ресуспендируют стерильной пипеткой в 1 см3 с солевым физиологическим раствором и переносят в стерильную пробирку.
16.4. Выполнение исследования.
Для выделения легионелл используют любую стандартную среду, разрешенную к применению на территории Российской Федерации (буферный угольно-дрожжевой агар (далее - БУДРАГ) с ростовой и селективной добавкой, легионелл бакагар в соответствии с инструкцией производителя, приложение 2 к настоящим МУК).
Исследования приведены на примере использования среды БУДРАГ. Для прогревания из подготовленного сконцентрированного образца отбирают 0,2 см3 и переносят в стерильную пробирку, после чего помещают на водяную баню при температуре 50 °C и прогревают в течение 30 мин. Для обработки кислотным буфером, 0,2 см3 сконцентрированного образца переносят в стерильную пробирку и добавляют 0,2 см3 раствора кислотного буфера KCl-HCl, pH 2,2, инкубируют при комнатной температуре в течение 4 мин. Для приготовления кислотного KCl-HCl буфера к 39 см3 0,4 М раствора HCl добавляют 250 см3 0,4 М раствора KCl. Доводят значение pH буфера до 2,2 с помощью 1 М раствора KOH. Хранят в темном флаконе при температуре 4 °C не более 1 месяца. Кислотную обработку проводят непосредственно перед посевом на плотные питательные среды. Далее по 0,1 см3 концентрированного, обработанного кислотным буфером и прогретого при температуре 50 °C образца, а также необработанного концентрата высевают на чашки со средой БУДРАГ с ростовой и селективной добавкой. Образец распределяется по поверхности питательной среды шпателем или стеклянной палочкой. Чашки инкубируют при температуре (37 +/- 1) °C до 10 дней во влажной атмосфере в присутствии 2,5% CO2.
Просмотр чашек БУДРАГ начинают с 2 суток, при отрицательном результате продолжают до 5 - 7 суток и в более поздние сроки. В случае массивной контаминации проб посторонней микрофлорой, не позволяющей проводить подсчет колоний, сконцентрированную пробу разводят в 100 раз и производят повторный высев. При анализе результата учитывают разведения.
Подозрительные на легионеллы колонии выявляют при стереомикроскопическом просмотре чашек или под лупой. На селективной среде колонии легионелл обычно имеют вросший центр, гранулярную или блестящую поверхность, серовато-голубоватую, иногда зеленоватую окраску. Колонии легионелл на 3 - 5 сутки небольшие, диаметром 1 - 2 мм, плоско-выпуклые, гладкие с острым краем.
Для идентификации бактерий рода Legionella spp. используют окраску мазков по Граму и посев на среду БУДРАГ без селективной и ростовой добавок, на которой колонии легионелл не вырастают.
Для этого с каждой чашки отбирают 2 - 3 подозрительные колонии, которые отсевают параллельно на среду БУДРАГ - контроль и на среду БУДРАГ без селективной и ростовой добавки, инкубируют при температуре (37 +/- 1) °C в течение 48 ч, а также приготавливают мазки для окраски по Граму.
В мазках легионеллы выглядят как небольшие грамотрицательные палочки длиной 2 - 3 мкм. В мазках с 4 - 5 дневных колоний длина легионелл может достигать 10 - 15 мкм.
Легионеллы растут на среде БУДРАГ без селективной добавки и не растут на контрольной среде.
Для идентификации бактерий рода Legionella spp. применяют также реакцию латекс-агглютинации (РЛА), ИХА, матрично-активированную лазерную времяпролетную масс-спектрометрию (MALDI-TOF) и молекулярно-генетические методы.
16.5. Учет результатов.
При обнаружении в пробах воды из систем горячего централизованного питьевого водоснабжения в документе о результатах проведенного исследования (например, протокол, отчет) записывают: "Legionella pneumophila в 1000 см3/1 дм3 обнаружена".
Если легионеллы не выявлены в исследуемом объеме записывают: "Legionella pneumophila в 1000 см3/1 дм3 не обнаружена".
При выявлении Legionella spp.: в исследуемой пробе воды в документе о результатах проведенного исследования (например, протокол, отчет) записывают: "Legionella ssp. обнаружена в 1000 см3/1 дм3, Legionella pneumophila в 1000 см3/1 дм3 не обнаружена".
17.1. К роду Campylobacter spp. относятся микроаэрофильные подвижные, хемоорганотрофные, не образующие спор и капсул грамотрицательные бактерии спиралевидной, S-образной или изогнутой формы. Длина клеток кампилобактеров 0,5 - 5 мкм, толщина - 0,2 - 0,8 мкм, имеют один или два полярно расположенных жгутика, могут обладать плазмидами. В старых культурах бактерии часто принимают сферические или кокковые формы.
Кампилобактерам присущ дыхательный тип метаболизма. В качестве источника энергии они в основном используют аминокислоты, но не утилизируют углеводы. Кампилобактеры - микроаэрофилы. Кислород необходим для их роста, для большинства штаммов оптимальной является концентрация кислорода 3 - 6%. При более высоких концентрациях становится токсичным для микроорганизмов. Кампилобактерии являются капнофилами, то есть нуждаются в высоких концентрациях CO2 (до 10%), обладают каталазной и оксидазной активностью.
17.2. Campylobacter spp. является дополнительным показателем контроля, который определяется по эпидемиологическим показаниям с целью подтверждения отсутствия/присутствия Campylobacter в 1 дм3 воды.
Бактерии рода Campylobacter, имеющие эпидемическое значение C. jejuni, C. coli, C. lari, C. upsaliensis, C. helveticus не должны содержаться в 1 дм3 исследуемой воды.
17.3. Определение бактерий Campylobacter spp. методом мембранной фильтрации.
17.3.1. Выполнение исследования.
Исследуемую пробу воды в объеме 1 дм3 (предварительно концентрируют фильтрованием через мембранные фильтры с диаметром пор 0,45 мкм. После фильтрации фильтры переносят во флаконы с 20 - 25 см3 обогатительной питательной средой для культивирования кампилобактерий - селективный бульон Престона, или селективный бульон Дойла, или бульон Мюллера-Хинтона, или Болтона. При исследовании морской воды с высоким уровнем биологического загрязнения и сточных вод в питательную среду вносят дополнительно селективные добавки антибиотиков. Посевы инкубируют в микроаэрофильных условиях при температуре (42 +/- 1) °C в течение 48 ч, с обязательным просмотром посевов через (24 +/- 2) ч.
Оптимальная газовая среда для культивирования бактерий рода кампилобактер имеет состав: двуокись углерода (CO2) - 10%, кислород - 5%, азот - 82%. Для ее создания можно использовать:
- газовую смесь заводского изготовления;
- газогенераторные пакеты;
- анаэробные инкубаторы или CO2-инкубаторы;
- анаэробные станции;
- пакеты (например, БиоМерье).
При наличии признаков роста в среде обогащения (равномерное помутнение среды или голубовато-серая пленка), осуществляют пересев на плотную селективную среду - кампилобакагар или угольный эритрит-агар. Длительность инкубации посевов при температуре (42 +/- 1) °C в микроаэрофильных условиях может составлять до 24 - 48 ч.
На поверхности селективного агара кампилобактерии образуют мелкие, округлые колонии или колонии средних размеров серого цвета или полупрозрачные с сероватым оттенком, гладкие, влажные, блестящие неправильной формы, как бы растекающиеся по ходу штриха.
На угольном эритрит агаре колонии серые, склонные к сливному росту.
Отбирают 5 типичных или подозрительных на принадлежность к Campylobacter spp. изолированных колоний (если число таких колоний менее 5, отбирают все колонии), суспендируя каждую из колоний в 1 см3 бульона в любой жидкой накопительной среде без антибиотиков и крови для кампилобактерий. Манипуляции по отбору колоний для исследования и их пересев необходимо проводить в максимально короткие сроки.
17.3.2. Идентификация выросших колоний.
Определение принадлежности к роду Campylobacter spp. проводят на основании окраски по Граму, определения подвижности при микроскопии раздавленной капли с помощью фазово-контрастного устройства. Бактерии рода Campylobacter spp. - грамотрицательные мелкие, тонкие палочки с одним или более завитками. В мазке имеют вид запятой, буквы S или галочки при соединении двух клеток. В стареющих культурах (через 48 - 72 ч инкубации на твердой среде) могут обнаруживаться кокковидные клетки.
Подтверждение принадлежности выросших колоний к роду Campylobacter spp. проводят на основании определения оксидазной и каталазной активности и способности утилизировать глюкозу, сахарозу и лактозу. Бактерии рода Campylobacter spp. оксидазоположительны, каталазоположительны, за исключением C. upsaliensis, не утилизируют углеводы.
Идентификацию бактерий C. jejuni от других видов бактерий рода Campylobacter spp. проводят по определению гидролиза гиппурата. Для определения гидролиза гиппурата в пробирку с 0,4 см3 раствора гиппурата вносят полную петлю исследуемой чистой культуры. Для полного смешивания пробирку инкубируют на водяной бане при температуре 37 °C в обычной атмосфере. Через 2 ч добавляют 0,2 см3 нингидринового реактива. После тщательного перемешивания пробирку с культурой дополнительно инкубируют на водяной бане в течение 10 мин. О положительной реакции свидетельствует появление фиолетового или темно-синего окрашивания. К гидролизу гиппурата способны только бактерии Campylobacter jejuni, представители других видов рода Campylobacter spp. не ферментируют гиппурат.
17.3.3. Для видовой дифференциации выделенных культур возможно применение коммерческих биохимических тест-систем согласно инструкции производителя.
Допускается проведение идентификации выделенных возбудителей методом MALDI-TOF MS.
17.3.4. При подтверждении принадлежности выросших колоний к Campylobacter spp. в документе о результатах проведенного исследования (например, протокол, отчет) записывают: "бактерии рода Campylobacter spp. в 1000 см3/1 дм3 обнаружены".
18.1. Род Yersinia включает группу грамотрицательных, не образующих спор, палочковидных (кокки или овоиды) факультативно-анаэробных микроорганизмов, относящихся к семейству Enterobacteriaceae.
18.2. Иерсиниозы широко распространены в мире. В ряде стран Европы кишечный иерсиниоз занимает третье место по заболеваемости среди кишечных инфекций, после кампилобактериоза и сальмонеллеза Y. enterocolitica биотипа 1A относят к непатогенным, однако они могут быть возбудителями оппортунистических инфекций, Y. enterocolitica биотипов 1B и 2 - 5 отнесены к патогенным для человека и животных. Y. enterocolitica определяют по эпидпоказаниям. При температуре 100 °C погибают в течение нескольких секунд, однако при температуре 50 - 60 °C способны выживать до 20 - 30 мин, переносят большие (до 10%) концентрации раствора натрия хлорида, особенно при низких температурах. На микроорганизмы губительно действует прямая солнечная радиация. Во влажной среде и невысокой температуре 14 - 18 °C выживают длительно. Кислотность среды (при уровнях pH 3,6 - 4,0) губительна для иерсиний. В дезинфицирующих растворах в стандартных разведениях микробы Yersinia погибают в течение 5 - 10 мин. Раствор перманганата калия в концентрации 0,3 - 0,5% вызывает гибель бактерий через 3 мин.
Определение Yersinia enterocolitica проводят в воде по эпидпоказаниям с целью подтверждения их отсутствия/присутствия в 1 дм3 воды.
18.3. Выполнение исследования на иерсиниозы.
18.3.1. При проведении бактериологического исследования на иерсиниозы исследуется вода из емкостей для хранения и вода открытых водоемов, морская вода в количестве 1 дм3.
18.3.2. Исследование проводят поэтапно:
1) посев на среды накопления;
2) высевы на дифференциально-диагностические среды, отсев характерных по морфологическим свойствам колоний иерсиний;
3) идентификация выделенных культур до вида возбудителя по морфологическим, биохимическим и серологическим свойствам, в том числе с использованием автоматизированных систем идентификации или коммерческих биохимических тест-систем согласно инструкции производителя.
18.3.2.1. I этап исследования (пробоподготовка и посев материала). Исследуемую воду 2 объема по 500 см3 или 4 объема по 250 см3 вносят в среды накопления: 1% пептонную воду или среду PSB в соотношении 1:1 и помещают в термостат при температуре (22 +/- 1) °C на 42 - 72 ч при перемешивании или на 5 - 7 суток без перемешивания.
18.3.2.2. II этап исследования (на 2 - 3 сутки от начала исследования). Проводят высев со сред накопления (2 - 3 сутки "холодового обогащения") на плотные дифференциально-диагностические среды (Иерсиния агар, Эндо, SSDC агар) или другие коммерческие дифференциальные среды для диагностики иерсиниозов, разрешенные к применению на территории Российской Федерации.
Для инактивации посторонней микрофлоры перед каждым высевом на плотную питательную среду проводят щелочную обработку материала. Пипеткой из верхней трети слоя накопительной среды (но не с поверхности), не взбалтывая, забирают 0,5 см3 и вносят в 4,5 см3 0,72%-й раствора гидроксида калия или в 0,5%-м раствор хлорида натрия на 30 - 60 секунд или 5%-м раствором тринатрия фосфата.
Затем петлей делают посев на поверхность плотных сред. Посевы на среде SSDC инкубируют при температуре (30 +/- 1) °C в течение 48 ч, на среде Эндо - 24 (не более 30 ч). На 4 - 5-е сутки от начала исследования просматривают посевы на дифференциально-диагностических средах и проводят учет морфологии колоний.
На среде Эндо - колонии мелкие (росинчатые), круглые, выпуклые, блестящие, бледные.
На SSDC агаре типичные колонии Yersinia enterocolitica мелкие (< 1 мм) и серые с расплывчатыми краями, не обладают радужным переливом и тонко гранулированы при проверке под лучами косого света.
На иерсиния-агар колонии круглые, гладкие, блестящие, сине-зеленые, диаметром не менее 1,5 мм.
Примечание: Косой, падающий свет помогает отличать типичные колонии Yersinia enterocolitica от похожих колоний бактерий рода Pseudomonas.
18.3.2.3. III этап (идентификации). Для идентификации проводят отбор 5 характерных для Y. enterocolitica колоний на дифференциальную среду с мочевиной (среду Олькеницкого, среду Ресселя I и II, железо-глюкозо-лактозный агар с мочевиной) и той же колонии - на скошенные столбики (или сектора) простого питательного агара (МПА, ГРМ, СПА и аналоги) для накопления бактериальной массы.
Посевы инкубируют на средах Олькеницкого, Ресселя I при температуре (37 +/- 1) °C, на МПА (АХ), среде Ресселя II - при температуре (26 +/- 2) °C, на среде железо-глюкозо-лактозный агар с мочевиной. При наличии сложности отбора колонии на две среды возможен первичный отбор колоний на среды с мочевиной с последующим пересевом уреазоположительных культур на МПА или среду Рессель II.
Для подтверждения уреазоположительные культуры проверяют по следующим тестам: микроскопия мазка, окрашенного по Граму; тест на цитохромоксидазу; тест на ферментацию углеводов на средах Гисса при температуре (26 +/- 2) °C; образование сероводорода, реакция Фогеса-Проскауэра при температуре (20 +/- 2) °C и (37 +/- 1) °C; декарбоксилирование орнитина, лизина при температуре (37 +/- 1) °C; утилизация цитрата (среда Симмонса) при температуре (37 +/- 1) °C (приложение 14 к настоящим МУК).
Проводят учет результатов биохимической идентификации и дифференциации Y. enterocolitica с использованием диагностических сывороток к Y. enterocolitica. Постановка реакции агглютинации на стекле с иерсиниозной сыворотками.
Допускается проведение идентификации выделенных возбудителей методом MALDI-TOF MS.
При обнаружении грамотрицательных, уреазоположительных (гидролизируют мочевину), оксидазоотрицательных колоний, ферментирующих глюкозу, образующих индол и не образующих сероводород подтверждается наличие Y. enterocolitica.
Выдается окончательный положительный ответ, в документе о результатах проведенного исследования (например, протокол, отчет) записывают: "бактерии Y. enterocolitica в 1000 см3/1 дм3 обнаружены".
Подтверждают условную патогенность Y. enterocolitica наличием орнитин декарбоксилазы и ферментации сахарозы; отсутствием лизин декарбоксилазы, ферментации рамнозы и гидролиза цитрата. Выделенная культура передается в лаборатории референс центров для изучения в соответствии с законодательством Российской Федерации <6>, а также методическими документами <7>.
--------------------------------
<6> Приказ Роспотребнадзора от 01.12.2017 N 1116 "О совершенствовании системы мониторинга, лабораторной диагностики инфекционных и паразитарных болезней и индикации ПБА в Российской Федерации".
<7> МУК 4.2.3019-12 "Организация и проведение лабораторных исследований на иерсиниозы на территориальном, региональном и федеральном уровнях", утвержденные руководителем Федеральной службы по надзору в сфере защиты прав потребителей и благополучия человека, Главным государственным санитарным врачом Российской Федерации 18.06.2012 (далее - МУК 4.2.3019-12).
Передача выделенной культуры для дальнейшей идентификации в специализированную лабораторию возможна на любом этапе исследования <8>.
--------------------------------
<8> МУК 4.2.3019-12.
19.1. L. monocytogenes относится к роду Listeria. Представители рода Listeria представляют собой грамположительные короткие палочки, размером 0,4 - 0,5 на 0,5 - 2,0 мкм, с закругленными концами, иногда почти кокки, одиночные или в коротких цепочках, реже в длинных нитях. Спор и капсул не образуют, некислотоустойчивы. Факультативный анаэроб, хемоорганоавтотроф, во внешней среде они являются хемолитоавтотрофами. Ферментируют глюкозу, каталазоположительны, оксидазоотрицательны. Листерии высоко устойчивы во внешней среде, растут в широком диапазоне pH (от 4,0 - 4,8 до 9,5 - 10,0), в присутствии NaCl (20%) и 15% CO2.
Оптимальная температура роста для листерии плюс 30 - 37 °C, хотя листерии могут расти и при комнатной температуре 20 - 25 °C, и при температуре плюс 4 °C, и даже при температуре 44 - 45 °C. Микроорганизмы, выросшие при температуре 20 - 25 °C подвижны за счет немногочисленных перитрихиально расположенных жгутиков. При температуре 37 °C жгутики, как правило, не образуются, и листерии неподвижны.
19.2. Значение показателя.
L. monocytogenes патогенны не только для человека, но и для животных, вызывает различные формы листериоза.
Листерии широко распространены в разных экологических системах, в том числе и в водных. При оптимальных условиях эти бактерии сохраняют жизнеспособность в воде до 737 дней. Листерии обладают уникальной возможностью размножаться при очень низкой температуре воды. Микроорганизм выделяют из сточных и поверхностных вод.
Определение L. monocytogenes проводят в воде по эпидпоказаниям с целью подтверждения их отсутствия/присутствия в 1 дм3 воды.
19.3. Определение L. monocytogenes титрационным способом.
Посевной объем пробы воды составляет 1000 см3.
Для посева используют 2 объема воды по 250 см3, 4 объема по 100 см3, 10 объемов по 10 см3, при этом воду засевают сразу в среды накопления и инкубируют при температуре (30 +/- 1) °C в течение 24 - 48 ч. Для накопления листерии используют селективный накопительный бульон UVM, бульон Фрейзера, питательный бульон для выделения листерии (ПБЛ-1).
19.4. Определение L. monocytogenes мембранным способом.
Пробу воды делят на 4 объема по 250 см3, для более легкого прохождения воды через фильтры. При видимом загрязнении образец можно поделить на 5 и (или) 10 равных частей. Воду фильтруют (приложение 3 к настоящим МУК). После фильтрации мембранные фильтры вносят в 50 - 100 см3 среды накопления и инкубируют в термостате при температуре (30 +/- 1) °C в течение 24 - 48 ч.
Бактерии рода Listeria при селективном обогащении в бульоне UVM, ПБЛ-1 через 24 и 48 ч инкубации при температуре (30 +/- 1) °C вызывают незначительное диффузное помутнение среды (рис. 1 А приложения 16 к настоящим МУК). При росте листерий в бульоне Фрейзера, содержащем эскулин и цитрат железа аммонийного, отмечается почернение среды за счет гидролиза эскулина (рис. 1 А, рис. 1 Б приложения 16 к настоящим МУК).
Дальнейшие этапы исследования для титрационного и фильтрационного способов одинаковы: после предварительного обогащения проводят пересев 0,1 см3 материала в 10 см3 среды для вторичного накопления с последующей инкубацией при температуре (37 +/- 1) °C в течение 24 - 48 ч в среду ПБЛ-2 (селективная среда для обогащения) или в бульон Фрейзера 2 или бульон UVM.
Высевы проводят при наличии и отсутствии признаков бактериального роста как со среды предварительного селективного (первичного), так и вторичного обогащения.
Материал отбирается из верхнего слоя питательной среды микробиологической петлей на селективно-диагностические питательные среды (например, ПАЛ, ПАЛКАМ агар, ALOA агар по Оттавиани и Агости). На среде ПАЛ/ПАЛКАМ агар при температуре (37 +/- 1) °C через 24 ч инкубирования листерий формируют мелкие, серовато-зеленые или оливково-зеленые колонии, диаметром 0,5 - 1,0 мм (рис. 2 А приложения 16 к настоящим МУК). Через 48 ч колонии заметно увеличиваются в диаметре до 1,0 - 2,0 мм и окружены черным ореолом.
Выделение листерий на ПАЛКАМ агаре основано на их способности гидролизовать эскулин с образованием эскулетина, который в присутствии ионов железа образует серо-зеленый комплекс с почернением среды вокруг колоний. За счет внесения селективной добавки: полимиксина, акрифлавина, цефтазидима, а также присутствия в составе хлорида лития, среда обладает высокими селективными свойствами по отношению к сопутствующей микрофлоре. На среде ALOA - агаре Listeria по Оттавиани и Агости L. monocytogenes формировали сине-зеленые колонии, окруженные непрозрачным ореолом (наличие фосфолипазной активности), рост L. innocua сопровождался образованием сине-зеленых колоний без зоны помутнения (рис. 2 А, 2 Б, 2 В приложения 16 к настоящим МУК).
При отсутствии роста на чашках с дифференциально-диагностическими средами анализ прекращают и дают заключение об отсутствии L. monocytogenes в исследуемой пробе воды в документе о результатах проведенного исследования (например, протокол, отчет) записывают: "L. monocytogenes в 1000 см3/1 дм3 не обнаружена".
При обнаружении характерного роста на чашках отбирают 3 - 5 колоний для их дальнейшего изучения.
Отобранные колонии пересевают в одну из сред: простой питательный агар с 1% глюкозы, триптон-соевый агар, триптон-соевый агар с дрожжевым экстрактом для получения изолированных колоний. Посевы термостатируют при температуре (30 +/- 1) °C в течение 24 ч.
19.5. Идентификация выделенных культур.
Для определения принадлежности выделенных микроорганизмов к роду Listeria полученные на средах культивирования чистые культуры микроскопируют по Граму. Бактерии рода Listeria являются грамположительными тонкими короткими палочками, спор не образуют. Определяют наличие каталазы, подвижность при двух температурах инкубирования (25 +/- 1) °C и (37 +/- 1) °C.
Каталазную активность культур определяют по способности каталазы разлагать перекись водорода с выделением пузырьков газа. Реакцию ставят с суточной культурой на стерильном предметном стекле.
Изолированную колонию, взятую с поверхности питательной среды, растирают на стекле и пипеткой наносят каплю 3%-го раствора перекиси водорода. Если через 30 - 60 сек на стекле появляются пузырьки газа, то считают результаты реакции положительными. Бактерии рода Listeria являются каталазоположительными.
Подвижность культур определяют посевом уколом в 0,4% полужидкий агар, инкубируют при двух температурах (25 +/- 1) °C и (37 +/- 1) °C в течение 48 - 72 ч.
Бактерии рода Listeria подвижны при (25 +/- 1) °C (образуют характерный рост вокруг линии укола, похожий на зонтик) и неподвижны (или слабоподвижны) при температуре (37 +/- 1) °C.
Обнаружение в посевах грамположительных коротких тонких палочек, каталазоположительных, подвижных при температуре 25 °C и неподвижных при температуре 37 °C, указывает на принадлежность выделенных на дифференциально-диагностических средах культур с характерной морфологией к роду Listeria.
Для подтверждения принадлежности выделенных листерии к виду L. monocytogenes определяют способность к ферментации маннозы, рамнозы, ксилозы, маннита, наличие лецитиназной и бета-гемолитической активности.
Для видовой дифференциации выделенных культур листерии допускается использовать среды Гисса, коммерческие тест-системы согласно рекомендациям изготовителя (рис. 4 приложения 16 к настоящим МУК).
L. monocytogenes утилизируют рамнозу и маннозу с образованием кислоты и не утилизируют ксилозу и маннит.
Бета-гемолитическую активность исследуемых культур определяют по образованию зон просветления за счет растворения эритроцитов вокруг колоний при посеве на поверхность кровяного агара, приготовленного с добавлением стерильной дефибринированной крови барана или кролика. Посевы на кровяном агаре термостатируют при температуре (37 +/- 1) °C в течение 24 ч. Listeria monocytogenes обладают бета-гемолитической активностью (образуют узкие четкие зоны просветления вокруг колоний).
Для определения лецитиназной активности дно двух чашек Петри со средой ГРМ N 1, содержащих: 1 чашка - желток куриного яйца и активированный уголь, 2 чашка - желток куриного яйца без активированного угля - делят на несколько секторов или квадратов, исследуемые культуры и контрольные штаммы листерии пересевают параллельно короткими штрихами на соответствующие секторы чашек, содержащих и не содержащих уголь. Инкубируют 48 ч при температуре (37 +/- 1) °C. Чашки просматривают в проходящем свете, сравнивая с контрольными высевами музейных штаммов. Listeria ivanovii дает плотную зону помутнения шириной 3 - 6 мм независимо от присутствия активированного угля. Listeria monocytogenes дает аналогичную зону помутнения в присутствии активированного угля и не дает при отсутствии угля. Другие виды листерии не дают зоны помутнения.
Допускается проведение идентификации выделенных возбудителей методом MALDI-TOF MS.
19.6. Учет результатов.
В образце воды констатируют присутствие Listeria monocytogenes, если при посеве на селективные среды выделены короткие неспорообразующие грамположительные палочки, каталазоположительные, подвижные при температуре (25 +/- 1) °C и неподвижные при температуре (37 +/- 1) °C, утилизирующие эскулин, сбраживающие с образованием кислоты рамнозу и не сбраживающие маннит и ксилозу, обладающие бета-гемолитической активностью и лецитиназной активностью на среде ГРМ N 1 с добавлением желтка куриного яйца и в присутствии активированного угля. При расшифровке эпидемиологических вспышек можно учитывать положительные результаты экспресс-тестов (ИХТ-тесты, Латекс-агглютинация, ПЦР), с последующим выделением чистой культуры.
При обнаружении Listeria monocytogenes в документе о результатах проведенного исследования (например, протокол, отчет) записывают: "L. monocytogenes в 1000 см3/1 дм3 обнаружена".
20.1. Candida albicans - дрожжеподобные грибы, в их культурах можно выявлять дрожжевые клетки, гифы, ростовые трубки и несептированный псевдомицелий. Кандиды хорошо растут как на простых, так и на обогащенных (кровь, сыворотка) средах при температуре (30 +/- 1) °C. Candida albicans способна ферментировать глюкозу и мальтозу с образованием кислоты и газа, при росте в жидких белковых средах через 2 - 4 ч образуют особые выросты - ростовые трубки, при культивировании при температуре (22 +/- 3) °C на голодных средах образует хламидоспоры.
20.2. Candida albicans вызывает кандидозы, это антропогенный микоз, характеризующийся поражением слизистых оболочек и кожи. Кандидозы возникают обычно у лиц с иммунологически опосредованной резистентностью организма. При обнаружении грибов Candida albicans в воде бассейна применяют меры для надежного обеззараживания воды.
20.3. Выполнение исследования качественным методом.
20.3.1. Объем 100 см3 исследуемой воды плавательного бассейна или воды аквапарка засевают в 10 см3 концентрированного бульона Сабуро. Для подавления роста сопутствующей бактериальной микрофлоры можно применять пенициллин и стрептомицин из расчета (50 - 100) ед./см3 среды или 0,05% хлорамфеникола.
Посевы инкубируют при температуре (30 +/- 1) °C до 10 суток, ежедневно просматривая посевы. Из засеянных емкостей при помутнении среды производят высев бактериологической петлей на чашки Петри с агаром Сабуро, агаром Сабуро с добавками антибиотиков и агаром Сабуро с ТТХ для подавления посторонней микрофлоры или на хромогенную питательную среду.
Инкубируют посевы при температуре (30 +/- 1) °C от 24 ч до 3 суток. При наличии роста на поверхности агаризированной среды Сабуро колоний средних размеров беловато-кремовых, блестящих гладких с ровными краями, проводят микроскопию и видовую идентификацию выделенных культур. При подтверждении принадлежности к C. albicans в документе о результатах проведенного исследования (например, протокол, отчет) записывают "Candida albicans в 100 см3 обнаружена".
20.3.2. Определение хламидоспор.
Для выявления псевдомицелия колонии отсевают в глюкозный питательный бульон, картофельную воду. Сначала появляется муть или осадок, реже пленка на поверхности среды, поднимающееся по стенке пробирки над поверхностью среды кольцо. Псевдомицелий обнаруживается в раздавленной капле на 3 - 5 день. На терминальных нитях псевдомицелия образуются хламидоспоры - двухконтурные круглые структуры диаметром 10 - 20 мкм, бластоспоры появляются в результате почкования, располагаются нерегулярно с обеих сторон псевдомицелия. Подавляющее большинство штаммов Candida albicans выявляют путем наличия характерного морфологического признака этого вида - хламидоспор. С этой целью производят прерывистый посев культуры на рисовый агар или кукурузный агар, часть посева покрывают фламбированным покровным стеклом. Посевы инкубируют при температуре (22 +/- 3) °C. Через 12 - 24 ч, реже 24 - 48 ч Candida albicans образует хламидоспоры. Посевы рассматривают под малым увеличением микроскопа непосредственно на чашке. Отмечают филаментацию, тип микроколоний. Выявление хламидоспор позволяет идентифицировать культуру как Candida albicans и не проводить дальнейших исследований в документе о результатах проведенного исследования (например, протокол, отчет) записывают "Candida albicans в 100 см3 обнаружена".
20.3.3. Выявление ростовых трубок.
У вирулентных штаммов Candida albicans имеется способность образовывать ростковые трубки. Колонию грибов инокулируют в 0,1 см3 сыворотки крови человека или животного, инкубируют при температуре (37 +/- 1) °C в течение 3 - 4 ч. Наличие трубок роста определяют под микроскопом (20 - 40 кратное увеличение, без иммерсии). Трубки роста, характерные для Candida albicans, представляют собой нитевидные образования. После суточной инкубации трубки роста в виде нитевидных образований уже не определяются.
Культуры, у которых хламидоспоры и ростовые трубки выявить не удалось, исследуют по комплексу признаков. Определяют биохимическую активность (концентрация углеводов должна быть 2%). Для ускорения процесса рекомендуется введение в среды агар-агара (0,1 - 0,15)%, при этом срок наблюдения сокращается до 2 дней. Candida albicans ферментирует глюкозу, сахарозу, мальтозу, галактозу, трегалозу до кислоты и газа, не разлагает лактозу. Для биохимической идентификации допускается использование хромогенных сред, автоматических анализаторов, коммерческих тест-систем в соответствии с инструкцией производителя.
Допускается проведение идентификации выделенных возбудителей методом MALDI-TOF MS.
20.4. Количественный метод.
Исследуется 100 см3 исследуемой воды мембранным методом.
Фильтрацию пробы производят с помощью мембранных фильтров (приложение 3 к настоящим МУК).
Фильтр с посевами помещают на среду агар Сабуро с хлорамфениколом, инкубацию посевов производят при температуре (25 +/- 1) °C в течение (45 +/- 3) ч. При наличии на фильтре выпуклых колоний белого цвета с ровными краями, диаметром 2 - 3 мм, проводят микроскопию и подсчитывают колонии C. albicans. При наложении фильтра на хромогенную среду (хромогенный агар для грибов Candida) инкубацию посевов производят при температуре 30 - 37 °C в течение (45 +/- 3) ч. При этом вырастают колонии средних размеров зеленого цвета с ровными краями - C. albicans; колонии голубые с металлическим акцентом - C. tropicalis; колонии розовые, нечеткие - C. krusei. Специфичность определения C. albicans и C. tropicalis составляет 99%, последующая дифференциация не требуется. Производят подсчет колоний Candida albicans в документе о результатах проведенного исследования (например, протокол, отчет) записывают: "Candida albicans X КОЕ/100 см3".
к МУК 4.2.3963-23
1.1. Оборудование <9>
--------------------------------
<9> Примечание: допускается использование средств измерений, вспомогательного и испытательного оборудования, с аналогичными или лучшими метрологическими и техническими характеристиками.
1. Автоматическая средоварка с разливочным модулем.
2. Автоматические дозаторы различных объемов одноканальные и многоканальные.
3. Анаэростат или анаэробная станция.
4. Батометр с устройством для закрепления стерильных емкостей или прибор с аналогичными характеристиками.
5. Батометр специальный для отбора проб с разных глубин.
6. Вакуумный насос для создания вакуума в фильтровальных вакуумных системах.
7. Весы лабораторные общего назначения, допустимая погрешность 0,001 г.
8. Весы лабораторные общего назначения, допустимая погрешность 0,01 г.
9. Весы лабораторные общего назначения, с пределом взвешивания до 1000 г, допустимая погрешность не более 0,1 г.
10. Водяная баня или термостат для температурного режима 45 - 75 °C.
11. Встряхиватель.
12. Горелки газовые или спиртовки.
13. Денситометр или оптический стандарт мутности на 5 МЕ и 10 МЕ.
14. Дистиллятор.
15. Дозатор пипеточный электрический объемом от 0,1 до 100 см3 (показатель точности).
16. Иммуноферментный анализатор.
17. Ламинарный шкаф (бокс биологической безопасности класса II).
18. Логгеры (мониторинг температуры в термостате и холодильном оборудовании, аттестованные) от минус 35 °C до плюс 55 °C.
19. Лупа.
20. Магнитная мешалка.
21. Микроскоп стереоскопический, обеспечивающий увеличение от 3,5 до 119x, с полем зрения 39 - 1,9 мм.
22. Микроскоп, обеспечивающий увеличение от 40 крат до 1500 крат.
23. Микроцентрифуга для микроцентрифужных пробирок до 16000g.
24. Микроцентрифуга для пробирок со скоростью вращения 10000 - 16000 об/мин.
25. Морозильная камера с температурой в камере минус 20 °C.
26. Морозильная камера с температурой в камере минус 70 °C.
27. Оборудование для измерения показателей микроклимата помещений.
28. Оборудование для мембранной фильтрации под вакуумом с диаметром фильтрующей поверхности 35, 37, 47 мм и устройства для создания разрежения 0,5 - 1,0 атм.
29. Оборудование для обжигания петель или зажигалка.
30. Оборудование для подсчета количества клеток.
31. Пистолет для фламбирования.
32. Прибор для промывки плашек.
33. PH-метр.
34. CO2-инкубатор, обеспечивающий температуру до плюс 50 °C.
35. Стерилизатор паровой, режим работы от 0 до 2,5 кгс/см3.
36. Стерилизатор суховоздушный.
37. Термометр ртутный с диапазоном измерения от 0 до 200 °C с ценой деления шкалы 1 °C и 0,25 °C.
38. Термометр ртутный с диапазоном измерения от 0 до 50 °C с ценой деления шкалы 0,5 °C.
39. Термометр спиртовой с диапазоном измерения от минус 50 °C до плюс 50 °C с ценой деления шкалы 1 °C для измерения температуры в холодильниках или логгеры.
40. Термостаты, поддерживающие рабочую температуру (37 +/- 1) °C, (41,5 +/- 1) °C, (42 +/- 1) °C, (44 +/- 1) °C, (44 +/- 0,5) °C, (30 +/- 1) °C, (25 +/- 1) °C, (22 +/- 1) °C, (22 +/- 3) °C.
41. Ультрафиолетовая лампа, длина волны излучения (360 +/- 20) нм.
42. УФ-облучатели открытого типа и (или) Дезары.
43. Фармацевтические холодильники с диапазоном контроля температур 2 - 15 °C.
44. Фингер (пипетатор) для пипеток объемом 2 см3.
45. Холодильники с температурой в камере 4 - 6 °C.
46. Центрифуга лабораторная от 1000 до 6000 оборотов.
47. Центрифуга-вортекс.
48. Шейкер-термостат.
49. Металлический скребок (совок).
50. Пешни.
1.2. Расходные материалы <10>
--------------------------------
<10> Примечание: допускается применение расходных материалов с аналогичными или лучшими техническими характеристиками.
1. Алюминиевая фольга.
2. Бутыли Вульфа от 10 л.
3. Воронки конические стеклянные разных объемов.
4. Груши, фингеры или автоматический дозатор для серологических пипеток.
5. Емкости для отбора проб однократного или многократного применения вместимостью 500 см3; 1000 см3 и другое оборудование, необходимое для отбора проб воды.
6. Емкости стеклянные или эмалированные для приготовления сред.
7. Вата хлопчатобумажная гигроскопическая медицинская.
8. Емкость с дезинфицирующим раствором.
9. Корнцанг.
10. Марля медицинская.
11. Бумага фильтровальная.
12. Маркер по стеклу.
13. Герметичные контейнеры или мешки для сбора и хранения отработанного материала.
14. Средства защиты (очки для защиты глаз от УФ-излучения, латексные перчатки, маски и шапочки одноразового использования).
15. Средство дезинфекционное, допущенное к применению в установленном порядке.
16. Мембранные фильтры для микробиологических целей с диаметром пор не более 0,45 мкм и размером диска 35 или 47 мм или другие фильтрующие мембраны с аналогичной способностью фильтрации.
17. Мерные стаканы.
18. Микроцентрифужные пробирки объемом 1,5 см3; 0,5 см3; 0,2 см3.
19. Одноразовые наконечники для автоматических дозаторов с аэрозольным барьером и без разных объемов.
20. Петли бактериологические.
21. Палочки стеклянные.
22. Ножницы.
23. Пинцет анатомический.
24. Пипетки серологические на 1 см3; 5 см3; 10 см3; 25 см3.
25. Полоски реактивные бумажные для определения индола.
26. Посуда мерная лабораторная стеклянная 2-го класса точности вместимостью 500 и 1000 см3.
27. Пробирки лабораторные 15 см3; 20 см3.
28. Пробки силиконовые разных размеров.
29. Сменные одноразовые наконечники с аэрозольными фильтрами и без.
30. Спиртовки стеклянные или металлические с подставкой.
31. Стерилизационные пакеты.
32. Стерильные гибкие шланги разной длины с переходниками для закрепления к водопроводам.
33. Флаконы стеклянные объемом 100; 250 и 500 см3.
34. Цилиндры стеклянные на 100 см3; 250 см3; 1000 см3.
35. Чашки Петри диаметром 90 мм; 100 мм.
36. Шланги резиновые для колонок и компрессора разных диаметров.
37. Шпагат.
38. Шпатели.
39. Шприцы трехсоставные стерильные на 20 см3.
40. Штативы для микроцентрифужных пробирок 1,5 см3; 0,5 см3.
41. Штативы для пробирок.
42. Пакеты для создания микроаэробной атмосферы.
1.3. Реактивы <11>
--------------------------------
<11> Примечание: рекомендуется использовать реактивы наивысшей чистоты (о.с.ч. - особо чистый); допускается использование реактивов с аналогичными или лучшими техническими характеристиками.
1. 2,3,5-Трифенилтетразолиум хлорид (ТТХ), с массовой долей основного вещества - не менее 99,5%.
2. L-Триптофан, с массовой долей основного вещества - не менее 98%.
3. Бриллиантовый зеленый, с массовой долей основного вещества - не менее 98%.
4. Бромтимоловый синий с массовой долей основного вещества - не менее 98%.
5. Вода дистиллированная.
6. Гептадецилсульфат натрия (тергитол 7), с массовой долей основного вещества - не менее 98%.
7. Калий фосфорнокислый однозамещенный.
8. Кислота ортофосфорная.
9. Кислота соляная.
10. Магний хлористый 6-водный.
11. Натрий серноватистокислый.
12. Натрий хлористый.
13. D-Глюкоза.
14. Теллурит калия 2%.
15. Натрия азид.
16. Нафтол для приготовления оксидазного реактива при использовании диметил-п-фенилендиаминдигидрохлорида, с массовой долей основного вещества - не менее 98%.
17. Пара-диметиламинобензальдегид, с массовой долей основного вещества - не менее 99,2%.
18. Реактив для индольного теста.
19. Реактив Ковача.
20. Системы индикаторные бумажные для проведения оксидазного теста (диски или полоски).
21. Спирт этиловый ректификованный 95 - 96%-й.
22. Сыворотки диагностические сальмонеллезные адсорбированные сухие: O-поливалентная ABCDE, O-, H- и Vi- для реакции агглютинации.
23. Тетраметил-п-фенилендиамин гидрохлорид или диметил-п-фенилендиаминдигидрохлорид, с массовой долей основного вещества - не менее 99%.
24. Физиологический раствор 0,9%.
к МУК 4.2.3963-23
РАСТВОРЫ ДЛЯ РАЗБАВЛЕНИЙ И ПИТАТЕЛЬНЫЕ СРЕДЫ <12>
--------------------------------
<12> Примечание: в лабораториях допускается использовать среды и реактивы (в том числе медицинские и ветеринарные препараты) коммерческие, промышленного производства, лабораторного изготовления с характеристиками не хуже указанных в настоящих МР и разрешенных к применению на территории Российской Федерации.
Солевой (физиологический) раствор
1.1. В 1 л дистиллированной воды растворяют 8,5 г хлорида натрия, устанавливают pH с расчетом, чтобы после стерилизации pH = (7,0 +/- 0,1). Разливают во флаконы, стерилизуют при температуре 121 °C в течение 15 мин. Разливают мерно непосредственно перед посевом.
Срок хранения - до 1 месяца при комнатной температуре. В укупоренном виде.
Пептонный раствор
1.2. В 1 л дистиллированной воды растворяют при кипячении 10,0 г пептона. Устанавливают pH с расчетом, чтобы после стерилизации pH = (7,0 +/- 0,1). Разливают во флаконы. Стерилизуют при температуре 121 °C в течение 20 мин. Разливают мерно непосредственно перед посевом.
Срок хранения - до 1 месяца при комнатной температуре.
Пептонно-солевой раствор
1.3. В 1 л дистиллированной воды растворяют при кипячении 8,5 г хлорида натрия и 1 г пептона. Устанавливают pH с расчетом, чтобы после стерилизации pH = (7,0 +/- 0,1). Стерилизуют при температуре 121 °C в течение 20 мин. Разливают мерно непосредственно перед посевом.
Срок хранения - до 1 месяца при комнатной температуре.
Вода пептонная забуференная
1.4. Состав:
- пептон ....................................................... 10,0 г
- натрий хлористый .............................................. 5,0 г
- натрий фосфорнокислый двузамещенный 12-водный ................. 9,0 г
- калий фосфорнокислый однозамещенный ........................... 1,5 г
- вода дистиллированная ...................................... 1000 см3
При нагревании компоненты растворяют в воде; pH после стерилизации (7,0 +/- 0,1) при температуре 25 °C. Разливают среду во флаконы, подходящей вместимости. Стерилизуют в течение 15 мин при температуре 121 °C в автоклаве.
Питательный бульон
1.5. Готовят из сухой питательной среды промышленного производства согласно инструкции производителя.
Питательный бульон (десятикратный) для определения колифагов готовят путем увеличения в 10 раз навески сухого препарата, указанного на этикетке.
Полужидкий питательный агар
1.6. Полужидкий питательный агар готовят с использованием одной трети навески сухого препарата в соответствии с инструкцией производителя. Разливают в пробирки и автоклавируют при температуре 121 °C в течение 20 мин.
Питательный агар
1.7. Готовят из сухой питательной среды промышленного производства согласно инструкции производителя.
Питательный агар не допускается выдерживать в расплавленном состоянии более 8 ч. Оставшийся неиспользованным агар повторному расплавлению не подлежит.
Питательный агар для определения колифагов прямым методом при посеве 20 см3 пробы на чашку Петри готовят, увеличивая навеску сухого препарата на 10 - 15% от прописи. Разливают в емкости, автоклавируют при температуре 121 °C в течение 20 мин.
ГРМ-агар
1.8. Готовят и хранят по инструкции, указанной на этикетке производителя.
Глюкозо-пептонная среда
1.9. Готовят из сухой питательной среды промышленного производства согласно инструкции производителя.
Для приготовления концентрированной глюкозо-пептонной среды все ингредиенты, кроме воды, увеличивают в 10 раз, разливают по 1 см3 в пробирки и по 10 см3 во флаконы.
Готовую среду стерилизуют при температуре 112 °C в течение 12 мин.
Лактозо-пептонная среда
1.10. Готовят из сухой питательной среды промышленного производства согласно инструкции производителя.
Для приготовления концентрированной лактозо-пептонной среды все ингредиенты, кроме воды, увеличивают в 10 раз, разливают по 1 см3 в пробирки и по 10 см3 во флаконы.
Готовую среду стерилизуют при температуре 112 °C в течение 12 мин.
Среда Эндо
1.11. Готовят из сухой питательной среды промышленного производства согласно инструкции производителя.
Фуксин-сульфитная среда Эндо
1.12. Основная модификация.
Готовят из сухого препарата по способу, указанному на этикетке. Если на поверхности среды заметны следы влаги, чашки перед посевом необходимо подсушить. Срок хранения чашек со средой не более 2 - 3 суток в темноте, если производителем не оговорены другие сроки.
1.12.1. Повышение дифференцирующих свойств среды.
Для повышения дифференцирующих свойств среды в готовую и охлажденную до температуры 45 - 50 °C среду перед разливом в чашки допускается прибавлять на 100 мл среды 0,2 мл 5%-го спиртового раствора основного фуксина. Срок хранения раствора фуксина - не более 1 мес.
1.12.2. Модификация среды с добавлением розоловой кислоты.
В случае роста микрофлоры, не относящейся к бактериям кишечной группы, помимо фуксина, допускается добавление на 100 мл среды Эндо 0,2 мл 5%-го спиртового раствора розоловой кислоты. Срок хранения раствора розоловой кислоты - не более 1 месяца.
Модификацию среды Эндо с добавлением розоловой кислоты используют только при работе методом мембранной фильтрации.
Среда Эндо с розоловой кислотой
1.13. К среде Эндо, помимо фуксина, допускается добавление на 100 мл среды Эндо 0,2 мл 5%-го спиртового раствора розоловой кислоты. Ингибирует рост микрофлоры, не относящейся к бактериям кишечной группы. Срок хранения раствора розоловой кислоты - не более 1 месяца.
Лактозный агар с тергитолом-7 и ТТХ
1.14. Готовят из сухой питательной среды промышленного производства согласно инструкции производителя.
Готовую среду охлаждают на водяной бане до 45 - 50 °C и добавляют приготовленного на стерильной дистиллированной воде 5 см3 0,05% водного раствора ТТХ на 100 см3 основной среды. Хорошо перемешивают и разливают в чашки слоем не менее 5 мм.
Раствор ТТХ и питательная среда устойчивы в течение недели при температуре 2 - 8 °C в защищенном от света месте.
Хромокульт колиформ агар
1.15. Готовят из сухой питательной среды промышленного производства согласно инструкции производителя.
Нагревают на кипящей водяной бане, периодически помешивая, до полного растворения в течение 35 мин. Не автоклавировать, не перегревать. Готовую среду охлаждают до 45 - 50 °C и разливают в чашки Петри.
Питательная среда устойчива в течение 2 недель при температуре 2 - 8 °C в защищенном от света месте. Для предотвращения от высыхания поместить чашки со средой в пластиковые мешки.
Лактозный бульон с борной кислотой
1.16. Растворяют в 1 л дистиллированной воды:
- пептона ....................................................... 10 г;
- калия фосфорнокислого двузамещенного (безводного) ........... 12,2 г;
- калия фосфорнокислого однозамещенного (безводного) ........... 4,1 г;
- борной кислоты <13> .......................................... 3,2 г;
- лактозы ...................................................... 5,0 г.
--------------------------------
<13> Примечание: каждую новую партию борной кислоты следует испытывать; при выращивании E. coli при температуре 44 °C среда дает положительную реакцию - помутнение и газ.
После растворения всех ингредиентов при нагревании, среду остужают до комнатной температуры и разливают по 5 см3 в пробирки с поплавками или комочками ваты, стерилизуют при температуре 112 °C в течение 12 мин.
Срок хранения не более 2 недель.
Среда с триптофаном
1.17. Растворяют в 1 л дистиллированной воды:
- ферментативного пептона ..................................... 10,0 г;
- хлористого натрия ............................................ 5,0 г;
- триптофана растворяют ........................................ 1,0 г.
Устанавливают pH - 7,2, разливают в стерильные пробирки и автоклавируют при температуре (120 +/- 2) °C в течение 20 мин.
Питательная среда для селективного определения колиформных
бактерий и E. coli сухая (EC-бульон)
1.18. Готовят из сухой питательной среды промышленного производства согласно инструкции производителя.
Питательные среды для подтверждения способности
ферментировать лактозу, глюкозу до кислоты и газа
и образовывать индол
Полужидкая среда с глюкозой из сухого препарата
2.1. Готовят из сухой питательной среды промышленного производства согласно инструкции производителя.
Срок хранения не более 2 недель при комнатной температуре. В холодильнике не хранить.
Посев производят уколом до дна пробирки. Полужидкие среды позволяют улавливать небольшое количество газа и на ранних стадиях ферментации, что повышает чувствительность метода и скорость получения ответа через 4 - 6 ч.
Триптонный агар с желчью и X-глюкуронидом
2.2. Готовят из сухой питательной среды промышленного производства согласно инструкции производителя.
Питательная среда устойчива в течение 4 недель при температуре 2 - 8 °C в защищенном от света месте. Для предотвращения от высыхания поместить чашки со средой в пластиковые мешки.
Триптон-желчный агар (ТЖА)
2.3. Готовят из сухой питательной среды промышленного производства согласно инструкции производителя.
Неселективный триптон-соевый агар (ТСА)
2.4. Готовят из сухой питательной среды промышленного производства согласно инструкции производителя.
Коммерческая среда EC-бульон (селективная) для обнаружения
и определения количества бактерий E. coli
2.5. Готовят из сухой питательной среды промышленного производства согласно инструкции производителя.
Среда с хлоридом трифенилтетразола (ТТХ)
2.6. Состав:
- пептон ....................................................... 2,0 г;
- дрожжевой экстракт
из пекарских дрожжей ....................... 15,0 см3 или сухого 0,3 г;
- двузамещенный фосфат калия ................................... 0,2 г;
- ТТХ .......................................................... 0,8 г;
- воды дистиллированной ................................. до 100,0 см3.
Стерилизация при 0,5 атм в течение 15 минут.
10% водный раствор ТТХ в дистиллированной воде.
Щелочно-полимиксиновая среда (ЩЕС)
2.7. Состав (обычная концентрация):
1) раствор 1:
- мясо-пептонный бульон ..................................... 70,0 см3;
- натрий хлористый ............................................. 0,5 г;
- глюкоза ...................................................... 1,0 г;
- дрожжевой экстракт .............................. 2,0 см3 (или 2 г).
2) раствор 2:
- вода дистиллированная ..................................... 15,0 см3;
- натрий углекислый ........................................... 0,53 г.
3) раствор 3:
- вода дистиллированная ..................................... 10,0 см3;
- натрий двууглекислый ........................................ 0,25 г.
Состав (удвоенная концентрация):
Растворы 1, 2 и 3 стерилизуют раздельно при температуре 112 °C в течение 12 мин. После стерилизации растворы смешивают, проверяют pH 10,0 - 10,2, прибавляют 20000 единиц полимиксина М, 0,5 см3 1,6%-го спиртового раствора бромтимолового синего, разливают в пробирки по 5 см3.
1) раствор 1:
- мясо-пептонный бульон ..................................... 70,0 см3;
- натрий хлористый ............................................. 1,0 г;
- глюкоза ...................................................... 2,0 г;
- дрожжевой экстракт ............................... 4,0 см3 (или 4 г).
2) раствор 2:
- вода дистиллированная ..................................... 15,0 см3;
- натрий углекислый ............................................ 1,1 г.
3) раствор 3:
- вода дистиллированная ..................................... 10,0 см3;
- натрий двууглекислый ......................................... 0,5 г.
В среду удвоенной концентрации добавляют 40000 единиц полимиксина М и 1 см3 бромтимолового синего. Разливают в колбы или флаконы по 10, 50 и 100 см3 соответственно количеству исследуемой воды.
Молочно-ингибиторная среда (МИС)
2.8. Готовят 2,5%-й мясо-пептонный агар. К 85 см3 готового питательного агара, охлажденного до температуры 45 - 50 °C, добавляют 15 см3 стерильного обезжиренного (0,5% жирности) молока, 1,25 см3 0,01%-го водного раствора кристаллического фиолетового, 1 см3 2%-го водного раствора теллурита калия (pH 7,0 +/- 0,2).
Все хорошо смешивают и разливают тонким слоем в чашки Петри.
Азидная среда Сланеца-Бертли
2.9. Сухой питательный агар промышленного производства готовят по указанию на этикетке, 4 г калия фосфорнокислого однозамещенного расплавляют при нагревании в 1000 см3 дистиллированной воды, устанавливают pH 7,0, разливают мерно в емкости, стерилизуют при температуре 121 °C в течение 20 мин.
Перед употреблением в расплавленный и слегка остуженный агар добавляют из расчета на 100 см3 среды:
- дрожжевого экстракта ....................................... 2,0 см3;
- глюкозы ...................................................... 1,0 г;
- азида натрия ................................................ 0,04 г;
- 1%-го водного раствора 2,-3,-5-трифенил тетразолий
хлорида (ТТХ) .................................................. 1 см3.
Тщательно смешивают, разливают в чашки по 20 - 25 см3. Хранят в холодильнике не более 2 недель. Среду можно готовить перед употреблением без стерилизации в автоклаве.
Допускается использование коммерческой среды Сланеца-Бертли.
Питательная среда для выделения энтерококков
сухая - энтерококкагар
2.10. Готовят из сухой питательной среды промышленного производства согласно инструкции производителя.
Навеску тщательно размешивают в 1 дм3 воды дистиллированной, доводят до кипения и кипятят при постоянном помешивании в течение 1 мин, быстро охлаждают до температуры 45 - 50 °C и разливают в чашки Петри.
Минимальное время воздействия высокой температуры при приготовлении среды необходимо из-за наличия в среде ТТХ, который разлагается при нагревании.
Желчь-эскулин-азидный агар
2.11. Приготовление среды проводят из готового препарата в соответствии с инструкцией производителя. После приготовления среду охлаждают, медленно выливают в стерильные чашки Петри слоем 3 - 5 мм и оставляют для остывания на горизонтальной поверхности. Срок хранения - не более 14 сут в защищенном от света месте при температуре (5 +/- 3) °C.
Питательный агар со стрептомицином
2.12. Питательный агар со стрептомицином (или стрептомицина сульфатом для инъекций (англ. Streptomycini sulfas pro injectionibus)) готовят из расчета содержания 100 мкг стрептомицина на 1 см3 питательного агара, приготовленного по стандартной прописи. Раствор стрептомицина в концентрации 10 мг на 1 см3 готовят с использованием стерильной дистиллированной воды с соблюдением правил асептики. В готовый питательный агар, отмеренный по объему и остуженный до температуры 45 - 50 °C, вносят приготовленный стерильный раствор стрептомицина из расчета 0,1 см3 на 10 см3 питательного агара. Разливают в пробирки для приготовления скошенного агара.
Срок хранения питательного агара со стрептомицином не более 2 недель. Повторное расплавление питательной среды со стрептомицином запрещается.
Желточно-солевой агар (ЖСА)
2.13. Сухой питательный агар по прописи производителя и 65 г хлорида натрия растворяют при нагревании в 1000 см3 дистиллированной воды (pH 7,2 - 7,4), разливают мерно в емкости, стерилизуют при температуре 121 °C в течение 20 мин. Перед употреблением в расплавленный и остуженный до 50 - 55 °C солевой агар прибавляют один стерильно приготовленный яичный желток, тщательно смешанный с 50 см3 физиологического раствора с помощью стеклянных бус, перемешивают и разливают в чашки Петри тонким слоем по 12 - 15 см3 для подтверждающего этапа или толстым слоем по 20 - 25 см3 для выращивания на мембранных фильтрах.
Яично-желточно-солевой агар
2.14. 1 дм3 мясо-пептонного агара перед анализом расплавляют и растворяют в нем 95 г хлористого натрия, охлаждают до температуры 45 - 50 °C и добавляют 100 см3 яично-желточной взвеси. Смесь тщательно перемешивают и разливают в чашки Петри.
Чашки хранят в холодильнике не более 5 суток. Применяют для культивирования стафилококков.
Стафилококкагар
2.15. Сухой препарат промышленного производства (стафилококкагар) как солевую основу готовят по способу, указанному на этикетке производителя, с последующим добавлением желточной взвеси.
Среда Байрд-Паркера
2.16. Состав:
- пептон из казеина ........................................... 10,0 г;
- мясной экстракт .............................................. 5,0 г;
- экстракт дрожжей ............................................. 1,0 г;
- пируват натрия .............................................. 10,0 г;
- глицин ...................................................... 12,0 г;
- хлорид лития ................................................. 5,0 г;
- агар-агар ................................................... 15,0 г.
Приготовление: растворить ингредиенты в 0,95 дм3 воды, автоклавировать при температуре 121 °C в течение 15 минут, охладить до 45 - 50 °C и влить 50 см3 яично-желтковой эмульсии с теллуритом, при необходимости внести сульфаметазин в количестве 50 мг/дм3. pH (7,0 +/- 0,2) при температуре 25 °C. Среду разлить в чашки. Чашки имеют молочный отлив и желтовато-коричневый цвет. Хранить при температуре 4 °C до 1 месяца.
Железосульфитный агар
2.17. В 1000 см3 стерильного расплавленного питательного агара добавляют 10,0 г глюкозы, нагревают до растворения, разливают мерно во флаконы, автоклавируют при температуре 112 °C в течение 12 минут (основная среда).
20%-й раствор сульфита натрия (Na2SO3) и 8%-й раствор железа серно-кислого закисного (FeSO4) или железа хлористого (FeCl2) готовят непосредственно перед употреблением в стерильной посуде на стерильной дистиллированной воде.
Раствор сульфита натрия нагревают до полного растворения. Перед выполнением исследование в 100 см3 расплавленной основной среды вносят 5 см3 20%-го раствора сульфита натрия, перемешивают, затем вносят 1 см3 8%-го раствора серно-кислого железа, перемешивают и стерильно разливают в пробирки высоким столбиком 12 - 15 см для работы методом мембранной фильтрации или во флаконы для работы методом прямого посева.
Допускается использование коммерческой среды.
Агар для клостридий (усиленный)
2.18. Состав:
- мясной экстракт ............................................. 10,0 г;
- декстроза .................................................... 5,0 г;
- дрожжевой экстракт ........................................... 3,0 г;
- растворимый крахмал .......................................... 1,0 г;
- бактериологический агар ..................................... 12,5 г;
- пептон ...................................................... 10,0 г;
- хлорид натрия ................................................ 5,0 г;
- ацетат натрия ................................................ 3,0 г;
- L-цистеина гидрохлорид ....................................... 0,5 г.
Конечная величина pH (6,8 +/- 0,2) при температуре 25 °C. Развести 50 г среды в 1 литре дистиллированной воды. Хорошо перемешать и нагреть. Часто помешивая, довести до кипения. Кипятить в течение минуты до полного растворения. Разлить в емкости и стерилизовать 15 минут при температуре 121 °C. Охладить до 45 - 50 °C и при необходимости добавить 0,02 г/л полимиксина B в виде стерильного отфильтрованного раствора. Готовая среда имеет светло-янтарный цвет, слегка опалесцирует, должна храниться при температуре 8 - 15 °C.
Модифицированная среда для выделения клостридий
2.19. Состав (на 1 л дистиллированной воды):
- нутриент агар ................................................. 23 г;
- казеиновый пептон ............................................. 15 г;
- сульфит натрия ................................................. 1 г;
- дрожжевой экстракт ............................................ 10 г;
- сульфат железа ............................................... 0,5 г;
- декстроза ...................................................... 5 г;
- L-цистеин .................................................... 0,5 г;
- бриллиантовый зеленый 0,1%-ный водный раствор ................ 1 см3.
Агар триптозо-сульфит-циклосериновый
2.20. Основу питательной среды готовят следующим образом: 15,0 г триптозы, 5,0 г ферментативного пептона, 25 см3 дрожжевого экстракта, 1,0 г безводного тиосульфита натрия, 1,0 г цитрата аммонийного железа, 20,0 г агара растворяют в 1 дм3 кипящей дистиллированной воды. Устанавливают pH таким образом, чтобы после стерилизации он составлял при температуре 25 °C (7,6 +/- 0,1). Основу среды стерилизуют при температуре 121 °C в течение 20 минут и хранят при температуре (4 +/- 2) °C не более 14 сут.
К 100 см основы, расплавленной и охлажденной до температуры 45 - 50 °C, добавляют непосредственно перед употреблением 1 см3 раствора массовой концентрацией циклосерина 40 г/дм3. Допускается при отсутствии триптозы заменять ее равным количеством ферментативного пептона.
Агар сульфит-полимиксин-неомициновый
2.21. Основу питательной среды готовят следующим образом: 17,0 г ферментативного пептона, 15 см3 дрожжевого экстракта, 5,0 г хлорида натрия, 1,0 г безводного тиосульфита натрия, 1,0 г цитрата аммонийного железа, 12,0 - 15,0 г агара добавляют к 1 дм3 дистиллированной воды. Смесь, периодически перемешивая, подогревают до кипения и кипятят до полного растворения всех составных частей. Устанавливают pH таким образом, чтобы после стерилизации он соответствовал при температуре (25 +/- 1) °C (7,6 +/- 0,1). Стерилизуют при температуре 121 °C в течение 20 минут. Основу среды хранят при температуре (4 +/- 2) °C не более 14 сут.
К 1 дм3 основы, расплавленной и охлажденной до температуры (45 - 50) °C, непосредственно перед употреблением добавляют 1 см3 раствора массовой концентрации неомицина сульфата 50 г/дм3 или 5 см3 раствора массовой концентрации неомицина сульфата 10 г/дм3 (50 мкг/см3 основы среды) и 8 см3 раствора массовой концентрации полимиксина 2,5 г/дм3 или 4 см3 раствора массовой концентрацией полимиксина 5 г/дм3 (20 мкг/см3 основы среды).
Среда Мюллера-Кауфмана
2.22. В 500 см3 исследуемой воды вносят:
- 10%-го пептона .............................................. 25 см3;
- желчных солей ................................................ 0,5 г;
- кальция углекислого .......................................... 5,0 г;
- натрия тиосульфата .......................................... 15,0 г;
- 0,1%-го водного раствора бриллиантового зеленого ........... 0,5 см3;
- раствора Люголя ............................................. 10 см3.
Для приготовления раствора Люголя в 10 см3 воды вносят 3,0 г йода кристаллического и 2,5 г калия йодистого.
Селенитовая среда Лейфсона
2.23. Готовят из сухого препарата промышленного производства по указанию на упаковке.
Для приготовления селенитового бульона двойной концентрации увеличивают навеску сухого препарата в два раза на тот же объем дистиллированной воды.
Магниевая среда
2.24. Используют три способа приготовления магниевой среды: среда обычной или двойной концентрации, экспедиционная модификация и среда готовая к применению в соответствии с Инструкцией производителя.
Магниевую среду обычной и двойной концентрации готовят лабораторным способом.
При приготовлении среды обычной и двойной концентрации готовят раздельно растворы А, Б, В по нижеследующей прописи (табл. 2.1):
Растворы | Ингредиенты | Обычная концентрация на 1000 см3 | Удвоенная концентрация на 100 см3 |
Пептон ферментативный | 4,2 г | 0,84 г | |
Натрий хлористый | 7,0 г | 1,4 г | |
Калий фосфорнокислый однозамещенный | 1,5 г | 0,3 г | |
Дрожжевой экстракт жидкий или сухой | 22,0 см3 5,0 г | 4,4 см3 1,0 г | |
Вода дистиллированная | 890,0 см3 | 89,0 см3 | |
Магний хлористый кристаллический | 36,0 г | 7,2 г | |
Вода дистиллированная | 90,0 см3 | 9,0 см3 | |
Бриллиантовый зеленый 0,1%-й водный раствор | 5,0 см3 | 1,0 см3 |
Твердые фракции среды растворов А и Б вносят в дистиллированную воду, растворяют, кипятят в течение 10 мин. Затем растворы А, Б и В сливают в одну колбу.
Наилучшие результаты дает посев воды в магниевую среду по экспедиционной методике в оригинальной прописи и модификации.
Навески и растворы ингредиентов среды предварительно готовят в расфасованном виде, которые затем вносят в исследуемую воду в соответствии с нижеследующей прописью (табл. 2.2):
Ингредиенты на 500 см3 пробы воды | На 500 см3 пробы воды | На 100 см3 пробы воды |
1 | 2 | 3 |
Магний хлористый кристаллический | 19,5 г | 3,9 г |
Натрий хлористый | 4,0 г | 0,8 г |
Калий фосфорнокислый однозамещенный безводный | 0,8 г | 0,16 г |
10%-й раствор пептона | 25,0 см3 | 5,0 см3 |
Дрожжевой экстракт, приготовленный из пекарских дрожжей (жидкий) или сухой препарат | 11,0 см3 2,5 см3 | 2,5 см3 1,0 г |
Бриллиантовый зеленый - 0,1%-й водный раствор | 2,5 см3 | 0,5 см3 |
Каждую навеску ингредиента вносят последовательно после полного растворения предыдущего в небольшой объем исследуемой воды около 200 - 300 см3 по одному до полного растворения. После внесения всех ингредиентов в емкость вносят оставшийся объем исследуемой воды и тщательно перемешивают.
С целью ускорения и упрощения посева воды все ингредиенты магниевой среды (кроме дрожжевого экстракта) можно заранее внести в стерильную емкость объемом 500 см3 и хранить при температуре 2 - 5 °C (в течение 5 - 6 ч происходит самостерилизация смеси). Если плотно закрыть емкость, смесь можно хранить при комнатной температуре в течение 5 - 7 суток. Дополнительная стерилизация не требуется. В день посева на сальмонеллы в каждую емкость с ингредиентами вносят соответствующий объем исследуемой воды, тщательно перемешивают до полного растворения всех ингредиентов и добавляют дрожжевой экстракт.
Среду, готовую к применению, используют в соответствии с инструкцией производителя.
ИС МЕГАНОРМ: примечание. Текст дан в соответствии с официальным текстом документа. |
Магниевая среда накопления для выделения сальмонелл
полевая модификация
2.25. Состав:
- магний хлористый кристаллический ............................ 19,5 г;
- натрий хлористый ............................................. 4,0 г;
- калий фосфорнокислый однозамещенный безводный ................ 0,8 г;
- 10%-й раствор пептона ..................................... 25,0 см3.
Дрожжевой экстракт:
- жидкий из пекарских дрожжей 11,0 см3 или сухой препарат ...... 2,5 г;
- бриллиантовый зеленый 0,1%-й водный раствор ................ 2,5 см3.
Каждый ингредиент (в виде навески или раствора) из указанных выше вносят последовательно в стеклянную емкость, содержащую 500 см3 анализируемой воды, по одному после полного растворения предыдущего.
Допускается использование стерильных емкостей, в которые в условиях стационарной лаборатории внесены сухие ингредиенты и растворы.
Среды в емкости допускается хранить в течение 7 сут.
Питательная среда для сальмонелл РНС
2.26. Состав:
- экстракт кормовых дрожжей (ЭКД)
(ФСП 42-0010-5883-04) или другой, соответствующий
требованиям ФСП 42-0010-5883-04 ................................ 5,0 г;
- калий фосфорнокислый однозамещенный .......................... 8,8 г;
- натрия гидроксид ................................... (1,4 +/- 0,1) г;
- водорастворимый бриллиантовый зеленый ...................... 0,005 г;
- водорастворимый кристаллический фиолетовый ................. 0,001 г;
- вода очищенная ......................................... до 1000 см3.
Компоненты среды растворяют в воде нагреванием. Среду разливают во флаконы, стерилизуют при температуре 112 °C в течение 15 мин. Питательная среда представляет собой стерильную, прозрачную жидкость зеленого цвета, pH среды от 6,4 до 6,8, аминный азот от 0,05 до 0,1%, обеспечивает рост тест-штаммов сальмонелл при посеве единичных клеток.
Дифференциально-селективная питательная среда для выделения
шигелл и сальмонелл сухая (ГЕКТОЕНАГАР)
2.27. Готовят из сухой питательной среды промышленного производства согласно инструкции производителя.
Ксилоза лизин дезоксихолатный агар (XLD агар)
2.28. Готовят из сухой питательной среды промышленного производства согласно инструкции производителя.
Дезоксихолат-цитратный агар
2.29. Готовят из сухой питательной среды промышленного производства согласно инструкции производителя.
Тетратионатная среда накопления по Preuss
2.30. К 1000 см3 мясо-пептонного бульона добавляют 5 см3 0,1%-го водного раствора кристаллического фиолетового, стерилизуют при температуре 112 °C в течение 12 мин. После охлаждения добавляют 20,0 г тетратионата калия, устанавливают pH 6,5. Среду разливают в стерильные емкости размера, необходимого для последующего посева.
Срок хранения - до одной недели при температуре 4 °C.
Висмут-сульфит агар
2.31. Готовят из сухой питательной среды промышленного производства согласно инструкции производителя.
До посева чашки со средой выдерживают в холодильнике не менее 24 ч.
Агар с эозиновым метиленовым синим (ЭМС/среда Левина-ГРМ)
2.32. Готовят из сухой питательной среды промышленного производства согласно инструкции производителя.
Бактоагар Плоскирева
2.33. Готовят из сухой питательной среды промышленного производства согласно инструкции производителя.
Хромогенная дифференциально-диагностическая среда
Рамбах-агар для обнаружения сальмонелл
2.34. Среду готовят из сухого препарата в соответствии с инструкцией производителя. Приготовленную и охлажденную до температуры 45 - 50 °C среду после тщательного перемешивания разливают в стерильные чашки Петри. Разлитая среда не должна содержать следов влаги на поверхности. Срок хранения чашек Петри со средой в стерильных светоизолированных упаковках (например, пеналах или обернутыми плотной стерильной бумагой) при температуре 4 - 10 °C - не более 7 суток.
Селективный бульон для бактерий рода Shigella
2.35. Состав:
- гидролизат казеина ферментативный ........................... 20,0 г;
- натрий хлористый ............................................ 5,0 г;
- калий фосфорнокислый двузамещенный ........................... 2,0 г;
- калий фосфорнокислый однозамещенный .......................... 2,0 г;
- глюкоза ...................................................... 1,0 г;
- твин 80 ...................................................... 1,5 г;
- вода ...................................................... 1000 см3.
Компоненты растворяют в воде нагреванием, устанавливают pH, чтобы после стерилизации он составлял (7,0 +/- 0,2) при температуре 25 °C. Среду разливают во флаконы, стерилизуют при температуре 112 °C в течение 15 мин, охлаждают до температуры 45 - 50 °C и асептически добавляют на 1 дм3 среды 5 см3 раствора селенитовой добавки (новобиоцин 55 мг в 5 см3 стерильной воды) для подавления роста грамположительных и некоторых грамотрицательных бактерий.
Сальмонелла/шигелла агар с дезоксихолатом натрия
и хлоридом кальция (SSDC)
2.36. Готовят из сухой питательной среды промышленного производства согласно инструкции производителя.
Хранят в темном месте 1 неделю при температуре (8 +/- 2) °C в пластиковом пакете. Не следует охлаждать до температуры (3 +/- 2) °C, так как в среде образуется осадок и ухудшаются ее характеристики.
Питательные среды обогащения для выделения
Pseudomonas aeruginosa
Минеральная среда Бонде нормальной концентрации
3.1. Состав:
- трехзамещенный фосфат натрия ................................ 0,28 г;
- фосфат натрий-аммония ....................................... 0,15 г;
- однозамещенный фосфат калия .................................. 0,1 г;
- сульфат магния .............................................. 0,02 г;
- дистиллированной воды ................................ до 100,0 см3.
Стерилизация при 1 атм в течение 20 минут.
Непосредственно перед посевом прибавить 2,0 см3 0,01% водного раствора кристаллического фиолетового.
Концентрат среды Бонде.
Все компоненты, кроме воды, добавляют в 10-кратном размере. Концентрат прибавляется к объекту в соотношении 1:10.
Селективно-дифференциальная среда второго
этапа - среда "Блеск"
3.2. Состав:
- мясо-пептонный стерильный агар 2% .......................... 100 см3;
- молоко нормализованное стерильное ......................... 10,0 см3;
- 10% водного раствора ТТХ ................................... 8,0 см3;
- L-аргинин гидрохлорид ........................................ 0,3 г.
В расплавленный МПА прибавить аргинин, раствор ТТХ (самостерилизуется после хранения при комнатной температуре в течение 2 - 3 дней) и стерильное снятое молоко. Все размешать и разлить в 6 - 7 чашек Петри.
При отсутствии мясо-пептонного агара возможно применение упрощенного варианта среды "блеск":
- вода дистиллированная .................................... 100,0 см3.
Сухой питательный агар по прописи на этикетке.
Стерилизовать при 0,5 атм в течение 15 минут. Внести: стерильного снятого молока 10,0 см3 и 10% водного раствора ТТХ 8,0 см3. Смешать и разлить в 6 - 7 чашек Петри.
Среда Кинг-A
3.3. Состав:
- пептон ....................................................... 2,0 г;
- агар ......................................................... 1,5 г;
- глицерин ..................................................... 1,0 г;
- сульфат калия ................................................ 1,0 г;
- хлорид магния .............................................. 0,14 г;
- вода дистиллированная ................................... до 100 см3.
pH среды 7,2. Стерилизация при 0,5 атм в течение 15 минут. Разлить в 6 - 7 чашек Петри.
Среда для определения теста Хью и Лейфсона (окисление,
ферментация глюкозы). Модификация в одной пробирке
3.4. Состав:
- пептон ферментативный ........................................ 2,0 г;
- хлорид натрия ................................................ 5,0 г;
- глюкоза ...................................................... 5,0 г;
-  ...................................................... 0,3 г;
...................................................... 0,3 г;
 ...................................................... 0,3 г;
...................................................... 0,3 г; - агар-агар .................................................. 4 - 6 г;
- 1,6% раствор фенолового красного ........................... 2,5 см3;
- вода дистиллированная ..................................... 1000 см3.
После растворения всех ингредиентов на водяной бане доводят pH до (7,1 - 7,2), стерилизуют при температуре 112 °C в течение 20 минут в автоклаве, разливают в пробирки высотой столбика 6 см (независимо от диаметра пробирки), остужают столбиком.
Питательная среда для селективного выделения псевдомонад
сухая (Цетримидная)
3.5. Состав:
- пептон из желатина ......................................... 20,0 г;
- хлористый магний ............................................. 1,4 г;
- сульфат калия ............................................... 10,0 г;
- цетримид ..................................................... 0,3 г;
- агар-агар ................................................... 13,0 г;
- глицерин .................................................... 10 см3.
Растворяют 44,5 г/дм3 воды, добавляют 10 см3 глицерина на 1 дм3 бульона. Дают среде набухнуть в течение 20 - 30 минут. Затем автоклавируют в течение 15 минут при температуре 121 °C, разливают в чашки. pH (7,0 +/- 0,2) при температуре 25 °C. Среда в чашках мутная, светло-коричневая.
Легионелбакагар
3.6. Готовят из сухой питательной среды промышленного производства согласно инструкции производителя.
Компоненты основы среды БУДРАГ (на 1 литр)
3.7. Состав:
- дрожжевой экстракт .......................................... 10,0 г;
- агар ........................................................ 13,0 г;
- активированный уголь ......................................... 2,0 г;
- б-кетоглютаровой кислоты калийная соль ....................... 1,0 г;
- ACES-буфер, pH 6,9 .......................................... 10,0 г;
- 1 М раствор KOH ............................................. 40 см3;
- глицин ....................................................... 3,0 г.
Компоненты ростовой добавки (на 1 литр):
- L-цистеин .................................................... 0,4 г;
- пирофосфат железа растворимый ............................... 0,25 г.
Компоненты селективной добавки (на 1 литр):
- полимиксин B ............................................. 80000 ед.;
- ванкомицин ................................................... 5 см3;
- циклогексимид ............................................... 80 см3.
Приготовление кислотного KCl-HCl буфера: к 39 см3 0,4 М раствора HCl добавляют 250 см3 0,4 М раствора KCl. С помощью 1 М раствора KOH доводят значение pH буфера до 2,2. Хранят в темном флаконе при температуре плюс 4 °C не более 1 месяца.
Приготовление среды: к навеске ACES-буфера добавить 500 см3 дистиллированной воды и выдержать на водяной бане при температуре 50 °C, помешивая до полного растворения. К 440 см3 дистиллированной воды добавить 40 см3 1 М раствора KOH.
Оба раствора осторожно смешать и полученным раствором залить смесь навесок агара, дрожжевого экстракта, активированного угля, калийной соли б-кетоглютаровой кислоты и глицина. Смесь выдержать на водяной бане при температуре 50 °C, осторожно помешивая до полного растворения всех компонентов. Среду автоклавируют при температуре 121 °C в течение 15 минут.
После стерилизации среду охлаждают до 50 °C и добавляют с соблюдением правил асептики компоненты ростовой и селективной добавки.
Каждую навеску L-цистеина и пирофосфата железа растворимого вносят в 10 см3 дистиллированной воды, стерилизуют фильтрацией через мембранный фильтр и добавляют в среду.
Концентрированные растворы препаратов (селективные добавки также добавляют в среду до требуемой конечной концентрации).
pH готовой среды (6,95 +/- 0,02). Среду разливают в стерильные чашки Петри по 25 см3 и подсушивают в термостате при температуре 37 °C в течение ч. Готовая среда имеет характерный черно-серый цвет.
В качестве контрольной среды, не поддерживающей рост легионелл, используют среду Будраг без добавления селективной и ростовой добавки. Для пересева колоний легионелл и дальнейшего культивирования используют среду Будраг с ростовой, но без селективной добавки.
Селективный агар Престона
3.8. Состав основы среды:
- пептон ...................................................... 10,0 г;
- мясной экстракт ............................................. 10,0 г;
- натрия хлорид ................................................ 5,0 г;
- агар-агар ................................................... 12,0 г.
Вода дистиллированная 1000,0 см3, pH (при температуре 25 °C (7,5 +/- 0,2)).
Растворить основные компоненты в дистиллированной воде. При необходимости довести до кипения для полного растворения частиц. Установить pH (7,5 +/- 0,2) с помощью 0,1 н HCl или 0,1 н NaOH. Стерилизовать автоклавированием при температуре 121 °C в течение 15 мин. Остудить до 45 - 50 °C.
Приготовление полной среды: перед использованием в 1000 см3 расплавленного и остуженного до 45 - 50 °C агара асептически добавить 70 см3 стерильной дефибринированной крови барана; растворенное в 50%-м растворе ацетона содержимое двух флакончиков с добавкой антибиотиков для кампилобактерий IV (по Престону) или I (по Блейзер-Вонг), или растворенное в 50% растворе этанола содержимое двух флакончиков с селективной ростовой добавкой для кампилобактерий, или 4 см3 аэротолерантной добавки, тщательно перемешать и разлить в стерильные чашки Петри слоем 4 - 5 мм.
Селективные бульоны Престона, Дойла, Мюллера-Хинтона
3.9. Готовят из сухой питательной среды промышленного производства согласно инструкции производителя.
Питательная среда для культивирования кампилобактерий,
сухая - кампилобакагар
3.10. 40 г сухой среды размешать в 1 л дистиллированной воды, довести до кипения и кипятить 2 - 3 минуты до полного растворения.
Среду разлить по 400 см3 в колбы и стерилизовать автоклавированием 20 минут при температуре 121 °C. В остуженную до температуры 50 - 55 °C питательную основу среды вносят FBP-добавки для повышения аэротолерантности и 20 см3 бараньей или донорской крови и разливают в чашки Петри по 15 - 20 см3. Для придания среде селективных свойств используют селективные смеси.
FBP-добавки (указанное количество добавок рассчитано на 1 дм3 питательной среды):
- железа сульфат II ........................................... 0,25 г;
- натрий пиросернистокислый (метабисульфит) ................... 0,25 г;
- натрий пировинограднокислый (пируват) ....................... 0,25 г.
Навески солей внести в сухую стерильную пробирку, добавить 5 см3 стерильной дистиллированной воды, периодически встряхивать в течение 15 - 20 минут. Приготовленный раствор имеет оливковый цвет, не подлежит хранению и должен быть использован в день приготовления.
Бульон, содержащий пептон, сорбит, желчные соли (PSB)
3.11. Состав:
- ферментативный гидролизат казеина ............................ 5,0 г;
- сорбит ...................................................... 10,0 г;
- натрий хлорид ................................................ 5,0 г;
- натрий фосфорнокислый двузамещенный ......................... 8,23 г;
- натрий фосфорнокислый однозамещенный ......................... 1,2 г;
- желчные соли ................................................. 1,5 г;
- вода дистиллированная ..................................... 1000 см3.
Растворяют компоненты в воде, разливают необходимый объем в колбы, стерилизуют 15 мин при температуре 121 °C. После стерилизации pH = (7,6 +/- 0,2) при температуре 25 °C.
Агар МакКонки-ГРМ
3.12. Готовят из сухой питательной среды промышленного производства согласно инструкции производителя.
Питательный бульон для выделения листерий сухой (ПБЛ-1)
3.13. Готовят из сухой питательной среды промышленного производства согласно инструкции производителя.
Селективный бульон для обогащения листерий сухой
(Бульон UVM)
3.14. Готовят из сухой питательной среды промышленного производства согласно инструкции производителя.
Селективный бульон Фрейзера для обогащения листерий сухой
3.15. Готовят из сухой питательной среды промышленного производства согласно инструкции производителя.
Питательный агар для селективного выделения и идентификации
листерий сухой (ПАЛКАМ-агар)
3.16. Готовят из сухой питательной среды промышленного производства согласно инструкции производителя.
Листерия агар (базовый) асс. OTTAVIANI and AGOSTI
3.17. Готовят из сухой питательной среды промышленного производства согласно инструкции производителя.
Жидкая среда Сабуро
3.18. Состав:
- пептона ..................................................... 10,0 г;
- глюкозы ..................................................... 40,0 г;
- вода дистиллированная ..................................... 1000 см3.
Для приготовления концентрированной среды Сабуро все ингредиенты, кроме воды, увеличивают в 10 раз, смесь подогревают, периодически помешивая, до расплавления составных частей, охлаждают до 45 - 55 °C, устанавливают pH 5,6 +/- 0,2, разливают по 10 см3 в емкости. Стерилизуют в автоклаве при температуре 112 °C в течение 15 минут.
Плотная среда Сабуро (агаризованная, основа среды)
3.19. Состав:
- пептона ..................................................... 10,0 г;
- глюкозы ..................................................... 40,0 г;
- агар-агар ................................................... 18,0 г;
- вода дистиллированная ..................................... 1000 см3.
pH 6,5 +/- 1
Среда Сабуро агаризованная с антибиотиками группы
пенициллина и стрептомицина
3.20. К 1 дм3 основы среды Сабуро добавляют 1 или 0,5 см3 раствора антибиотика группы пенициллина, соответственно 50000 или 100000 Ед, затем к среде добавляют 0,4 см3 раствора антибиотика группы стрептомицина массовой концентрацией 100 г/дм3.
Питательная среда N 2 (агар Сабуро)
3.21. Готовят и хранят из сухого препарата промышленного производства по прописи на этикетке. Применяют для выделения грибов.
Селективный питательный агар для выделения и учета дрожжевых
и плесневых грибов с хлорамфениколом
3.22. Готовят и хранят из сухого препарата промышленного производства по прописи на этикетке.
Хромогенная среда для выделения и дифференциации Candida
3.23. Готовят и хранят из сухого препарата промышленного производства по прописи на этикетке. Применяют для выделения и идентификации грибов C. albicans, C. tropicalis, C. krusei.
Рисовый агар
3.24. Состав:
- рис ......................................................... 20,0 г;
- агар-агар ................................................... 20,0 г;
- вода дистиллированная ..................................... 1000 см3.
Рис в зернах измельчают в ступке и заливают 500 см3 дистиллированной воды, стерилизуют текучим паром 45 минут, отстаивают, фильтруют через 4 слоя марли. Осадок не отжимают. Агар-агар растворяют в 500 см3 дистиллированной воды, фильтруют. Фильтрат агара смешивают с фильтратом риса и доводят дистиллированной водой до 1 литра. Стерилизуют при температуре 121 °C в течение 20 минут, разливают в чашки Петри.
Кукурузный агар
3.25. Состав:
- настой кукурузной муки ................................. 50,00 г/дм3;
- агар-агар .............................................. 15,00 г/дм3.
Конечное значение pH (при температуре 25 °C) 6,0 +/- 0,2.
Гомогенный сыпучий светло-желтый грубый порошок. Готовая среда имеет светло-янтарную окраску, опалесцирует, по плотности соответствует 1,5% агаровому гелю. Порошок хранить при температуре ниже плюс 25 °C. Готовую среду хранить при температуре плюс 2 - 8 °C.
Или готовят и хранят из сухого препарата промышленного производства по прописи на этикетке.
Реактивы для оксидазного теста
3.26. Вариант 1. Раствор 1%-водный тетраметил-п-фенилендиамина гидрохлорида. Готовят перед употреблением.
Вариант 2. Реактив 1 - 1%-й спиртовой  . Реактив 2 - 1%-й водный диметил-п-фенилендиамина дигидрохлорида. Реактивы являются канцерогенными. Работу по приготовлению реактивов следует выполнять в вытяжном шкафу, используя защитные перчатки и избегая контакта реактива с кожей.
. Реактив 2 - 1%-й водный диметил-п-фенилендиамина дигидрохлорида. Реактивы являются канцерогенными. Работу по приготовлению реактивов следует выполнять в вытяжном шкафу, используя защитные перчатки и избегая контакта реактива с кожей.
 . Реактив 2 - 1%-й водный диметил-п-фенилендиамина дигидрохлорида. Реактивы являются канцерогенными. Работу по приготовлению реактивов следует выполнять в вытяжном шкафу, используя защитные перчатки и избегая контакта реактива с кожей.
. Реактив 2 - 1%-й водный диметил-п-фенилендиамина дигидрохлорида. Реактивы являются канцерогенными. Работу по приготовлению реактивов следует выполнять в вытяжном шкафу, используя защитные перчатки и избегая контакта реактива с кожей.Растворы сохраняют в темных флаконах с притертыми пробками: первый - до одного месяца, второй - до одной недели.
Перед употреблением к 2,5 частям первого раствора добавляют 7,5 частей второго раствора.
Каждую новую партию, а также периодически раз в месяц реактивы или тест-системы на оксидазу следует испытывать с тест-культурами микроорганизмов, дающих положительную (P. aeruginosa, P. fluorescens) и отрицательную (E. coli) оксидазную реакцию.
Реактив Ковача
3.27. Растворяют 5 г пара-диметиламинобензальдегида в 75 см3 амилового спирта на водяной бане при температуре 60 °C. Затем медленно добавляют 25 см3 концентрированной соляной кислоты. Приблизительно через 6 ч после изменения цвета реактив готов для употребления. Цвет готового реактива должен быть от светло-желтого до светло-коричневого. При использовании некачественного амилового спирта реактив может приобрести темный цвет.
Реактив следует хранить при температуре 4 °C в темном месте во флаконе из коричневого стекла. Срок хранения - две недели.
Среда Кларка
3.28. Состав:
- пептон ....................................................... 5,0 г;
- глюкоза ...................................................... 5,0 г;
- фосфорнокислый двузамещенный калий  ................... 5,0 г;
................... 5,0 г;
 ................... 5,0 г;
................... 5,0 г; - вода ...................................................... 1000 см3.
При нагревании растворяют компоненты в воде, затем охлаждают до температуры 45 - 47 °C и устанавливают pH таким образом, чтобы после стерилизации он составлял при температуре 25 °C (7,2 +/- 0,1). Среду разливают по 5 - 7 см3 в пробирки и стерилизуют при температуре 121 °C в течение 15 мин или дробным методом - текучим паром по 30 мин три дня подряд.
Желчная соль по Олькеницкому
3.29. К 1000 см3 желчи крупного рогатого скота прибавляют 40 г натрия гидрата окиси, гидролизуют в автоклаве при температуре 120 °C в течение 3 ч или 2 раза по 2 ч в эмалированной или стеклянной посуде, исключая алюминиевую.
После охлаждения в гидролизат прибавляют 100 см3 20%-го водного раствора бария хлористого и прогревают в автоклаве при 100 °C 1 ч. Через 18 - 24 ч отстаивания надосадочную жидкость сливают и фильтруют.
К профильтрованному гидролизату прибавляют при постоянном помешивании 20%-й раствор соляной кислоты до кислой реакции (pH 6,4 - 6,6) и оставляют на 18 - 24 ч.
Надосадочную жидкость сливают, осадок промывают водой, прибавляют при нагревании 40%-й раствор натрия гидрата окиси до слабо щелочной реакции (pH 7,2 - 7,4) и выливают на противень для подсушивания в сушильном шкафу при температуре 115 °C до порошкообразного состояния. Из 1000 см3 желчи можно получить 36 г смеси желчных солей. Следует остерегаться перещелачивания при последней операции.
Хранят соли в темной банке с притертой пробкой.
Жидкий дрожжевой экстракт
3.30. 1000 г (1 кг) прессованных (пекарских) дрожжей равномерно распределяют в 2000 см3 дистиллированной воды, прогревают в автоклаве при температуре 100 °C в течение 30 мин, охлаждают и отстаивают в холодильнике при температуре 2 - 5 °C. Через 4 - 5 суток надосадочную жидкость осторожно сливают в стерильные емкости по 50 - 100 см3, на каждые 100 см3 экстракта прибавляют 1,25 см3 0,01%-го водного раствора кристаллического фиолетового и повторно прогревают в автоклаве при температуре 100 °C в течение 30 мин. Готовый дрожжевой экстракт хранят в холодильнике при температуре 2 - 5 °C.
Можно применять сухой дрожжевой экстракт промышленного производства, уменьшив концентрацию в 10 раз от указанного в прописях сред.
Трехсахарный агар с мочевиной по Олькеницкому
3.31. Готовят из сухой питательной среды промышленного производства согласно инструкции производителя.
Железо-глюкозо-лактозный агар с мочевиной
Готовят из сухой питательной среды промышленного производства согласно инструкции производителя.
Среда для определения L-лизин (L-орнитин) декарбоксилазы
3.32. Состав:
- L-лизин (L-орнитин) моногидрохлорид .......................... 5,0 г;
- дрожжевой экстракт ........................................... 3,0 г;
- глюкоза ...................................................... 1,0 г;
- бромтимоловый пурпурный .................................... 0,015 г;
- вода ...................................................... 1000 см3.
Растворяют компоненты. pH раствора после стерилизации (6,8 +/- 0,2) при температуре 25 °C, разливают в пробирки по 5 см3. Стерилизуют 15 минут при температуре 121 °C.
Цитратная среда Симмонса
3.33. Состав:
- натрий аммоний фосфорнокислый двузамещенный .................. 1,5 г;
- калий фосфорнокислый однозамещенный ........................ 1,0 г;
- магний сернокислый ........................................... 0,2 г;
- цитрат натрия ................................................ 3,0 г;
- агар ..................................................... 18 - 20 г;
- вода ...................................................... 1000 см3.
Растворяют компоненты. pH после стерилизации (7,2 +/- 0,1) при температуре 25 °C. Среду стерилизуют в течение 15 минут при температуре 121 °C, после стерилизации добавляют 10 см3 0,5% раствора бромтимолового синего и разливают по 6 - 7 см3 в стерильные пробирки или по 15 см3 в чашки Петри. Среду в пробирках скашивают.
Среда для определения ферментации мальтозы
3.34. Состав:
- пептон ....................................................... 0,2 г;
- агар ......................................................... 1,5 г;
- хлорид натрия ................................................ 0,5 г;
- мальтоза ..................................................... 2,0 г;
- 1,6% спиртовой или щелочной раствор;
- бромтимолового синего ...................................... 1,0 см3;
- вода дистиллированная ................................... до 100 см3.
pH среды 7,2. Стерилизация при 0,5 атм в течение 15 минут. Разлить в 6 чашек Петри.
ИС МЕГАНОРМ: примечание. Текст дан в соответствии с официальным текстом документа. |
Среда Гисса с углеводами (например, лактозой, мальтозой,
маннитом, сорбитом, маннитол, сахароза, рамноза, раффиноза,
сорбитол, мелибиоза, салицин, ксилоза)
3.35. Среду готовят из сухого препарата по способу, указанному производителем, разливают в стерильные пробирки на высоту 3 - 5 см и стерилизуют при температуре 110 °C в течение 20 минут. Срок хранения не более двух недель.
Среда Клиглера
3.36. Состав:
- пептон ...................................................... 20,0 г;
- натрия хлорид ................................................ 5,0 г;
- натрия сульфат ............................................... 0,4 г;
- мясная вода ............................................... 1000 см3;
- натрия тиосульфат ........................................... 0,08 г;
- агар питательный сухой ...................................... 20,0 г;
- лактоза ..................................................... 10,0 г;
- сахароза .................................................... 10,0 г;
- глюкоза ...................................................... 1,0 г;
- железо (II) сульфат .......................................... 0,5 г;
- феноловый красный (0,2%-й раствор в 50%-м этаноле) .......... 12 см3.
В мясную воду добавляют пептон, соли натрия и агар. Смесь кипятят до растворения агара, устанавливают pH 7,2 - 7,4. Вновь кипятят, фильтруют через вату, добавляют растворенное в небольшом количестве воды сернокислое железо, лактозу, сахарозу, глюкозу, индикатор. Среду разливают по 6 - 7 см3 в пробирки, автоклавируют 15 - 20 минут при 0,5 атм и температуре 112 °C. Среду скашивают, оставляя столбик не менее 2,5 - 3,0 см. Готовая среда оранжево-красного цвета. При образовании сероводорода столбик среды чернеет.
Реактивы для окраски препаратов по Граму
3.37. Карболовый раствор генциана фиолетового готовят следующим образом:
генциана фиолетового ............................................. 1 г;
ректификованного этилового спирта ............................. 10 см3;
фенола ........................................................... 5 г;
растирают в ступке, добавляя 100 см3 дистиллированной воды.
Раствор Люголя готовят следующим образом:
йода ............................................................. 1 г;
йодистого калия .................................................. 2 г.
Растворяют в 300 см3 дистиллированной воды.
Хранить во флаконе из темного стекла.
Фуксин Циля готовят следующим образом:
основного фуксина ................................................ 1 г;
спирта этилового ректификованного ............................. 10 см3;
фенола ........................................................... 5 г.
Растирают в ступке, добавляя 100 см3 дистиллированной воды.
Спиртовой раствор 

3.38. 5 г  , имеющего точку плавления 92,5 °C, вносят в мерную колбу вместимостью 100 см3 и доливают этиловым спиртом с объемной долей 96% до метки. Раствор применяют свежеприготовленным для определения ацетоина (ацетилметилкарбинола).
, имеющего точку плавления 92,5 °C, вносят в мерную колбу вместимостью 100 см3 и доливают этиловым спиртом с объемной долей 96% до метки. Раствор применяют свежеприготовленным для определения ацетоина (ацетилметилкарбинола).
 , имеющего точку плавления 92,5 °C, вносят в мерную колбу вместимостью 100 см3 и доливают этиловым спиртом с объемной долей 96% до метки. Раствор применяют свежеприготовленным для определения ацетоина (ацетилметилкарбинола).
, имеющего точку плавления 92,5 °C, вносят в мерную колбу вместимостью 100 см3 и доливают этиловым спиртом с объемной долей 96% до метки. Раствор применяют свежеприготовленным для определения ацетоина (ацетилметилкарбинола).Раствор с объемной долей перекиси водорода 3%
3.39. 10 см3 пироксида водорода с содержанием основного вещества 30% переносят в мерную колбу вместимостью 100 см3, доводят объем дистиллированной водой до метки. Раствор применяется для определения каталазной активности.
Раствор гидроксида калия
3.40. В мерной колбе растворяют 40,0 г гидроксида калия (KOH) в 100 см3 воды.
Тест Грегерсена
3.41. В капле 3% водного раствора KOH на предметном стекле эмульгируют бактериальную массу, взятую с плотной среды. После нескольких секунд перемешивания петлей взвесь ослизняется и за петлей тянутся слизистые нити, что указывает на принадлежность испытуемой культуры или колонии к грамотрицательному виду бактерий. У грамположительных бактерий, за редкими исключениями, реакция отрицательна.
Глициновый буфер с pH 1
3.42. Навеску 0,385 г аминоуксусной кислоты растворяют в 100 см3 дистиллированной воды и получают глицин. К 50 см3 глицина добавляют 50 см3 0,1 N раствора гидроксида натрия и получают глициновый буфер с pH 11,5.
Для приготовления глицинового буфера (pH 1,5 - 1,6) к 38 см3 глицина добавляют 62 см3 0,1 N раствора соляной кислоты.
Насыщенный раствор сульфата аммония
3.43. В 1 дм3 теплой стерильной дистиллированной воды 30 - 35 °C растворяют 800 г сульфата аммония ((NH4)2SO4). Полученный раствор фильтруют, доводят до pH 7,2 и охлаждают в холодильнике.
0,5 М фосфатный буфер с pH 8,2
3.44. Готовят навески солей: Na2HPO4*2H2O - 89,0 г (раствор A) и KH2PO4 - 68,06 г (раствор B). Каждую навеску вносят в отдельную мерную колбу, добавляют дистиллированную воду до объема 1 дм3 и растворяют соли. Для получения буфера с pH 8,2 смешивают 96,9 см3 раствора A и 3,1 см3 раствора B и одним из этих растворов доводят pH буфера до 8,2.
Тест-культуры микроорганизмов
4.1. Для проведения контроля качества бактериальных питательных сред необходимо иметь коллекцию типовых культур, которые могут быть получены из специализированных коллекций (например, бактериофаг (колифаг) MS-2, Escherichia coli штамм K12 F+ StrR, Pseudomonas aeruginosa, Pseudomonas fluorescens, Campylobacter jejuni, Campylobacter coli, Campylobacter lari, Enterococcus faecalis, M17-02, аналогичный штамму M17), типичные по культуральным, морфологическим и биохимическим свойствам, паспортизированные и депонированные в установленном порядке.
Изоляты микроорганизмов, выделенные из клинического материала и используемые для контроля, должны по свойствам соответствовать микроорганизмам признанных национальных и международных коллекций.
Полученные лабораторией музейные тест-штаммы и свежевыделенные культуры хранят при температуре 2 - 8 °C, в лиофилизированном состоянии, на среде хранения или в условиях низких температур с криопротекторами.
Для контроля качества питательных, дифференциальных сред и тестовых наборов используют тест-штаммы микроорганизмов для положительного и отрицательного контроля с типичными биохимическими свойствами, например:
- Escherichia coli 1257, Escherichia coli ATCC 25922 или Escherichia coli ATCC 10536, Klebsiella pneumoniae ATCC 31488 или Klebsiella pneumoniae ATCC 700603 (положительный контроль) и Pseudomonas aeruginosa ATCC 10145 или Pseudomonas aeruginosa ATCC 27853;
- Enterococcus faecalis 29212 ATCC или Enterococcus faecium 35667 (положительный контроль), Serratiamarcescens 43862 (отрицательный контроль) при использовании экспресс тест-набора для определения энтерококков;
- Pseudomonas aeruginosa ATCC 10145 или Pseudomonas aeruginosa ATCC 27853 или Pseudomonas aeruginosa ATCC 15442 (положительный контроль), Escherichia coli 1257, Escherichia coli ATCC 25922 или Escherichia coli ATCC 10536 (отрицательный контроль) при использовании экспресс тест-набора для определения Pseudomonas aeruginosa;
ИС МЕГАНОРМ: примечание. Текст дан в соответствии с официальным текстом документа. |
- Candida albicans 24433 ATCC (положительный контроль) и Bacillus cereus ATCC 10876 (отрицательный контроль) при использовании подложек;
- Aspergillusbrasiliensis ATCC 16404 (положительный контроль) Bacillus subtilis ATCC 6633 (отрицательный контроль) при использовании подложек;
- Staphylococcus aureus 906 или Staphylococcus aureus ATCC 6538 (положительный контроль), Escherichia coli 1257, Escherichia coli ATCC 25922 или Escherichia coli ATCC 10536 (отрицательный контроль) при использовании подложек;
- Salmonella enteritidis 5765 или Salmonella enterica ATCC 13311 (положительный контроль) и Pseudomonas aeruginosa ATCC 10145 или Pseudomonas aeruginosa ATCC 27853 или Pseudomonas aeruginosa 15442 (отрицательный контроль) при использовании подложек.
к МУК 4.2.3963-23
1. Перед посевом пробу тщательно перемешивают (стараясь не намочить пробку), край емкости фламбируют открытым пламенем, пробирки и чашки, подготовленные для посева, маркируют. Перед каждым отбором новой порции воды для исследования пробу перемешивают стерильной пипеткой. Схема посева воды из различных объектов приведена в табл. 3.1 и 3.2 приложения 3 к настоящим МУК.
Таблица 3.1
методом мембранной фильтрации
Объект исследования | Объем засеваемой воды в см3 для определения | |
Обобщенные колиформные бактерии | Энтерококки | |
Водоемы, не загрязняемые сточными водами | 100; 50; 10; 1 | 100; 50; 10 |
Водоемы, загрязняемые сточными водами | 10; 1; 0,1; 0,01 | 10; 1; 0,1 |
Водоемы в зоне влияния выпуска сточных вод | 0,1; 0,01; 0,001; 0,0001 | 1; 0,1; 0,01 |
Таблица 3.2
титрационным методом
Объект исследования | Объем засеваемой воды (в см3) для определения <*> | |
Обобщенные колиформные бактерии | Энтерококки | |
Водоемы, не загрязняемые сточными водами | 2 или 3 повторности по: 10; 1; 0,1 2 или 3 повторности по: 10; 1; 0,1; 0,01 | 50 и 5 повторностей по: 10; 1 2 или 3 повторности по: 100; 10; 1; 0,1 |
Водоемы, загрязняемые сточными водами | 2 или 3 повторности по: 1; 0,1; 0,01; 0,001 | 2 или 3 повторности по: 10; 1; 0,1; 0,01 |
Водоемы в зоне влияния выпусков сточных вод | 2 или 3 повторности по: 0,1; 0,01; 0,001; 0,0001; 0,00001 | 2 или 3 повторности по: 1; 0,1; 0,01; 0,001 |
Для посева проб воды используют следующие методы в зависимости от степени загрязнения воды и от поставленной цели исследования:
- метод прямого посева на агаризованные среды;
- метод мембранной фильтрации;
- титрационный метод;
- метод глубинного посева в плотные питательные среды.
Метод прямого посева
2. Метод выполняют путем нанесения дозированного объема воды (0,1 см3 или 0,25 см3) на поверхность предварительно разлитых в чашки Петри агаризованных питательных сред в соответствии с определяемым показателем. Внесенный инокулят растирают стерильным шпателем до полного его впитывания с последующим инкубированием посевов.
Для посева десятикратные разведений воды исследуемого образца пробы следует готовить непосредственно перед анализом. Для разведений используют один из стерильных растворов: физиологический раствор, пептонный, пептонно-солевой, воду пептонную забуференную (приложение 2 к настоящим МУК), разлитых в пробирки по 9 см3. Стерилизация заранее расфасованных растворов для разведений не рекомендуется, т.к. при автоклавировании их объем может измениться из-за испарения.
Для приготовления 1 разведения (1:10) 1 см3 хорошо перемешанной анализируемой пробы воды стерильной пипеткой переносят в пробирку с 9 см3 раствора. При этом пипетка не должна быть опущена ниже поверхности раствора для разведения, чтобы избежать смывания бактерий с наружной стороны пипетки. Другой стерильной пипеткой путем многократного заполнения и опорожнения пипетки тщательно перемешивают содержимое пробирки, отбирают из нее 1 см3 и переносят в следующую пробирку с 9 см3 раствора, получая при этом разведение 1:100.
Посев 0,1 см3 анализируемой воды на поверхность плотных питательных сред будет соответствовать посеву 0,1 см3 анализируемой воды, посев 0,1 см3 из 1 разведения - 0,01 см3 исследуемой пробы. При необходимости посева меньших объемов этой же пипеткой переносят 1 см3 содержимого первой пробирки в следующую пробирку с 9 см3 раствора для разбавления. Эти операции повторяют до получения необходимого количества разведений.
Допустимо использование метода спирального автоматизированного посева проб воды.
Метод мембранной фильтрации
3. Метод мембранной фильтрации используют при посеве больших объемов проб воды (1 и более см3). Искомые микроорганизмы концентрируют из заданного объема воды на мембранные фильтры с последующим помещением фильтров на питательную среду и инкубацией посевов.
Подготовка мембранных фильтров. Фильтрующие материалы (мембранные фильтры, аналитические трековые мембраны и другие фильтрующие материалы) с размером диска 35 мм, 37 мм или 47 мм и диаметром пор не более 0,45 мкм, должны быть стерильными или приготовлены к анализу в соответствии с указаниями производителя.
Подготовка фильтровального аппарата. Воронку снимают на лоток. Воронку и столик фильтровального аппарата фламбируют, применяя марлевый (ватный) тампон, смоченный спиртом (не менее 95%) или газовый пистолет для фламбирования. На столик фильтровального аппарата кладут стерильным пинцетом стерильный или специально подготовленный мембранный фильтр и снова устанавливают фильтровальную воронку.
Фильтрование воды. В воронку прибора для фильтрования наливают отмеренный объем воды, согласно метке на фильтровальной установке, а в случае отсутствия метки используют стерильный мерный цилиндр соответствующего объема, затем создают вакуум и отфильтровывают содержимое воронки. После окончания фильтрования и осушения фильтра отключают вакуум, воронку снимают, фильтр осторожно поднимают за край стерильным пинцетом и переносят его, не переворачивая, на поверхность питательной среды, разлитой в чашки Петри, избегая пузырьков воздуха между средой и фильтром. Поверхность фильтра с осевшими на ней бактериями должна быть обращена вверх.
При посеве нескольких объемов одной пробы следует фильтровать через один фильтровальный аппарат без фламбирования сначала меньшие, а затем большие объемы воды, меняя каждый раз фильтры. Перед фильтрованием новой пробы прибор обеззараживают.
Анализ следует начинать с фильтрования проб обеззараженной воды или тех проб, которые предположительно не загрязнены, а затем фильтровать загрязненные пробы.
При фильтровании 1 см3 исследуемой воды следует в воронку налить предварительно не менее 10 см3 стерильной водопроводной воды, а затем внести 1 см3 анализируемой воды.
Под каждым фильтром на дне чашки делают надпись с указанием объема профильтрованной воды, номера пробы и даты посева. На одну чашку можно поместить 1 или несколько фильтров в зависимости от размера чашки, но с условием, чтобы фильтры не соприкасались.
Титрационный метод
4. Метод основан на накоплении бактерий в жидкой питательной среде при посеве испытуемой воды и (или) ее десятикратных разведений, с последующим пересевом на дифференциальную плотную среду для идентификации выросших колоний по культуральным, морфологическим, тинкториальным и биохимическим свойствам.
Титрационный метод может быть использован:
- при отсутствии материалов и оборудования, необходимых для выполнения исследования методом мембранной фильтрации;
- при анализе воды с большим содержанием взвешенных веществ;
- в случае высокого бактериального загрязнения воды, препятствующей получению на фильтрах изолированных колоний.
Посев производят в 2 или 3 параллельных рядах, учитывая при этом, что чем больше повторностей, тем выше точность получаемых результатов.
Схему посева 50 см3 и 5 по 10 см3 и 5 по 1 см3 используют при исследовании воды чистых водохранилищ.
Метод глубинного посева в плотные питательные среды
5. Пробу воды или десятикратные ее разведения вносят параллельно в две чашки Петри по 1 см3 и заливают не позднее чем через 15 мин расплавленной и охлажденной до температуры (45 +/- 47) °C питательной средой тонким слоем 8 - 12 см3 (при определении общего микробного числа). При внесении большего объема исследуемой воды (10 см3) каждую чашку заливают агаризованной средой из расчета 2 части агара к 1 части пробы (колифаги, споры сульфитредуцирующих клостридий).
Среду немедленно равномерно перемешивают с посевным материалом круговыми движениями чашки так, чтобы среда не вытекла из чашки и не загрязняла крышку. После застывания среды чашки с посевами вверх дном помещают в термостат.
к МУК 4.2.3963-23
Таблица 4.1
Расчет наиболее вероятного числа бактерий
в 100 см3 питьевой воды
Число положительных результатов из: | НВЧ бактерий в 100 см3 | Доверительный интервал (95%) | |||
3 объема по 100 см3 | 3 объема по 10 см3 | 3 объема по 1 см3 | нижний | верхний | |
1 | 2 | 3 | 4 | 5 | 6 |
0 | 0 | 1 | 0,3 | 0 | 1,4 |
0 | 0 | 2 | * <1> | - | - |
0 | 0 | 3 | * | - | - |
0 | 1 | 0 | 0,3 | 0,1 | 1,4 |
0 | 1 | 1 | * | - | - |
0 | 1 | 2 | * | - | - |
0 | 1 | 3 | * | - | - |
0 | 2 | 0 | 0,6 | 0,1 | 2,8 |
0 | 2 | 1 | * | - | - |
0 | 2 | 2 | * | - | - |
0 | 2 | 3 | * | - | - |
0 | 3 | 0 | * | - | - |
0 | 3 | 1 | * | - | - |
0 | 3 | 2 | * | - | - |
0 | 3 | 3 | * | - | - |
1 | 0 | 0 | 0,4 | 0,1 | 1,7 |
1 | 0 | 0 | 0,7 | 0,2 | 3,4 |
1 | 0 | 2 | * | - | - |
1 | 0 | 3 | * | - | - |
1 | 1 | 0 | 0,7 | 0,2 | 3,4 |
1 | 1 | 1 | 1,1 | 0,2 | 5,2 |
1 | 1 | 2 | * | - | - |
1 | 1 | 3 | * | - | - |
1 | 2 | 0 | 1,1 | 0,2 | 5,3 |
1 | 2 | 1 | * | - | - |
1 | 2 | 2 | * | - | - |
1 | 2 | 3 | * | - | - |
1 | 3 | 0 | * | - | - |
1 | 3 | 1 | * | - | - |
1 | 3 | 2 | * | - | - |
1 | 3 | 3 | * | - | - |
2 | 0 | 0 | 0,9 | 0,2 | 4,3 |
2 | 0 | 1 | 1,4 | 0,3 | 6,7 |
2 | 0 | 2 | * | - | - |
2 | 0 | 3 | * | - | - |
2 | 1 | 0 | 1,5 | 0,3 | 6,9 |
2 | 1 | 1 | 2 | 0,4 | 9,6 |
2 | 1 | 2 | * | - | - |
2 | 1 | 3 | * | ||
2 | 2 | 0 | 2 | 0,5 | 9,9 |
2 | 2 | 1 | 3 | 0,6 | 12,9 |
2 | 2 | 2 | * | - | - |
2 | 2 | 3 | * | - | - |
2 | 3 | 0 | 3 | 0,6 | 13,3 |
2 | 3 | 1 | * | - | - |
2 | 3 | 2 | * | - | - |
2 | 3 | 3 | * | - | - |
3 | 0 | 0 | 2 | 0,5 | 10,8 |
3 | 0 | 1 | 4 | 0,8 | 18,0 |
3 | 0 | 2 | 6 | 1,4 | 29,7 |
3 | 0 | 3 | * | - | - |
3 | 1 | 0 | 4 | 0,9 | 20,0 |
3 | 1 | 1 | 8 | 1,6 | 35,0 |
3 | 1 | 2 | 12 | 2,5 | 53,8 |
3 | 1 | 3 | * | - | - |
3 | 2 | 0 | 9 | 2,0 | 43,6 |
3 | 2 | 1 | 15 | 3,2 | 69,8 |
3 | 2 | 2 | 21 | 4,6 | 100,3 |
3 | 2 | 3 | 29 | 6,2 | 136,4 |
3 | 3 | 0 | 24 | 5,1 | 112,1 |
3 | 3 | 1 | 46 | 9,3 | 216,0 |
3 | 3 | 2 | 110 | 23,5 | 516,6 |
3 | 3 | 3 | > 240 | - | - |
Примечание: | |||||
Таблица 4.2
Расчет наиболее вероятного числа бактерий в 100 см3 воды
незагрязненных водоемов
Число положительных результатов из | НВЧ бактерий в 100 см3 | ||
1 объема по 50 см3 | 5 объемов по 10 см3 | 5 объемов по 1 см3 | |
0 | 0 | 0 | менее 1 |
0 | 0 | 1 | 1 |
0 | 0 | 2 | 2 |
0 | 1 | 0 | 1 |
0 | 1 | 1 | 2 |
0 | 1 | 2 | 3 |
0 | 2 | 0 | 2 |
0 | 2 | 1 | 3 |
0 | 2 | 2 | 4 |
0 | 3 | 0 | 3 |
0 | 3 | 1 | 5 |
0 | 4 | 0 | 5 |
1 | 0 | 0 | 1 |
1 | 0 | 1 | 3 |
1 | 0 | 2 | 4 |
1 | 0 | 3 | 6 |
1 | 1 | 0 | 3 |
1 | 1 | 1 | 5 |
1 | 1 | 2 | 7 |
1 | 1 | 3 | 5 |
1 | 2 | 0 | 5 |
1 | 2 | 1 | 7 |
1 | 2 | 2 | 10 |
1 | 2 | 3 | 12 |
1 | 3 | 0 | 8 |
1 | 3 | 1 | 11 |
1 | 3 | 2 | 14 |
1 | 3 | 3 | 8 |
1 | 3 | 4 | 21 |
1 | 4 | 0 | 13 |
1 | 4 | 1 | 17 |
1 | 4 | 2 | 22 |
1 | 4 | 3 | 28 |
1 | 4 | 4 | 35 |
1 | 4 | 5 | 43 |
1 | 5 | 0 | 24 |
1 | 5 | 1 | 35 |
1 | 5 | 2 | 54 |
1 | 5 | 3 | 92 |
1 | 5 | 4 | 160 |
1 | 5 | 5 | более 240 |
к МУК 4.2.3963-23
Таблица 5.1
Расчет наиболее вероятного числа бактерий в 100 см3 воды
при использовании трехрядовой схемы посева
Число положительных результатов из | НВЧ бактерий в 100 см3 | Число положительных результатов из | НВЧ бактерий в 100 см3 | ||||
трех объемов по 1 см3 | трех объемов по 0,1 см3 | трех объемов по 0,01 см3 | трех объемов по 1 см3 | трех объемов по 0,1 см3 | трех объемов по 0,01 см3 | ||
0 | 0 | 0 | менее 30 | 2 | 0 | 0 | 91 |
0 | 0 | 1 | 30 | 2 | 0 | 1 | 140 |
0 | 0 | 2 | 60 <*> | 2 | 0 | 2 | 200 <*> |
0 | 0 | 3 | 90 <*> | 2 | 0 | 3 | 260 <*> |
0 | 1 | 0 | 30 | 2 | 1 | 0 | 150 |
0 | 1 | 1 | 61 <*> | 2 | 1 | 1 | 200 |
0 | 1 | 2 | 92 <*> | 2 | 1 | 2 | 270 <*> |
0 | 1 | 3 | 120 <*> | 2 | 1 | 3 | 340 <*> |
0 | 2 | 0 | 62 <*> | 2 | 2 | 0 | 210 |
0 | 2 | 1 | 93 <*> | 2 | 2 | 1 | 280 |
0 | 2 | 2 | 120 <*> | 2 | 2 | 2 | 350 <*> |
0 | 2 | 3 | 160 | 2 | 2 | 3 | 420 <*> |
0 | 3 | 0 | 94 <*> | 2 | 3 | 0 | 290 |
0 | 3 | 1 | 130 <*> | 2 | 3 | 1 | 360 <*> |
0 | 3 | 2 | 160 <*> | 2 | 3 | 2 | 440 <*> |
0 | 3 | 3 | 190 <*> | 2 | 3 | 3 | 530 <*> |
1 | 0 | 0 | 36 | 3 | 0 | 0 | 230 |
1 | 0 | 1 | 72 | 3 | 0 | 1 | 390 |
1 | 0 | 2 | 110 <*> | 3 | 0 | 2 | 640 |
1 | 0 | 3 | 150 <*> | 3 | 0 | 3 | 950 <*> |
1 | 1 | 0 | 73 | 3 | 1 | 0 | 430 |
1 | 1 | 1 | 110 | 3 | 1 | 1 | 750 |
1 | 1 | 2 | 150 <*> | 3 | 1 | 2 | 1200 |
1 | 1 | 3 | 190 <*> | 3 | 1 | 3 | 1600 <*> |
1 | 2 | 0 | 110 | 3 | 2 | 0 | 930 |
1 | 2 | 1 | 150 <*> | 3 | 2 | 1 | 1500 |
1 | 2 | 2 | 200 <*> | 3 | 2 | 2 | 2100 |
1 | 2 | 3 | 240 <*> | 3 | 2 | 3 | 2900 |
1 | 3 | 0 | 160 <*> | 3 | 3 | 0 | 2400 |
1 | 3 | 1 | 200 <*> | 3 | 3 | 1 | 4600 |
1 | 3 | 2 | 240 <*> | 3 | 3 | 2 | 11000 |
1 | 3 | 3 | 290 <*> | 3 | 3 | 3 | более 11000 |
Примечание: | |||||||
к МУК 4.2.3963-23
Таблица 6.1
Расчет наиболее вероятного числа бактерий в 100 см3 воды
при использовании двухрядовой схемы посева воды <14>
--------------------------------
ИС МЕГАНОРМ: примечание. Текст дан в соответствии с официальным текстом документа. |
- при исследовании других объемов воды, помимо 1; 0,1 и 0,01, соответственно уменьшают или увеличивают НВЧ. Например, при исследовании объемов 10; 1 и 0,1 см3 НВЧ уменьшают в 10 раз; при исследовании объемов 0,1; 0,01 и 0,001 см3 НВЧ увеличивают в 10 раз; при исследовании объемов 0,01; 0,001 и 0,0001 см3 НВЧ увеличивают в 100 раз;
- если при исследовании воды сделан посев более чем трех десятикратных объемов воды или разбавлений, то учитывают 3 такие последовательные объема, в последнем из которых получен один или несколько отрицательных результатов;
- например: 10 см3 - обе пробирки положительны, 1 см3 - аналогично, 0,1 см3 - положительный результат только в одной пробирке, 0,01 см3 - отрицательный результат в обеих пробирках. Учитывают объемы 1; 0,1 и 0,01 см3.
Число положительных объемов | НВЧ бактерий в 100 см3 | ||
двух объемов по 1,0 см3 | двух объемов по 0,1 см3 | двух объемов по 0,01 см3 | |
0 | 0 | 0 | менее 50 |
0 | 0 | 1 | 50 |
0 | 0 | 2 | 90 |
0 | 1 | 0 | 50 |
0 | 1 | 1 | 90 |
0 | 1 | 2 | 140 |
0 | 2 | 0 | 90 |
0 | 2 | 1 | 140 |
0 | 2 | 2 | 190 |
1 | 0 | 0 | 60 |
1 | 0 | 1 | 120 |
1 | 0 | 2 | 190 |
1 | 1 | 0 | 130 |
1 | 1 | 1 | 200 |
1 | 1 | 2 | 280 |
1 | 2 | 0 | 210 |
1 | 2 | 1 | 290 |
1 | 2 | 2 | 370 |
2 | 0 | 0 | 230 |
0 | 0 | 0 | менее 50 |
2 | 0 | 1 | 500 |
2 | 0 | 2 | 950 |
2 | 1 | 0 | 620 |
2 | 1 | 1 | 1300 |
2 | 1 | 2 | 2100 |
2 | 2 | 0 | 2400 |
2 | 2 | 1 | 7000 |
2 | 2 | 2 | более 24 000 |
к МУК 4.2.3963-23
Таблица 7.1
Расчет наиболее вероятного числа (НВЧ) колифагов
в воде в 100 см3
Число положительных результатов | НВЧ в 100 см3 | Вероятность | Нижний предел | Верхний предел | |
из 1 объема по 50 см3 | из 5 объемов по 10 см3 | - | - | - | - |
1 | 4 | 16,1 | 0,4095 | 1,9 | 113,9 |
1 | 3 | 9,3 | 0,3422 | 1,1 | 77,4 |
1 | 2 | 5,6 | 0,3218 | 0,7 | 46,4 |
1 | 1 | 3,2 | 0,3039 | 0,4 | 26,2 |
1 | 0 | 1,4 | 0,2500 | 0,2 | 11,5 |
0 | 5 | 6,9 | 0,0010 | 0,8 | 57,6 |
0 | 4 | 5,1 | 0,0060 | 0,6 | 42,5 |
0 | 3 | 3,6 | 0,0222 | 0,4 | 29,6 |
0 | 2 | 2,2 | 0,0671 | 0,3 | 18,5 |
0 | 1 | 1,1 | 0,1937 | 0,1 | 8,8 |
к МУК 4.2.3963-23
Таблица 8.1
Расчет наиболее вероятного числа бактерий
в 100 см3 питьевой воды
Число положительных результатов из: | НВЧ бактерий в 100 см3 | Доверительный интервал (95%) | |||
3 объемов по 100 см3 | 3 объемов по 10 см3 | 3 объемов по 1 см3 | нижний | верхний | |
1 | 2 | 3 | 4 | 5 | 6 |
0 | 0 | 1 | 0,3 | 0 | 1,4 |
0 | 0 | 2 | - | - | |
0 | 0 | 3 | - | - | |
0 | 1 | 0 | 0,3 | 0,1 | 1,4 |
0 | 1 | 1 | - | - | |
0 | 1 | 2 | - | - | |
0 | 1 | 3 | - | - | |
0 | 2 | 0 | 0,6 | 0,1 | 2,8 |
0 | 2 | 1 | - | - | |
0 | 2 | 2 | - | - | |
0 | 2 | 3 | - | - | |
0 | 3 | 0 | - | - | |
0 | 3 | 1 | - | - | |
0 | 3 | 2 | - | - | |
0 | 3 | 3 | - | - | |
1 | 0 | 0 | 0,4 | 0,1 | 1,7 |
1 | 0 | 0 | 0,7 | 0,2 | 3,4 |
1 | 0 | 2 | - | - | |
1 | 0 | 3 | - | - | |
1 | 1 | 0 | 0,7 | 0,2 | 3,4 |
1 | 1 | 1 | 1,1 | 0,2 | 5,2 |
1 | 1 | 2 | - | - | |
1 | 1 | 3 | - | - | |
1 | 2 | 0 | 1,1 | 0,2 | 5,3 |
1 | 2 | 1 | - | - | |
1 | 2 | 2 | - | - | |
1 | 2 | 3 | - | - | |
1 | 3 | 0 | - | - | |
1 | 3 | 1 | - | - | |
1 | 3 | 2 | - | - | |
1 | 3 | 3 | - | - | |
2 | 0 | 0 | 0,9 | 0,2 | 4,3 |
2 | 0 | 1 | 1,4 | 0,3 | 6,7 |
2 | 0 | 2 | - | - | |
2 | 0 | 3 | - | - | |
2 | 1 | 0 | 1,5 | 0,3 | 6,9 |
2 | 1 | 1 | 2 | 0,4 | 9,6 |
2 | 1 | 2 | - | - | |
2 | 1 | 3 | - | - | |
2 | 2 | 0 | 2 | 0,5 | 9,9 |
2 | 2 | 1 | 3 | 0,6 | 12,9 |
2 | 2 | 2 | - | - | |
2 | 2 | 3 | - | - | |
2 | 3 | 0 | 3 | 0,6 | 13,3 |
2 | 3 | 1 | - | - | |
2 | 3 | 2 | - | - | |
2 | 3 | 3 | - | - | |
3 | 0 | 0 | 2 | 0,5 | 10,8 |
3 | 0 | 1 | 4 | 0,8 | 18,0 |
3 | 0 | 2 | 6 | 1,4 | 29,7 |
3 | 0 | 3 | - | - | |
3 | 1 | 0 | 4 | 0,9 | 20,0 |
3 | 1 | 1 | 8 | 1,6 | 35,0 |
3 | 1 | 2 | 12 | 2,5 | 53,8 |
3 | 1 | 3 | - | - | |
3 | 2 | 0 | 9 | 2,0 | 43,6 |
3 | 2 | 1 | 15 | 3,2 | 69,8 |
3 | 2 | 2 | 21 | 4,6 | 100,3 |
3 | 2 | 3 | 29 | 6,2 | 136,4 |
3 | 3 | 0 | 24 | 5,1 | 112,1 |
3 | 3 | 1 | 46 | 9,3 | 216,0 |
3 | 3 | 2 | 110 | 23,5 | 516,6 |
3 | 3 | 3 | > 240 | - | - |
Примечание: | |||||
Таблица 8.2
Расчет индекса сальмонелл (НВЧ в 1000 см3) при использовании
двухрядовой схемы посева воды <15>
--------------------------------
<15> Примечание: при исследовании других объемов воды, помимо 1 см3, 0,1 см3 и 0,01 см3, соответственно, уменьшают или увеличивают НВЧ сальмонелл.
Число положительных объемов из | НВЧ сальмонелл в 1000 см3 | ||
двух объемов по 1,0 см3 | двух объемов по 0,1 см3 | двух объемов по 0,01 см3 | |
1 | 2 | 3 | 4 |
0 | 0 | 1 | 500 |
0 | 0 | 2 | 900 |
0 | 1 | 0 | 500 |
0 | 1 | 1 | 900 |
0 | 1 | 2 | 1400 |
0 | 2 | 0 | 900 |
0 | 2 | 1 | 1400 |
0 | 2 | 2 | 1900 |
1 | 0 | 0 | 600 |
1 | 0 | 1 | 1200 |
1 | 0 | 2 | 1900 |
1 | 1 | 0 | 1300 |
1 | 1 | 1 | 2000 |
1 | 1 | 2 | 2800 |
1 | 2 | 0 | 2100 |
1 | 2 | 1 | 2900 |
1 | 2 | 2 | 3700 |
2 | 0 | 0 | 2300 |
2 | 0 | 1 | 5000 |
2 | 0 | 2 | 9500 |
2 | 1 | 0 | 6200 |
2 | 1 | 1 | 134000 |
2 | 1 | 2 | 21000 |
2 | 2 | 0 | 24000 |
2 | 2 | 1 | 70000 |
2 | 2 | 2 | более 240000 |
к МУК 4.2.3963-23
Таблица 9.1
Количественный учет сальмонелл в воде поверхностных водоемов
Объемы исследуемой воды | Индекс сальмонелл (КОЕ) в 1 дм3 воды | Доверительные уровни сальмонелл (КОЕ) в 1 дм3 воды | |||
500 см3 | 50 см3 | 5 см3 | 0,5 см3 | ||
+ | - | - | - | 10 | От единичных клеток до 50 |
+ | + | - | - | 100 | От 50 до 250 |
+ | + | + | - | 500 | От 250 до 1000 |
+ | + | + | + | 2000 и более | От 1000 и выше |
к МУК 4.2.3963-23
ВЫДЕЛЕНИЯ И ИДЕНТИФИКАЦИИ САЛЬМОНЕЛЛ

к МУК 4.2.3963-23
1. Метод 1 (с использованием тетраметил-п-фенилендиамина). Мембранный фильтр с выросшими на нем колониями с питательной среды перекладывают на кружок фильтровальной бумаги несколько большего диаметра, чем фильтр, обильно смоченный реактивом для определения оксидазной активности. Реакция считается положительной, если в течение 1 - 4 мин появляется фиолетово-коричневое окрашивание колоний. В случае необходимости дальнейшей идентификации оксидазоотрицательных бактерий, пересев колоний на подтверждающие среды производится непосредственно с мембранного фильтра на кружке фильтровальной бумаги.
ИС МЕГАНОРМ: примечание. В официальном тексте документа, видимо, допущена опечатка: приложение 19 отсутствует. |
2. Метод 2 (с использованием диметил-п-фенилендиамина). Мембранный фильтр с выросшими на нем колониями с питательной среды перекладывают на кружок фильтровальной бумаги несколько большего диаметра, чем фильтр, обильно смоченный реактивом для определения оксидазной активности. При появлении первых признаков положительной реакции (синее окрашивание колоний), но не более, чем через 4 мин, мембранный фильтр переносят обратно на питательную среду. В случае необходимости дальнейшей идентификации оксидазоотрицательных бактерий, пересев колоний на подтверждающие среды целесообразно производить не сразу же после проявления реакции, а после выдерживания на питательной среде свыше 5 мин (см. приложение 19 к настоящим МУК).
3. Метод 3 (с использованием готовых коммерческих реактивов и тест полосок). Полоску фильтровальной бумаги помещают в чистую чашку Петри и смачивают 2 - 3 каплями реактива для оксидазного теста. Бумажные системы промышленного производства (например, ОКСИ-тест) смачивают дистиллированной водой. Подсчитывают колонии, характерные для каждого типа, и по 3 - 4 изолированные колонии платиновой петлей или стеклянной палочкой (металлическая петля из нихрома дает ложноположительную реакцию при работе с реактивом тетраметил-п-фенилендиамином) наносят штрихом на подготовленную фильтровальную бумагу. Реакция считается положительной, если в течение 1 мин появляется сине-фиолетовое окрашивание штриха. При отрицательной реакции цвет в месте нанесения культуры не меняется.
Методом 3 допустимо определение оксидазной активности при росте на фильтрах изолированных колоний или при получении чистых культур после рассева на питательном агаре, поскольку при наложении или соприкосновении колоний колиформных бактерий с оксидазоположительными колониями посторонних бактерий можно получить ложноположительную реакцию и неоправданно отбросить из учета колонии бактерий, являющиеся индикаторами фекального загрязнения. Метод 3 дает ошибку определения при нерепрезентативной субъективной выборке колоний для исследования, в отличие от экспрессных методов (методы 1 и 2), с помощью которых выявляется оксидазная активность одновременно всех выросших колоний.
к МУК 4.2.3963-23
ОКСИДАЗНОЙ АКТИВНОСТИ С РЕАКТИВОМ
ТЕТРАМЕТИЛ-П-ФЕНИЛЕНДИАМИНГИДРОХЛОРИД

Алгоритм экспрессного теста определения
оксидазной активности с реактивом
диметил-п-фенилендиаминдигидрохлорид

к МУК 4.2.3963-23
1. На обезжиренное спиртом предметное стекло наносят петлей 1 каплю дистиллированной воды.
2. Вносят небольшое количество культуры из анализируемой колонии и распределяют по поверхности стекла.
3. Мазок высушивают при комнатной температуре и фиксируют трехкратным проведением через пламя горелки.
4. На препарат накладывают полоску фильтровальной бумаги и на нее наливают карболовый раствор генциана фиолетового на 0,5 - 1 мин, снимают бумагу.
5. Наливают раствор Люголя на 0,5 - 1 мин, сливают раствор Люголя.
6. Стекло промывают в этиловом спирте в течение 0,5 - 1 мин, пока не перестанет отходить краситель.
7. Затем стекло тщательно промывают водой и докрашивают в течение 1 - 2 мин фуксином Циля, разведенным 1:10 дистиллированной водой.
8. После промывания и просушивания препарата мазок микроскопируют: грамотрицательные микроорганизмы имеют розовую окраску; грамположительные микроорганизмы окрашиваются в синий цвет.
Отношение бактерий к окраске по методу Грама можно определять прибором для автоматического окрашивания мазков по Граму.
Можно использовать промышленные наборы для окраски согласно инструкции производителя.
к МУК 4.2.3963-23
ПРЕДСТАВИТЕЛЕЙ ПОРЯДКА ENTEROBACTERALES
Признаки/наименование микроорганизма | Y. enterocolitica | Shigella spp. | Salmonella spp. | Escherichia spp. | Proteus spp. | |
1 | 2 | 3 | 4 | 5 | 6 | 7 |
Рост на универсальном скошенном столбике (УСС) | Окраска столбика среды | Желтый, по уколу черно-бурая полоска | Желтый | Желтый или черный, + газ | Желтый, + газ | Малиновый |
Окраска скошенной поверхности среды | Желтая | Красная | Красная | Желтая | Желтая или малиновая, верх черный | |
Рост на трехсахарном агаре с мочевиной (среде И.С. Олькеницкого) | Окраска столбика среды | Малиновый (через 20 ч Желтый) | Желтый | Желтый или черный, + газ | Желтый, + газ | Малиновый или черный |
Окраска скошенной поверхности среды | Малиновая | Красная | Красная | Желтая | Малиновая | |
Рост на трехсахарном агаре с мочевиной (среде Ресселя I) | Окраска столбика среды | Малиновый со дна пробирки | Желтый/ зеленый | Желтый, + газ | Желтый, + газ | Малиновый, + газ |
Окраска скошенной поверхности среды | Сиреневая | Сиреневая | Сиреневая | Желтый/ зеленый | Сиреневая | |
Рост на трехсахарном агаре с сахарозой и маннитом (среде Ресселя II) | Окраска столбика среды | Желтый, газ | Желтый/ Красный | Желтый, почернение по уколу | Желтый, +/- газ | Желтый/ Красный, почернение по уколу |
Окраска скошенной поверхности среды | Желтая | Желтая | Желтая/ Красная | Желтая/ Красная | Желтая/ Красная | |
Ферментация углеводов | Сахароза | + | - | - | X | X |
Рамноза | - | -/+ | + | +/- | -/+ | |
Раффиноза | - | -/+ | - | X | -/+ | |
Маннит | + | +/- | + | + | -/+ | |
Сорбит | + | -/+ | + | +/- | - | |
Биохимические свойства | Наличие орнитиндекарбоксилазы | + | -/+ | + | X | -/+ |
Утилизация цитрата | - | - | +/- | - | X | |
Дезаминирование фенилаланина | - | - | - | - | + | |
Реакция Фогес-Проскауэра (37 +/- 1) °C | - | - | - | - | -/+ | |
Примечание: "+" - положительная реакция; "-" - отрицательная реакция; "+/-" - большинство культур имеют положительную реакцию, но у некоторых штаммов отрицательная реакция; "-/+" - большинство культур имеют отрицательную реакцию, но у некоторых штаммов положительная реакция; "X" - вариабельные результаты. | ||||||
к МУК 4.2.3963-23
В 100 СМ3 ВОДЫ В ХРОМОГЕННОЙ СРЕДЕ
Признаки наличия или отсутствия колиформных бактерий
и E. coli при использовании хромогенной среды
Наличие/отсутствие показателя | Изменение цвета среды на сине-зеленый (наличие/отсутствие) | Флюоресценция | Индольный тест |
Наличие колиформных бактерий | + | - | - |
Наличие E. coli | + | + | + |
Отсутствие E. coli и колиформных бактерий | Светло-желтый | - |
 |  |  |  |
Контрастное изменение цвета среды - колиформы обнаружены | Цвет среды не изменился - отрицательный результат - колиформы и E. coli отсутствуют | Наличие свечения (флюоресценция) в УФ-свете - E. coli обнаружены | Вишнево-красное кольцо - (положительный тест на индол) - E. coli обнаружены |
Рис. 1. Изменение цвета хромогенной среды при определении
наличия/отсутствия колиформных бактерий и E. coli
в 100 см3 воды
к МУК 4.2.3963-23
ОПРЕДЕЛЕНИЕ ЛИСТЕРИЙ
 | |
Рис. 1. Рост листерий в питательных средах ПБЛ II (А)
и бульоне Фрейзера (Б). Слева направо: помутнение
или почернение среды указывают на рост листерий
| | |
Рис. 2. Рост L. monocytogenes на плотных питательных средах
ПАЛКАМ-агаре (А), ALOA агаре Listeria по Оттавиани и Агости
(Б, В). Бактерии рода Listeria являются грамположительными
тонкими короткими палочками, спор не образуют

Рис. 3. Мазок по Граму L. Monocytogenes

"API Listeria идентификация рода Listeria"
ИС МЕГАНОРМ: примечание. В официальном тексте документа, видимо, допущена опечатка: Федеральный закон "О санитарно-эпидемиологическом благополучии населения" принят 30.03.1999, а не 03.03.1999. |
1. Федеральный закон от 03.03.1999 N 52-ФЗ "О санитарно-эпидемиологическом благополучии населения".
2. Постановление Правительства Российской Федерации от 25.01.2022 N 46 "О лицензировании деятельности в области использования возбудителей инфекционных заболеваний человека и животных (за исключением случая, если указанная деятельность осуществляется в медицинских целях) и генно-инженерно-модифицированных организмов III и IV степеней потенциальной опасности, осуществляемой в замкнутых системах".
3. Постановление Правительства Российской Федерации от 06.01.2015 N 10 "О порядке осуществления производственного контроля качества и безопасности питьевой воды, горячей воды".
4. СанПиН 1.2.3685-21 "Гигиенические нормативы и требования к обеспечению безопасности и (или) безвредности для человека факторов среды обитания".
5. СанПиН 3.3686-21 "Санитарно-эпидемиологические требования по профилактике инфекционных болезней".
6. СанПиН 2.1.3684-21 "Санитарно-эпидемиологические требования к содержанию территорий городских и сельских поселений, к водным объектам, питьевой воде и питьевому водоснабжению населения, атмосферному воздуху, почвам, жилым помещениям, эксплуатации производственных, общественных помещений, организации и проведению санитарно-противоэпидемических (профилактических) мероприятий".
7. СП 2.1.3678-20 "Санитарно-эпидемиологические требования к эксплуатации помещений, зданий, сооружений, оборудования и транспорта, а также условиям деятельности хозяйствующих субъектов, осуществляющих продажу товаров, выполнение работ или оказание услуг".
8. Приказ Роспотребнадзора от 01.12.2017 N 1116 "О совершенствовании системы мониторинга, лабораторной диагностики инфекционных и паразитарных болезней и индикации ПБА в Российской Федерации".
9. МУ 4.2.2723-10 "Лабораторная диагностика сальмонеллезов, обнаружение сальмонелл в пищевых продуктах и объектах окружающей среды".
10. МУ 2.1.4.1057-01 "Организация внутреннего контроля качества санитарно-микробиологических исследований воды".
11. МУК 4.2.2316-08 "Методы контроля бактериологических питательных сред".
12. МУК 4.2.2217-07 "Выявление бактерий Legionella pneumophila в объектах окружающей среды".
13. МУК 4.2.3019-12 "Организация и проведение лабораторных исследований на иерсиниозы на территориальном, региональном и федеральном уровнях".
14. МР 01/15702-8-34 "Микробиологическая диагностика кампилобактериоза".
15. МР N 24ФЦ/513 "Определение колиформных бактерий и E. coli с использованием хромогенных и флюорогенных индикаторных сред производства Merck (Германия)".
16. ПНД Ф 12.15.1-08 "Методические указания по отбору проб для анализа сточных вод". Издание 2015 года.
17. ГОСТ 31942 (ISO 19458) "Вода. Отбор проб для микробиологического анализа".
18. ГОСТ Р 56237 (ИСО 5667-5) "Вода питьевая. Отбор проб на станциях водоподготовки и в трубопроводных распределительных системах".
19. ГОСТ 31955.1 (ISO 9308-1) "Вода питьевая. Обнаружение и количественный учет Escherichia coli и колиформных бактерий. Часть 1. Метод мембранной фильтрации".
20. ГОСТ 24849 "Вода. Методы санитарно-бактериологического анализа для полевых условий".
21. ГОСТ ISO 7218 "Микробиология пищевых продуктов и кормов для животных. Общие требования и рекомендации по микробиологическим исследованиям".
22. ГОСТ 30813 "Вода и водоподготовка. Термины и определения".
23. ГОСТ ISO/IEC 17043 "Оценка соответствия. Основные требования к проведению проверки квалификации".
24. ГОСТ Р 51426 "Корма, комбикорма, комбикормовое сырье. Общее руководство по приготовлению разведений для микробиологических исследований".
25. ГОСТ ISO/IEC 17025 "Общие требования к компетентности испытательных и калибровочных лабораторий".
26. ГОСТ Р ИСО 21748 "Статистические методы. Руководство по использованию оценок повторяемости, воспроизводимости и правильности при оценке неопределенности измерений".
27. ГОСТ Р 59024 "Вода. Общие требования к отбору проб".
28. ГОСТ Р 51232 "Вода питьевая. Общие требования к организации и методам контроля качества".
29. ГОСТ Р ИСО 15882 "Стерилизация медицинской продукции. Химические индикаторы".
30. ГОСТ ISO 11133 "Микробиология пищевых продуктов, кормов для животных и воды. Приготовление, производство, хранение и определение рабочих характеристик питательных сред".
31. ГОСТ ISO/TS 21872-1 "Горизонтальный метод обнаружения потенциально энтеропатогенных Vibrio spp. Часть 1. Обнаружение бактерий Vibrioparahaemolyticus и Vibriocholera".
32. ГОСТ Р 58973 "Оценка соответствия. Правила оформления протоколов испытаний".
33. ГОСТ 34786 "Вода питьевая. Методы определения общего числа микроорганизмов, колиформных бактерий, Escherichia coli, Pseudomonas aeruginosa и энтерококков (с Поправкой)".
34. ГОСТ Р 70152 "Качество воды. Методы внутреннего лабораторного контроля качества проведения микробиологических и паразитологических исследований".